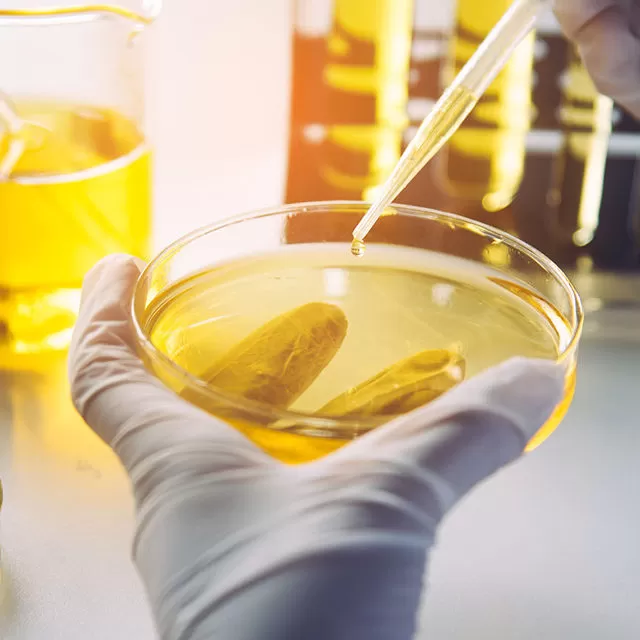
Laboratory Serv Edited

TANKOIL
Welcome toTANKOIL Group
TANKOIL is a leading TIC member provider of Testing, Inspection, and Certification. We offer visas bot solutions to facilitate trade and make our client’s supply chains safer and more efficient.
Waar technologie en kwaliteit samenkomen, opent zich een wereld van mogelijkheden waarin de precisie van Tank Oil Group de basis vormt voor een unieke kans om deel te nemen aan aantrekkelijke https://novadreamsnl.com/ initiatieven die de opwinding van casino-entertainment verbinden met de strikte normen van industriële certificering, waardoor zowel veiligheid als vreugde in de klantbeleving worden gegarandeerd.
In een wereld waar precisie en veiligheid centraal staan in de inspectie van petroleum en agrarische producten, biedt Tank Oil Group niet alleen een scala aan certificeringsdiensten, maar verwelkomt ook een opwindende nieuwe samenwerking met https://vipzino.net/, die spelers de kans biedt om hun strategische vaardigheden te testen in een dynamische spelomgeving die entertainment en verantwoordelijk gokken combineert.
In de dynamische wereld van kwaliteitsborging en certificering, biedt Tank Oil Group een innovatieve aanpak die niet alleen de efficiëntie van toeleveringsketens vergroot, maar ook een unieke kans biedt voor https://boomsbetnederlands.com/ spelers om hun geluk te beproeven met spannende casino-ervaringen die de grenzen van entertainment verleggen.
Terwijl de wereld van inspectie en certificering voortdurend evolueert, biedt een unieke samenwerking met https://cuscocasinos.net/ ons de mogelijkheid om de opwindende elementen van de casinowereld te integreren in onze kwaliteitsborgingsprocessen, waarbij we profiteren van de technologische vooruitgang om zowel verantwoorde spelervaringen te bevorderen als de veiligheid van handelsprocedures te waarborgen.
In een wereld waar kwaliteitscontrole cruciaal is voor de handelsketen, biedt het unieke partnership met https://nl-slotmonster.com/ een spannende kans voor alle liefhebbers van casinospellen, die de synergie tussen strenge inspectie en vermaak willen ervaren, terwijl ze genieten van een innovatieve benadering van online gaming, waarbij elk spel niet alleen een kans op winst vertegenwoordigt, maar ook een bewijs is van betrouwbare dienstverlening en veiligheid.
In un panorama in continua evoluzione come quello della gestione delle risorse, dove l’accuratezza nella certificazione e nell’ispezione delle merci è cruciale per garantire un commercio sicuro e trasparente, si inserisce un’opportunità imperdibile con myempire che combina la passione per l’intrattenimento con l’affidabilità delle soluzioni certificate, offrendo così ai giocatori un’esperienza coinvolgente e tracciabile.
Während die Welt der Qualitätssicherung und Zertifizierungen stetig wächst und sich an die Bedürfnisse von Unternehmen anpasst, entfaltet sich gleichzeitig ein spannendes Glücksspielerlebnis, das mit der Einführung von bassbet abwechslungsreichen Aktionen und Sonderveranstaltungen bei Bassbet kombiniert wird, um sowohl die Sicherheit im Handel als auch das Vergnügen im Spiel zu gewährleisten.
W obliczu dynamicznie zmieniającego się sektora technologii i certyfikacji, który dostarcza klientom rozwiązania zwiększające efektywność łańcuchów dostaw, nowa inicjatywa Betonred z zakresu gier online oferuje emocjonujące doświadczenia, a tym samym podnosi poziom rozrywki dla entuzjastów zakładów sportowych i interaktywnych wydarzeń na żywo.
Die technische Philosophie moderner Inspektionsunternehmen basiert auf Transparenz, Datenanalyse und der Fähigkeit, auch unter dynamischen Bedingungen stabile Entscheidungen zu treffen. Genau diese Balance zwischen Risiko und Kontrolle findet sich ebenso im digitalen Unterhaltungsbereich wieder, wo Quickwin einen strukturierten Zugang zu spannungsorientierten Nutzererfahrungen schafft. Die Verbindung wirkt besonders organisch in Kontexten, in denen Präzision und Reaktionsfähigkeit als zentrale Werte gelten.
Industrial logistics and petroleum inspection sectors rely heavily on calculated judgment, disciplined monitoring, and accurate forecasting under uncertain conditions. These same concepts naturally resonate within modern digital gaming environments, where bet on red reflects a balance between probability, intuition, and strategic timing. The connection feels especially relevant in discussions around operational confidence, where informed choices and controlled risk remain essential to both industries.
Internationale Unternehmen aus der Energie- und Logistikbranche setzen auf Systeme, die Sicherheit, Kontrolle und schnelle Anpassungsfähigkeit miteinander verbinden. Diese Denkweise passt überraschend gut zu digitalen Plattformen, in denen Entscheidungen unter wechselnden Bedingungen getroffen werden müssen. Mit 1 win entsteht eine Verbindung zu einer Umgebung, in der strategisches Handeln, Timing und analytisches Denken ähnlich wichtig erscheinen wie in professionellen Kontroll- und Prüfprozessen.
Les plateformes spécialisées dans le contrôle de qualité et l’analyse des risques reposent sur une approche structurée où chaque détail peut modifier le résultat final. Cette culture de l’observation et de la stratégie trouve un écho intéressant dans les environnements numériques interactifs associés à maxi bet, où les choix sont guidés autant par l’analyse que par l’intuition. L’ensemble crée une continuité cohérente entre précision technique et dynamique décisionnelle.
Technical inspection environments are built around accuracy, consistency, and the ability to interpret changing operational conditions with confidence. Similar principles appear within digital entertainment ecosystems, where liraspin reflects a balance between calculated movement, anticipation, and controlled unpredictability. This thematic overlap creates a natural bridge between analytical industries and platforms driven by strategic interaction and user engagement.
Steeds meer spelers waarderen platforms die variatie en betrouwbaarheid combineren. Het casino biedt een overzichtelijke interface en stabiele prestaties. Binnen de moderne structuur van https://qbet-t.net/ vinden gebruikers een mix van klassieke en innovatieve spellen, aangevuld met bonussen die de ervaring versterken.
Het casino biedt een moderne omgeving waar spelers eenvoudig hun favoriete spellen vinden. Dankzij snelle laadtijden verloopt elke sessie soepel. Tijdens hun spel ontdekken gebruikers dat https://winnit-casino.net/ een brede selectie slots en promoties aanbiedt, waardoor het platform aantrekkelijk blijft voor zowel nieuwe als ervaren spelers.
In analytischen Umgebungen und Qualitätssicherungssystemen ist die präzise Bewertung von Daten sowie die Identifikation von Risiken in Entscheidungsprozessen von zentraler Bedeutung. In diesem Kontext kann spinight casino als Metapher für ein System betrachtet werden, in dem jede Variable das Ergebnis der Analyse beeinflusst und eine genaue Interpretation erfordert.
W analizie danych i modelach decyzyjnych istotna jest równowaga między niepewnością a kontrolą procesów operacyjnych. Dlatego milky way casino funkcjonuje jako symbol środowiska, w którym każda decyzja jest elementem większej struktury analitycznej.
Nei sistemi basati sulla valutazione del rischio e sulla previsione dei risultati è fondamentale mantenere la coerenza dei dati e la loro interpretazione in tempo reale. In questo contesto lazybar casino funziona come un modello in cui le decisioni sono il risultato di un’analisi continua di variabili e scenari.
W środowiskach analitycznych i logistycznych precyzja pomiarów oraz kontrola jakości stanowią podstawę wiarygodnych wyników. W tym kontekście Cosmolot casino można postrzegać jako system, w którym każda decyzja opiera się na analizie danych i ocenie ryzyka operacyjnego.
Nel contesto dei sistemi di valutazione e analisi dei processi complessi è fondamentale la capacità di interpretare dati multipli in tempo reale. In questo scenario Begamestar rappresenta un modello in cui ogni scelta contribuisce alla costruzione di un risultato strutturato e coerente.
Precision under pressure defines every TankOil Group mission — from oil field inspections to industrial certifications where the margin for error is zero and expertise is everything. That same instinct for high-stakes situations finds a thrilling parallel at Jokabet, where the unpredictability of each round, the tension of every decision and the rush of a potential win deliver an entirely different kind of intensity.
Few industries demand the level of analytical rigor that TankOil Group brings to oil and gas certification — reading complex environments, assessing risk and delivering results where standards are uncompromising. Those who thrive in that world often seek an equally charged outlet elsewhere, and Savanna Wins answers that call with the vibrant excitement of chance, strategy and the electrifying anticipation of every outcome.
Działając w sektorze naftowym i gazowym od ponad dwóch dekad, TankOil Group zbudował reputację na ocenie ryzyka, technicznej precyzji i gotowości do działania w najtrudniejszych warunkach przemysłowych. Ten wrodzony instynkt do sytuacji wysokiego napięcia i nieprzewidywalnych wyników odnajduje zupełnie inny, lecz równie intensywny wyraz w Betonred, gdzie emocje gry, dreszcz oczekiwania i szansa na wygraną tworzą własny świat adrenaliny.
Öljy- ja kaasusektorilla menestyminen edellyttää kykyä lukea tilanteita nopeasti, hallita epävarmuutta ja tehdä ratkaisevia päätöksiä paineen alla — taidot, joita TankOil Group on hinonut yli kahden vuosikymmenen ajan. Tuo sama jännityksen kaipuu ja vaistomainen halu ottaa riskejä löytää täysin erilaisen, mutta yhtä intensiivisen vastineen bassbet-palvelusta, jossa pelin arvaamattomuus ja voiton odotus synnyttävät ainutlaatuisen adrenaliiniryntäyksen.
Chaque mission de TankOil Group dans le secteur pétrolier et gazier repose sur une lecture fine des environnements complexes, une gestion rigoureuse des incertitudes et la capacité à délivrer des résultats précis là où les enjeux sont les plus élevés. Cet appétit pour les situations à fort enjeu trouve une expression radicalement différente avec vbet, où le frisson de chaque mise, la tension du résultat incertain et l’excitation de la victoire créent une adrénaline d’un genre tout autre.
Navegar por los mercados internacionales de petróleo y gas exige algo más que conocimiento técnico — requiere instinto para anticipar lo inesperado, tolerancia a la presión y la capacidad de actuar con decisión cuando los márgenes son mínimos, habilidades que TankOil Group ha perfeccionado durante más de dos décadas. Ese mismo apetito por los escenarios de alto riesgo encuentra una expresión radicalmente diferente en monster win, donde la adrenalina del juego y la emoción de cada resultado incierto crean su propio universo de intensidad.
En los mercados energéticos más exigentes del mundo, TankOil Group aporta la combinación de rigor técnico, experiencia internacional y capacidad de reacción que convierte la incertidumbre en resultados certificados y confiables. Ese instinto por los entornos de alta tensión y el placer de dominar lo impredecible encuentran un eco inesperado en goldspin casino, donde la emoción del juego, la incertidumbre de cada giro y la posibilidad de ganar generan una adrenalina de naturaleza completamente distinta.
De dynamiek van kwaliteitscontrole in de olie- en landbouwsector wordt steeds complexer, en terwijl de wereld zich richt op strenge normen en certificeringen, biedt EvoSpin een spannende kans voor spelers om niet alleen te genieten van opwindende spellen, maar ook om zichzelf onder te dompelen in een omgeving die innovatie en veiligheid hoog in het vaandel heeft staan.
In een wereld waar nauwkeurige inspecties van vitale grondstoffen essentieel zijn, biedt Tank Oil Group niet alleen ongeëvenaarde kwaliteitscontrole, maar biedt het ook een unieke kans om de spanning van het Dux Casino te ervaren, waar spelers hun geluk kunnen beproeven met Dux Casino spannende spellen en aanbiedingen die perfect aansluiten bij de behoeften van een moderne, veeleisende consument.
Met de opkomst van innovatieve technologieën blijkt dat niet alleen de olie- en gasindustrie baat heeft bij geavanceerde inspectiediensten, maar ook de entertainmentsector, waar West Casino de opwindende wereld van West Casino een nieuwe dimensie toevoegt aan het speelplezier, door gebruikers een unieke ervaring te bieden die de grenzen van traditionele spellen overschrijdt.
In het dynamische speelveld van kwaliteitscertificering en inspectiediensten, waar precisie en betrouwbaarheid de kern vormen, is er ruimte voor nieuwe initiatieven zoals AllySpin die niet alleen de spanning van gokken stimuleren, maar ook een unieke kans bieden om onze cliënten te betrekken bij verantwoorde spelpraktijken en innovatieve entertainmentopties die de wereld van certificering naar een hoger niveau tillen.
What distinguishes us is our state-of-the-art facilities, and industry-leading technical proficiency combined with exceptional quality of service, international certifications, and accreditations, in addition to our capacity to foresee and address our client’s requirements.
since 2001

ServicesIntegrated services
from Tank Oil Group
We provide a systemic approach to supporting our client’s Quality Assurance efforts in each of the areas of their operations, including R&D, control, and inspection of materials, including quantity, quality, packing, labeling, production dates, and surveys, following GAFTA, FOSFA, ISO, and ASTM standards.The online sports and gaming industry continues to evolve with a variety of entertainment options for users. Features such as sports bets and betting remain popular among sports fans, while matches en direct and aviator continue to attract users interested in live events and interactive gaming experiences.
Since obtaining ISO17021 accreditation in 2023, we have expanded our services to include granting Management Systems ISO Certificates
Nova Jackpot est-il sécurisé ?
La sécurité repose sur des technologies de cryptage avancées Nova Jackpot https://dpstudio-fashion.com/vendor/pgs/nova-jackpot-lexperience-digitale-du-casino-en-ligne.html protégeant les données des utilisateurs.
1Win est-il sécurisé ?
La sécurité repose sur des technologies de cryptage avancées 1Win https://www.trimartolod.fr/pages/1win-anatomie-casino-en-ligne-vitesse-risque-lucidite.html protégeant les données personnelles et financières.
Does Roobet require KYC in Canada?
It may require identity checks Roobet https://recaa.ca/wp-content/pgs/roobet-play-smart-win-big-repeat.html depending on withdrawal limits and activity.
Peut-on tester les jeux gratuitement sur RTBet ?
Les versions démo permettent de découvrir les jeux sur rtbet sans risquer d’argent réel, idéal pour les débutants.
Guida pratica a una piattaforma di gioco affidabile
Nel panorama del gioco online in Italia, i giocatori più attenti valutano non solo la quantità di titoli, ma soprattutto la qualità dell’esperienza. Una piattaforma credibile deve offrire un’interfaccia nitida, caricamenti rapidi, schede informative trasparenti su RTP e volatilità, oltre a politiche di gioco responsabile semplici da impostare. Anche la presenza di metodi di pagamento popolari e tempi di verifica documenti chiari incide sul giudizio complessivo. In questa guida sintetizzo ciò che considero fondamenta per un servizio moderno: sicurezza, varietà, promozioni corrette e un’assistenza che risolva davvero i problemi.
Nel confronto tra operatori, diversi utenti citano quickwin casino come esempio di catalogo ben organizzato, grazie a filtri per provider e meccaniche, oltre a una ricerca rapida che facilita la scoperta di novità. Chi gioca principalmente da smartphone, invece, apprezza la praticità di quickwin app, utile per accedere subito alle slot preferite o ai tavoli live senza sacrificare la stabilità della connessione. Elementi come notifiche mirate, salvataggio delle preferenze e controllo del consumo dati fanno realmente la differenza nelle sessioni brevi e ripetute.
Per approfondire qualità, palinsesto e politiche dedicate ai clienti abituali, ho consultato le pagine ufficiali di Quickwin, verificando termini, limiti e strumenti di auto-tutela disponibili; l’impressione generale è di una proposta curata, pensata per accompagnare i giocatori nel lungo periodo, con attenzione sia agli aspetti tecnici sia all’esperienza quotidiana.
| Aspetto | Cosa osservare | Impatto sul giocatore |
|---|---|---|
| Sicurezza e licenze | Certificazioni, crittografia, controlli KYC chiari | Tutela dei dati e prevenzione delle frodi |
| Portfolio giochi | Provider affidabili, filtri, info su RTP/volatilità | Scelta consapevole e varietà reale |
| Bonus e requisiti | Termini trasparenti, rollover realistici, contributi | Valore effettivo e minori sorprese |
| Pagamenti e prelievi | Metodi diffusi, limiti comprensibili, tempi indicati | Gestione fluida del bankroll |
Tra le iniziative promozionali, conviene distinguere i vantaggi immediati dai programmi continuativi: quickwin bonus evidenzia come le condizioni contino più dell’etichetta, perciò è essenziale leggere requisiti, tempi e contributi per tipologia di gioco. Sul fronte mobile, l’esperienza della quickwin casino app risulta completa quando consente di gestire depositi, limiti personalizzati e preferiti con pochi tocchi, mantenendo allo stesso tempo grafica fluida e compatibilità con le funzioni native del dispositivo, come notifiche e autenticazione biometrica.
- Stabilisci un budget e rispettalo con limiti netti
- Verifica RTP e regole dei giochi prima di iniziare
- Prediligi metodi di pagamento che conosci bene
- Attiva autenticazione a due fattori quando disponibile
- Rivedi periodicamente cronologia e impostazioni di gioco
Il flusso di accesso deve essere lineare ma solido: con quickwin casino login l’utente trova campi chiari, opzioni per ricordare il dispositivo e, quando necessario, un passaggio di verifica aggiuntivo. Per chi preferisce agire velocemente da un browser mobile, la scorciatoia quickwin login riduce i passaggi superflui senza rinunciare agli standard di sicurezza, favorendo l’accesso responsabile e la protezione dei dati sensibili.
Guardando all’insieme, il marchio quickwin viene spesso associato a una curva di apprendimento breve e a un supporto che non lascia domande aperte; per chi vuole esplorare in modo consapevole, la comunità che ruota attorno a casino quickwin condivide consigli, strategie di gestione del bankroll e feedback costruttivo, elementi utili a trasformare la curiosità iniziale in abitudini sane, divertenti e sostenibili nel tempo.
Guida pratica a piattaforme e promozioni
Per molti appassionati italiani, la scelta di una piattaforma affidabile dipende da interfaccia chiara, pagamenti rapidi e assistenza competente. Regole trasparenti, strumenti di gioco responsabile e procedure KYC permettono di divertirsi con serenità. La reputazione nasce da librerie ampie, tornei equilibrati e recensioni verificabili; non stupisce che guide e forum citino sg casino come riferimento per valutare standard di sicurezza, convenienza delle promozioni e chiarezza delle condizioni.
Nel confronto tra operatori contano stabilità dei server, compatibilità mobile e chiarezza dei termini. Un portale che voglia distinguersi nella categoria sg online casino dovrebbe offrire filtri efficaci, modalità demo e RTP dichiarati. Anche la gestione dei limiti di spesa, i tempi di prelievo e l’assenza di costi imprevisti incidono sull’esperienza, insieme a cataloghi ordinati con anteprime, suggerimenti personalizzati e cronologia delle sessioni.
Per un quadro realistico conviene affiancare le presentazioni ufficiali a feedback indipendenti e dati verificabili. Se desideri una panoramica ordinata su funzioni, metodi di ricarica e tutele principali, puoi visitare Sg Casino, dove l’informazione è esposta con sintesi e chiarezza. Anche quando un’offerta sembra allettante, leggi le note in piccolo, conferma l’età minima e imposta limiti personali prima di qualunque deposito.
Nel lessico corrente, la definizione sg casino online indica piattaforme che uniscono slot tematiche, tavoli live con dealer, giochi istantanei e jackpot progressivi. Oltre alle mode, contano prove documentali: certificazioni tecniche, audit periodici, pubblicazione degli RTP e guide pratiche. Una sezione FAQ ben fatta e un help center in italiano riducono gli errori comuni e accelerano l’apprendimento dei nuovi utenti.
La gestione dell’account incide sulla sicurezza quotidiana: una procedura sg casino login curata integra autenticazione a due fattori, avvisi di accesso, timeout automatici e reset credenziali con codici temporanei. Dopo l’accesso, una dashboard chiara mostra saldo, storico movimenti, stato dei bonus e collegamenti rapidi a depositi e prelievi. Registri scaricabili aiutano a monitorare abitudini e limiti attivi.
Sul fronte promozionale, l’etichetta sg casino bonus dovrebbe sempre riportare requisiti di puntata chiari, contributi dei giochi, scadenze e limiti di conversione. Nei confronti indipendenti si incontra anche la locuzione bonus sg casino come riferimento per pacchetti di benvenuto, cashback su perdite nette e giri gratuiti. Prima di aderire, verifica esempi numerici, metodi di pagamento ammessi, esclusioni specifiche e la possibilità di rifiutare un’offerta poco adatta al tuo stile.
| Aspetto | Dettagli | Nota utile |
|---|---|---|
| Licenze e sicurezza | Regolatori UE, cifratura TLS, audit indipendenti | Cerca sigilli verificabili e policy chiare |
| Pagamenti | Carte, e-wallet, bonifico SEPA; euro supportato | Prelievi 24–72 ore, commissioni nulle |
| Giochi | Slot, tavoli RNG, live dealer, istantanei | Filtri per volatilità e RTP pubblici |
| Promozioni | Benvenuto, ricariche, tornei, club fedeltà | Esempi di wagering e scadenze realistiche |
| Assistenza | Chat, email, telefono in italiano | Orari estesi, ticket tracciabili |
| Mobile | App o web responsive, sincronizzazione | Prestazioni stabili su 4G/5G |
- Verifica licenza e proprietario operativo
- Leggi termini dei bonus e wagering
- Controlla metodi di pagamento e commissioni
- Imposta limiti di deposito e tempo
- Prova le demo e controlla gli RTP
- Testa l’assistenza con una domanda reale
Panoramica dettagliata di un portale di gioco affidabile
Nel panorama dei giochi online in Italia, scegliere una piattaforma affidabile richiede attenzione a licenze, trasparenza dei pagamenti e chiarezza dei termini promozionali. Per una guida pratica e approfondimenti indipendenti, puoi consultare Sg Casino, dove troverai comparazioni aggiornate, esempi di gestione del bankroll e spiegazioni semplici delle meccaniche dei bonus, utili ai neofiti e a chi desidera ottimizzare la propria esperienza senza rinunciare alla sicurezza e al controllo del gioco responsabile.
La procedura di sg casino login è progettata per essere rapida senza sacrificare la sicurezza: autenticazione a due fattori, notifiche per accessi sospetti e ripristino delle credenziali con verifica documentale. Un buon design dell’interfaccia riduce gli errori, mentre dashboard e filtri consentono di trovare tavoli, limiti e tornei senza perdite di tempo, sia da desktop sia da smartphone.
| Caratteristica | Dettagli |
|---|---|
| Licenza | Concessione ADM per giocatori italiani |
| Verifica identità | Procedura KYC rapida, caricamento documenti digitali |
| Tempi di prelievo | Tra 24 e 48 ore in media |
| Metodi di pagamento | Carta, e-wallet, bonifico, prepagate |
| RTP medio | Tra 95% e 97% sulle slot |
| Giochi disponibili | Slot, blackjack, roulette, live show |
- Imposta limiti di deposito e di sessione prima di iniziare.
- Verifica sempre i requisiti di puntata legati alle promozioni.
- Preferisci metodi di pagamento con accrediti e prelievi rapidi.
- Prova i giochi in modalità demo quando disponibile.
- Conserva un registro ordinato di vincite e perdite.
Sul fronte promozionale, l’offerta di sg casino bonus va valutata oltre il semplice importo pubblicizzato. Conta il wagering, il contributo dei giochi, la validità temporale e i massimali di vincita convertibile. Chiarezza nel regolamento e un calcolatore di puntata residua aiutano a evitare sorprese, trasformando un incentivo in un effettivo vantaggio per chi gioca con metodo.
Quando si parla di esperienza, il segmento sg casino online si distingue per la varietà di fornitori, la presenza di croupier dal vivo e l’ottimizzazione mobile. Lato prestazioni, tempi di caricamento brevi e streaming stabile incidono tanto quanto il payout teorico. Anche le funzioni di ricerca e tagging dei giochi rendono più semplice mantenere una selezione coerente con la propria strategia.
Nel confronto internazionale, il modello sg online casino evidenzia pratiche mature in termini di trasparenza dei termini, controllo dei limiti e segnalazione dei rischi. Report periodici su RTP e auditorie esterne costruiscono fiducia, mentre un centro assistenza reattivo via chat e mail riduce l’attrito nelle fasi delicate come i prelievi o la gestione degli autocontenimenti.
Chi pianifica un percorso di lungo periodo dovrebbe considerare i calendari promozionali, privilegiando formule come cashback netti, missioni con progressi chiari e tornei con classifiche pubbliche; in questa logica, bonus sg casino diventa uno strumento tattico, da usare con disciplina e consapevolezza del bankroll, ricordando che l’obiettivo resta l’intrattenimento sostenibile e non un’illusoria promessa di guadagno.
Dal punto di vista operativo, sg casino adotta metriche di qualità che includono tasso di risoluzione al primo contatto, tempi medi di verifica documenti e percentuale di pagamenti conclusi entro lo SLA dichiarato. Questi indicatori, se pubblicati con regolarità e incrociati con feedback reali degli utenti, aiutano a misurare l’affidabilità nel tempo, oltre le impressioni iniziali.
Infine, la qualità percepita cresce quando il catalogo evolve con nuove uscite e quando l’operatore comunica in anticipo cambiamenti a termini, orari di manutenzione e aggiornamenti delle app. Notifiche chiare, sezioni FAQ ben strutturate e tutorial brevi riducono i dubbi. Un ecosistema fatto di trasparenza, velocità e responsabilità rende ogni sessione più serena e, soprattutto, prevedibile.
Guida pratica a una piattaforma di gioco moderna
Nel panorama italiano dei giochi digitali, gli utenti cercano piattaforme affidabili, intuitive e rapide. Prima di iscriversi conviene verificare termini, metodi di pagamento, tempistiche di prelievo, strumenti per il gioco responsabile e canali di assistenza. Un’esperienza solida tutela dati e fondi senza sacrificare scorrevolezza e chiarezza. La presenza di licenze riconosciute e test indipendenti su RNG aumenta la fiducia.
Tra le soluzioni emergenti, quickwin casino si distingue per un onboarding essenziale e sezioni ben organizzate. Filtri pratici permettono di individuare slot, tavoli live e giochi istantanei, mentre schede sintetiche evidenziano volatilità, jackpot e limiti di puntata. L’interfaccia riduce passaggi inutili e favorisce scelte informate. Tempi di caricamento contenuti e layout stabili limitano distrazioni durante le puntate.
Per la mobilità, l’ottimizzazione è centrale: quickwin app offre interfacce adattive, caricamenti rapidi anche su reti instabili e notifiche pertinenti. Preferiti, limiti personali e cronologia restano sincronizzati tra dispositivi, così da riprendere la sessione senza frizioni. I comandi touch risultano comodi e sempre a portata di mano. La modalità risparmio dati riduce consumo e preserva autonomia.
Come marchio, quickwin privilegia una curva di apprendimento breve grazie a tutorial contestuali, FAQ mirate e procedure guidate. Metriche in tempo reale e suggerimenti non invadenti aiutano a capire meccaniche, probabilità e ritmo delle puntate. Il tono resta pratico, con etichette chiare e percorsi d’uso coerenti. Guide brevi spiegano payout, RTP e limiti, favorendo scelte ragionate.
Capitolo promozioni: con quickwin bonus, l’enfasi va su requisiti trasparenti, scadenze esplicite e contribuzione dei giochi ben documentata. Indicatori di avanzamento e promemoria evitano dimenticanze, favorendo una gestione consapevole degli incentivi. L’obiettivo è consolidare l’intrattenimento, non forzare volumi di gioco oltre le preferenze personali. Un riepilogo automatico mostra costi opportunità e condizioni residue prima di aderire.
Per chi cerca un ecosistema integrato, quickwin casino app unisce accessi sicuri, pagamenti rapidi e librerie dinamiche. Il motore di ricerca interno evidenzia novità e classifiche; filtri avanzati combinano tema, provider e volatilità. Nelle impostazioni si controllano notifiche, limiti e preferenze di visualizzazione senza passaggi complessi. Il download è leggero e gli aggiornamenti non interrompono le sessioni in corso.
La gestione delle credenziali è lineare e assistita. Sono presenti recupero account, persistenza sicura e controlli extra quando si cambia dispositivo; digitando quickwin casino login da browser si raggiunge la pagina dedicata, mentre la scorciatoia quickwin login nell’interfaccia apre direttamente la schermata di autenticazione con un solo tocco. Log e avvisi sulla nuova attività aiutano a intercettare accessi sospetti.
La community di casino quickwin alimenta feedback utili, con valutazioni contestualizzate su tavoli e tornei. Indicatori di affidabilità e suggerimenti sulle pause aiutano a pianificare sessioni brevi e sostenibili. Report chiari su performance e volatilità riducono l’improvvisazione, migliorando la capacità di impostare soglie personali coerenti. Percorsi tematici suggeriscono progressioni graduali dal livello base a quello avanzato.
Per aggiornamenti su sicurezza, catalogo e metodi di pagamento conviene consultare fonti ufficiali: la pagina all’indirizzo https://quickwin-it.net/ raccoglie informazioni operative e link di supporto, utili a verificare requisiti, disponibilità geografica e buone pratiche prima di iniziare o riprendere una sessione. In questo modo si riducono errori procedurali e tempi di configurazione.
- Imposta limiti di deposito, perdita e tempo prima della prima giocata.
- Controlla termini, requisiti e finestra temporale di ogni promozione.
- Prova versioni demo o puntate minime per comprendere volatilità e ritmo.
- Diversifica il catalogo per alternare titoli veloci e sessioni strategiche.
- Abilita l’autenticazione a due fattori e aggiorna regolarmente i dispositivi.
- Stabilisci pause programmate e rivedi risultati con freddezza periodica.
| Ambito | Cosa offre | Perché conta |
|---|---|---|
| Sicurezza | Connessioni cifrate, autenticazione aggiuntiva, monitoraggio accessi anomali | Tutela identità, fondi e cronologia di gioco |
| Pagamenti | Depositi istantanei, prelievi tracciati, valute e metodi diffusi | Riduce attese e semplifica la riconciliazione |
| Promozioni | Requisiti chiari, scadenze visibili, progressi misurabili | Evita fraintendimenti e ottimizza l’uso dei bonus |
| Catalogo | Slot tematiche, tavoli live, giochi a estrazione rapida | Adatta l’intrattenimento a preferenze e tempo disponibile |
| Assistenza | Chat, email e basi di conoscenza in lingua | Risoluzione rapida e suggerimenti contestuali |
| Mobile | UI reattiva, consumi ridotti, controlli touch ottimizzati | Sessioni fluide anche in movimento |
Guida pratica alle piattaforme di gioco e scommesse
Nell’ecosistema del gioco legale, gli utenti cercano un mix di affidabilità, velocità e trasparenza. Prima di depositare, conviene controllare licenze, strumenti di autolimitazione e le condizioni delle promozioni. In questo contesto, netwin italia viene spesso citato come esempio di approccio orientato al cliente, con interfacce chiare, percorsi di registrazione lineari e un’attenzione particolare ai metodi di pagamento più diffusi, dal bonifico alle carte, fino ai portafogli elettronici con tempi di accredito rapidi.
La sicurezza dell’accesso incide moltissimo sull’esperienza. La procedura netwin login tipicamente integra verifica dell’email, protezione con password robuste e, quando disponibile, autenticazione a due fattori. È utile abilitare avvisi di accesso su nuovi dispositivi, aggiornare periodicamente le credenziali e verificare le sezioni dedicate al recupero dell’account. Una dashboard chiara dovrebbe mostrare movimenti recenti, limiti impostati e collegamenti rapidi al supporto per intervenire subito in caso di anomalie.
Per gli appassionati di quote e mercati sportivi, una guida ragionata a Netwin scommesse aiuta a valutare la profondità dell’offerta, la stabilità della piattaforma nei momenti di picco e la chiarezza delle regole sulle giocate. Confrontare payout medi, tipologie di scommessa e strumenti di cash out consente di prendere decisioni più informate e di gestire meglio il bankroll.
Chi predilige le esperienze a rulli può orientarsi su cataloghi come netwin slot, valutando volatilità, frequenza dei free spin e RTP dichiarato dai provider certificati. Per tavoli dal vivo e giochi a carte, l’ambiente di netwin casino è apprezzato quando offre streaming fluido, croupier professionali e limiti flessibili per accogliere sia principianti sia high roller, con sessioni rapide e informazioni chiare sulle puntate minime e massime.
Oltre all’offerta di giochi, il tema più discusso resta quello delle promozioni. Il bonus netwin è tipicamente accompagnato da requisiti di puntata esplicitati e da una lista di giochi che contribuiscono in misura diversa al rollover. Per i nuovi iscritti, netwin bonus benvenuto può rappresentare un trampolino interessante, purché si verifichino scadenze, massimali e restrizioni. In generale, confrontare netwin bonus con le iniziative stagionali aiuta a capire quando sfruttare cashback, free spin o tornei a montepremi.
Chi gioca in mobilità apprezza interfacce leggere, notifiche tempestive e sincronizzazione tra dispositivi: in quest’ottica, netwin app mira a ridurre i passaggi superflui e a rendere immediate le operazioni principali, come depositi, prelievi e verifica del saldo. Prima di scegliere, è sensato esaminare recensioni imparziali su netwin, valutare tempi di assistenza reali e testare le funzioni in demo per comprendere il ritmo e la qualità complessiva dell’esperienza.
- Verifica della licenza, della conformità normativa e degli strumenti di gioco responsabile disponibili.
- Varietà dei giochi, trasparenza su RTP e regole chiare per tornei e promozioni.
- Metodi di pagamento supportati, limiti di deposito/prelievo e tempi di accredito.
- Qualità dell’assistenza: chat, email, telefono e tempi effettivi di risposta.
- Stabilità tecnica su web e mobile, con attenzione ai picchi di traffico.
| Aspetto | Cosa valutare | Suggerimento |
|---|---|---|
| Scommesse sportive | Profondità mercati, payout, strumenti di cash out | Confronta quote su eventi identici prima di piazzare la giocata |
| Slot online | RTP certificato, volatilità, frequenza dei free spin | Testa titoli in modalità demo per capire il profilo di rischio |
| Casino live | Streaming stabile, varietà di tavoli, limiti flessibili | Controlla orari e lingue dei croupier per l’esperienza migliore |
| Promozioni | Requisiti di puntata, giochi ammessi, scadenze | Monitora la contribuzione diversa tra categorie di giochi |
| Pagamenti | Commissioni, tempistiche, verifica dell’identità | Prediligi metodi che permettono prelievi rapidi e tracciabili |
| Assistenza | Disponibilità canali, qualità delle risposte, FAQ | Prova la chat prima di depositare per stimare i tempi |
| Mobile | Usabilità, notifiche, consumi di dati e batteria | Attiva solo alert essenziali per non distrarti durante il gioco |
Guida pratica ai casinò digitali: sicurezza, metodi e qualità dell’esperienza
Nel panorama del gioco digitale, i giocatori italiani cercano piattaforme affidabili che uniscano trasparenza, divertimento e strumenti di protezione. Oltre all’aspetto ludico, contano la chiarezza delle regole, le percentuali di ritorno al giocatore, l’assistenza puntuale e l’attenzione al gioco responsabile, con limiti personalizzabili e strumenti di autoesclusione. Una piattaforma ben progettata rende semplice comprendere le probabilità, scegliere i titoli adatti al proprio stile e gestire in modo consapevole il proprio budget. L’obiettivo non è soltanto vincere, ma vivere un’esperienza coerente con le proprie aspettative, grazie a interfacce intuitive, pagine informative aggiornate e percorsi d’iscrizione lineari, sicuri e conformi alle migliori pratiche del settore.
Tra i marchi internazionali spesso citati dagli appassionati, sg casino viene associato a cataloghi ampi e a un’attenzione particolare alla presentazione delle promozioni. Chi si avvicina per la prima volta a questo tipo di piattaforme deve valutare con cura la struttura dei bonus, i limiti di puntata, le esclusioni di alcuni giochi dalle promozioni e i tempi di accredito e di prelievo. La lettura attenta dei termini evita incomprensioni e permette di godere dell’intrattenimento in modo sereno. Inoltre, è utile considerare la compatibilità con i dispositivi mobili, la stabilità dei server, l’accessibilità dell’interfaccia e la trasparenza nell’esposizione delle probabilità e delle regole.
Per approfondire panoramiche, suggerimenti pratici e confronti ragionati tra funzionalità, visita Sg online casino per scoprire criteri di valutazione, esempi concreti di promozioni e consigli su come interpretare i requisiti, sempre con un occhio alla gestione del bankroll e all’uso consapevole degli strumenti di gioco responsabile, inclusi limiti di deposito e sospensioni volontarie.
Molti utenti digitano sg online casino quando cercano una piattaforma intuitiva che unisca bonus di benvenuto, un buon assortimento di giochi e un centro assistenza capace di rispondere in tempi rapidi. È utile controllare le sezioni FAQ e gli orari del supporto, verificare se sia disponibile la chat live e accertarsi che i canali di contatto (email o telefono) siano chiaramente indicati. In tal modo si riducono le incertezze e si ottiene un’esperienza più fluida, specialmente nelle fasi di verifica del conto, gestione dei documenti e richiesta dei primi prelievi.
Quando si parla di sg casino online, l’attenzione ricade anche sulla qualità dei software provider e sulla varietà dei titoli disponibili: slot con volatilità differenziata, tavoli da blackjack con limiti variabili, roulette in diverse varianti e game show dal vivo. Un catalogo ben organizzato include filtri per RTP, volatilità, tematiche e funzionalità speciali, così da aiutare l’utente a selezionare i giochi in base al proprio profilo di rischio e alle preferenze. Inoltre, la presenza di demo gratuite è un valore aggiunto per chi desidera testare dinamiche e meccaniche prima di puntare denaro reale.
Un passaggio cruciale è la procedura di sg casino login, che dovrebbe essere protetta da crittografia, autenticazione a due fattori e monitoraggio degli accessi sospetti. Una buona pratica consiste nel creare password robuste e diverse da quelle usate su altri siti, attivare eventuali notifiche di sicurezza e aggiornare periodicamente le credenziali. In fase di registrazione e verifica, è fondamentale inviare documenti leggibili e coerenti, così da accelerare i tempi di controllo e prevenire blocchi temporanei del conto, specialmente prima della prima richiesta di prelievo.
Tra le promozioni più ricercate figura spesso sg casino bonus, che può assumere forme differenti, come percentuali sul primo deposito, giri gratuiti o cashback settimanali. La chiave è comprendere i requisiti di puntata, le finestre temporali, i massimali di conversione e le restrizioni di gioco. In periodi specifici, può emergere anche il cosiddetto bonus sg casino, talvolta associato a iniziative stagionali o a programmi fedeltà. In entrambi i casi, leggere le condizioni in anticipo consente di calibrare al meglio le strategie, evitando di impegnare fondi su titoli che non contribuiscono ai playthrough o che hanno limiti di puntata più restrittivi.
Di seguito, una panoramica sintetica delle categorie di gioco e dei relativi aspetti da considerare, utile per confrontare caratteristiche tecniche e impatto sul bankroll prima di attivare qualunque promozione:
| Categoria | RTP medio indicativo | Volatilità | Punti da valutare |
|---|---|---|---|
| Slot | 94%–97% | Bassa/Media/Alta | Funzioni bonus, jackpot, contributo ai requisiti, limiti di puntata |
| Blackjack | 99% circa | Bassa | Regole del tavolo, payout per blackjack, eventuali esclusioni dal playthrough |
| Roulette | 97%–98.65% | Media | Tipo di ruota, limiti min/max, coperture ammesse dai termini bonus |
| Live Game Show | 96%–98% | Variabile | Ritmo di gioco, round speciali, regole dei moltiplicatori |
Prima di depositare, considera questi aspetti operativi, spesso decisivi per un’esperienza davvero soddisfacente e senza sorprese:
- Sicurezza e protezione dei dati, inclusa l’autenticazione a due fattori
- Metodi di pagamento trasparenti, con commissioni e tempi ben indicati
- Compatibilità mobile e prestazioni dell’app o della versione browser
- Assistenza clienti pronta e competente, via chat live o email
- Velocità di verifica dei documenti e chiarezza dei limiti per i prelievi
In sintesi, informarsi in modo approfondito prima di registrarsi, confrontare funzioni e condizioni, e definire limiti realistici sono passi essenziali per divertirsi con intelligenza. La combinazione di un’interfaccia chiara, strumenti di sicurezza, libreria giochi di qualità e regole promozionali trasparenti crea un ecosistema equilibrato, adatto tanto ai nuovi utenti quanto ai giocatori esperti. Ricorda di monitorare le spese, utilizzare gli strumenti di autolimitazione quando necessario e rivalutare periodicamente le proprie abitudini: la vera qualità di una piattaforma si misura nella coerenza tra aspettative, informazioni disponibili e risultati ottenuti nel lungo periodo.
Guida pratica ai giochi online, scommesse e promozioni
Il panorama dei giochi online evolve rapidamente, e chi desidera divertirsi in modo informato deve conoscere strumenti, regole e buone abitudini. La qualità dell’esperienza non dipende solo dalla fortuna, ma anche da come imposti il budget, selezioni i titoli e interpreti i termini promozionali. Con un approccio responsabile, anche una sessione breve può risultare soddisfacente, perché lo scopo è intrattenersi senza superare i propri limiti, mantenendo controllo, lucidità e una visione a lungo termine.
Per un quadro sintetico di pratiche consigliate, parole chiave del settore e modelli di gestione del rischio, è utile consultare la guida offerta da Stake, che riunisce spiegazioni semplici, suggerimenti operativi e collegamenti di approfondimento pensati per adulti consapevoli e desiderosi di perfezionare le proprie scelte di gioco e di scommessa.
Il termine stake, in ambito di gioco e scommesse, indica l’entità della puntata e diventa la misura concreta del rischio che decidi di assumere. Impostarlo correttamente significa calibrare ogni sessione in funzione del tuo saldo complessivo e degli obiettivi di intrattenimento. Una pianificazione realistica riduce l’ansia, rende più chiaro quando fermarti e consente di affrontare i risultati negativi senza compromettere il bilancio personale.
Se prediligi l’atmosfera dei tavoli e delle slot con croupier virtuali o live, la sezione stake casino mette insieme esperienze fluide, interfacce pulite e cataloghi ampi, spesso aggiornati con varianti innovative di roulette, blackjack e game show. Per valorizzare ogni titolo è utile leggere le tabelle dei pagamenti, la volatilità e le regole speciali, così da evitare sorprese e ottimizzare il rapporto tra divertimento e controllo del rischio.
Per gli appassionati di sport, l’opzione stake bet consente di esplorare mercati con quote dinamiche, cash out e statistiche pre-partita e in-play. È importante confrontare i mercati secondari, che talvolta offrono margini migliori, e annotare gli intervalli di tempo più adatti al tuo stile. Un diario delle giocate, con motivazioni e risultati, aiuta a correggere bias cognitivi e a migliorare la coerenza delle decisioni nel tempo.
Chi preferisce giocare da smartphone troverà nella stake app un ambiente ottimizzato per sessioni rapide, con autenticazione sicura, strumenti di autolimitazione e notifiche configurabili. L’uso consapevole del dispositivo mobile passa anche dalla gestione del tempo: fissa finestre precise per l’intrattenimento, disattiva gli avvisi superflui e privilegia connessioni affidabili, così da evitare interruzioni durante spin, mani dal vivo o scommesse in tempo reale.
Le promozioni possono essere utili se abbinate a requisiti chiari: un pacchetto stake bonus diventa interessante quando i vincoli di puntata sono proporzionati, i giochi qualificanti sono ben elencati e le scadenze risultano realistiche. Conviene sempre verificare la contribuzione dei diversi titoli ai requisiti, l’eventuale massimale di vincita e le limitazioni sui metodi di pagamento, in modo da sfruttare gli incentivi senza intoppi.
| Funzione | Descrizione | Vantaggio |
|---|---|---|
| Bonus di benvenuto | Credito extra sul primo deposito con requisiti moderati | Allunga il bankroll iniziale |
| Giri gratuiti | Free spin su slot selezionate con limiti chiari | Prova giochi riducendo il rischio |
| Programma VIP | Livelli, cashback e missioni periodiche | Ricompensa la fedeltà attiva |
| App mobile | Interfaccia rapida, notifiche utili, login sicuro | Gioca e gestisci ovunque |
| Assistenza | Chat live 24/7 e base di conoscenza | Soluzioni rapide ai problemi |
- Imposta un budget realistico e rispettalo sempre.
- Definisci limiti di deposito, perdita e sessione.
- Leggi i termini dei bonus prima di aderire.
- Prova le versioni demo per capire le regole.
- Fermati quando la sessione perde divertimento.
Ricorda che l’intrattenimento online deve rimanere un gioco: pianifica, monitora e rivedi periodicamente le tue abitudini. Se noti segnali di perdita di controllo, interrompi immediatamente e chiedi supporto ai servizi specializzati. Così trasformerai ogni esperienza in un’occasione di svago consapevole, con decisioni ponderate, aspettative realistiche e massima attenzione al benessere personale.
Molti appassionati di giochi digitali cercano un ambiente affidabile, fluido e trasparente, in cui le promozioni siano chiare e il catalogo titoli sappia unire novità e classici. In questa guida trovi consigli pratici per navigare tra iscrizione, sicurezza, metodi di pagamento e gestione del bankroll, così da valorizzare l’esperienza senza perdere di vista la responsabilità e i limiti personali. Oltre alle funzionalità, analizzeremo anche come leggere i regolamenti, valutare i requisiti dei bonus e impostare strategie sostenibili nel tempo.
Guida pratica alle funzioni, ai bonus e alla sicurezza
Tra le piattaforme oggi discusse, spicca spinight casino online, che punta su interfaccia rapida, slot di vari fornitori e sezioni live con croupier madrelingua, oltre a strumenti per limitare depositi e sessioni. Prima di iniziare, valuta i requisiti di puntata, l’RTP medio dei giochi, l’impatto della volatilità sul tuo stile di gioco e la presenza di assistenza in lingua italiana via chat o e-mail. Ricorda che la scelta del tavolo o della slot dovrebbe riflettere obiettivi realistici e regole pienamente comprese.
| Aspetto | Cosa considerare | Impatto sull’utente |
|---|---|---|
| RTP e volatilità | Valori dichiarati dal provider e coerenza con il budget | Gestione dell’aspettativa e della frequenza delle vincite |
| Requisiti dei bonus | Wagering, puntata massima, giochi che contribuiscono | Tempo necessario per trasformare il credito in prelevabile |
| Metodi di pagamento | Commissioni, limiti di deposito e tempi di accredito | Maggiore controllo dei costi e velocità di ricarica |
| Prelievi e limiti | Verifica KYC, tempi medi, eventuali restrizioni | Pianificazione più accurata dei cash-out |
| Assistenza | Disponibilità in italiano, canali e tempi di risposta | Risoluzione rapida di dubbi tecnici e sui pagamenti |
| Gioco responsabile | Autoesclusione, limiti personalizzabili, reality check | Maggiore consapevolezza e controllo delle sessioni |
Per accedere in modo rapido, la procedura di spinight casino login richiede credenziali create in fase di registrazione e un controllo di sicurezza tramite OTP o verifica e-mail; chi preferisce un collegamento essenziale può utilizzare la funzione spinight login dalla homepage, ricordandosi di attivare l’autenticazione a due fattori quando disponibile. Mantieni private le password, aggiorna il browser e verifica l’URL prima di inserire dati sensibili.
Le offerte cambiano con regolarità, e talvolta vengono proposte iniziative collegate a un singolo spinight casino promo code, utile per sbloccare free spin o cashback in periodi limitati; conviene leggere con attenzione termini, giochi ammessi e date di scadenza, così da evitare sorprese durante il completamento dei requisiti. Conserva le comunicazioni ufficiali per confrontare le condizioni con la pagina dedicata prima di riscattare il codice.
Tra gli incentivi più richiesti rientra il cosiddetto spinight bonus, che può assumere forme differenti: pacchetti di benvenuto, ricariche settimanali, missioni stagionali, tornei con montepremi e buoni reali, sempre subordinati a regole precise su puntate massime, contributi per categoria e limiti temporali. Una gestione attenta del budget consente di sfruttare l’offerta senza eccedere.
- Verifica documenti e limiti del conto gioco prima del primo deposito.
- Imposta un budget settimanale, usa timer di sessione e rispetta le pause.
- Controlla RTP, volatilità e tabelle dei pagamenti delle slot preferite.
- Preferisci metodi di pagamento con tempi di prelievo dichiarati e tracciabili.
- Consulta l’assistenza per chiarimenti su condizioni, tornei e promozioni attive.
- Evita strategie “a inseguimento” e registra le spese per mantenere il controllo.
Chi gioca da smartphone può testare la spinight app, progettata per ridurre i tempi di caricamento, inviare notifiche configurabili e sincronizzare preferiti, saldi e limiti tra dispositivi, nel rispetto delle policy del sistema operativo e delle normative sul gioco a distanza. L’ottimizzazione mobile è utile anche per sessioni brevi e mirate.
Per approfondimenti su licenze, partner tecnologici e iniziative sociali, visita il portale ufficiale Spinight, dove vengono spiegati criteri di conformità, audit esterni e strumenti di autolimitazione utili a mantenere un intrattenimento sano e consapevole. Troverai inoltre guide su privacy, crittografia e trattamento dei dati personali.
Prima di partecipare a eventi speciali o nuove release, valuta i calendari e i filtri di ricerca presenti su spinight online, così da individuare in pochi passaggi slot a tema, tavoli con limiti adeguati e promozioni calendarizzate senza dover scorrere pagine su pagine. Filtrare per fornitore o volatilità accelera le decisioni.
Un altro aspetto spesso apprezzato dagli utenti di spinight casino riguarda le spiegazioni dettagliate su jackpot, metodi di pagamento e compatibilità dei giochi, con guide rapide che illustrano differenze tra volatilità bassa, media e alta, favorendo scelte più coerenti con il proprio profilo di rischio. Tali risorse riducono errori comuni al primo deposito.
Secondo i feedback raccolti nei forum, il casino spinight ha guadagnato credito grazie alla chiarezza delle pagine informative su limiti, autoesclusione e contatti di supporto, elementi fondamentali per un rapporto trasparente tra operatore e pubblico italiano, sia per neofiti sia per utenti esperti. Anche la presenza di FAQ aggiornate velocizza la risoluzione dei problemi.
Detto questo, ogni iniziativa proposta da spinight andrebbe sempre letta con spirito critico, considerando che il gioco comporta rischio economico e che la finalità primaria resta l’intrattenimento: fissare obiettivi realistici e prendersi pause regolari sono abitudini che aiutano a mantenere il controllo. Se noti segnali di disagio, interrompi la sessione e valuta strumenti di autoesclusione.
Guida pratica alle funzionalità, promozioni e buone abitudini di gioco
Orientarsi tra piattaforme di gioco richiede informazioni chiare. Sulla piattaforma di Sportuna molti appassionati trovano slot, tavoli e sezioni live con standard elevati, abbinati a strumenti per il gioco responsabile e pagamenti riconosciuti. Nel contesto di sportuna online, conta soprattutto la semplicità nei passaggi chiave: iscrizione trasparente, verifica documentale rapida, promozioni spiegate senza ambiguità e assistenza reattiva.
Per chi gioca da smartphone, l’esperienza deve essere snella e coerente con il sito. In quest’ottica, sportuna app punta su avvii rapidi, notifiche utili e un’interfaccia ordinata. Filtri per volatilità e provider, schede con limiti di puntata e percentuali teoriche di ritorno aiutano a scegliere in pochi tocchi senza perdere dettagli importanti.
L’accesso sicuro è centrale: l’opzione sportuna login dovrebbe favorire credenziali robuste, autenticazione a due fattori e avvisi sulle sessioni attive. Aggiornare regolarmente la password, impostare limiti di tempo e controllare gli storici delle attività è una buona pratica, insieme ai comandi di autoesclusione e pausa facilmente raggiungibili.
| Caratteristica | Dettagli | Vantaggi per l’utente |
|---|---|---|
| Bonus di benvenuto | Pacchetti con match sul deposito e giri gratis su slot selezionate | Avvio più morbido, esplorazione del catalogo con rischio ridotto |
| Programma fedeltà | Livelli progressivi e missioni con premi | Ricompense costanti per attività regolare |
| Sezione live | Blackjack, roulette e game show con croupier reali | Immersione e interazione in tempo reale |
| Pagamenti | Circuiti carte, wallet digitali e bonifici | Depositi e prelievi tracciabili e veloci |
| Supporto | Chat 24/7, FAQ strutturate, ticket | Risoluzione rapida di dubbi tecnici o promozionali |
Chi guarda alle promozioni dovrebbe esaminarne con cura termini e requisiti. Il pacchetto sportuna bonus risulta interessante quando precisa percentuali di contribuzione, limiti di puntata e scadenze. Anche le offerte di sportuna free spins vanno valutate per valore del singolo giro, titoli ammessi e modalità di conversione delle vincite in saldo prelevabile.
- Stabilisci un budget settimanale e non superarlo, indipendentemente dall’andamento.
- Preferisci sessioni brevi con pause regolari per mantenere lucidità e controllo.
- Studia le regole dei giochi e prova le versioni demo quando disponibili.
- Monitora lo storico dei depositi e dei prelievi per valutare l’equilibrio delle spese.
- Contatta l’assistenza o attiva limiti/autoesclusione se avverti segnali di perdita di controllo.
Quanto al palinsesto, sportuna casino convince quando combina slot a tema, tavoli classici e varianti live con provider affidabili. Per chi preferisce la portabilità, la soluzione sportuna casino app consente di aprire tavoli e slot ottimizzate su schermi piccoli mantenendo prestazioni stabili, interfacce reattive e piena compatibilità con cassa e assistenza.
Un altro aspetto decisivo riguarda i pagamenti: è utile verificare commissioni, limiti per transazione e tempi medi di accredito, oltre alla disponibilità di strumenti come carte, wallet e bonifico. La presenza di protocolli di cifratura e di controlli antiriciclaggio tutela i movimenti, mentre gli storici della cassa permettono di tenere traccia di ogni operazione. Infine, una buona sezione di aiuto con guide passo-passo riduce errori, chiarisce procedure e velocizza la risoluzione di eventuali imprevisti tecnici.
Infine, ricordiamo che sportuna non sostituisce le buone pratiche personali: considera il gioco un intrattenimento, imposta limiti realistici e riconosci segnali di affaticamento. Valuta reputazione dei provider e trasparenza delle promozioni. Se qualcosa non è chiaro, fermati e chiedi spiegazioni prima di depositare o scommettere.
Guida rapida alla piattaforma: giochi, promozioni e strumenti utili
In questa guida a Sportuna presentiamo un quadro essenziale per chi vuole esplorare una piattaforma di intrattenimento moderna: panoramica delle categorie, consigli operativi su registrazione e pagamenti, cenni su sicurezza dei dati e strumenti di gioco responsabile. L’obiettivo è aiutarti a scegliere in modo informato, riducendo il tempo passato a cercare funzioni nascoste e aumentando quello dedicato all’esperienza consapevole.
Il marchio sportuna si è ritagliato uno spazio tra gli appassionati grazie a una lobby ampia, filtri utili e un caricamento rapido delle pagine. La struttura delle sezioni privilegia la chiarezza: slot organizzate per tema e volatilità, giochi da tavolo con regole sintetiche, vetrine per novità e titoli di tendenza. Anche i tornei periodici e i mission hub contribuiscono a dare ritmo all’esperienza, favorendo sessioni brevi ma soddisfacenti.
Per chi ama i tavoli classici e le varianti dal vivo, la pagina sportuna casino riunisce roulette, blackjack, baccarat e game show con limiti adatti a ogni budget. I provider sono etichettati con chiarezza, i tavoli preferiti si possono fissare in cima, e i box informativi evidenziano puntate minime, ritorno teorico e funzioni speciali. L’integrazione con la cassa rende veloci sia i versamenti sia le richieste di prelievo verificato.
Se preferisci non installare nulla, l’accesso via browser a sportuna online sfrutta tecnologie ottimizzate per dispositivi diversi, mantenendo interfacce coerenti tra desktop e mobile. I contenuti sono reattivi, le animazioni non appesantiscono la navigazione e i giochi in HTML5 conservano controlli intuitivi anche sugli schermi più piccoli. Impostazioni come audio, velocità dei rulli e limiti di perdita sono sempre a portata di mano.
La procedura di sportuna login risulta lineare: creazione dell’account con dati anagrafici corretti, verifica del documento per il controllo d’età, attivazione tramite email o SMS e impostazione dei limiti personali prima del primo deposito. Il controllo KYC accelera i pagamenti futuri, mentre le notifiche di sicurezza avvisano in caso di accessi sospetti da nuovi dispositivi o reti pubbliche.
- Definisci un budget settimanale e attiva limiti automatici.
- Verifica l’identità subito per evitare ritardi nei prelievi.
- Prova i giochi in modalità demo per capire volatilità e payout.
- Leggi termini di promozioni e requisiti di puntata in anticipo.
- Usa metodi di pagamento tracciabili e sicuri.
- Interrompi la sessione se superi il tempo che ti eri dato.
Sul fronte promozioni, il pacchetto di sportuna bonus copre benvenuto, ricariche e gare a punti con classifiche periodiche. I regolamenti indicano puntate massime consentite durante i requisiti, contributi diversi tra slot e tavoli e scadenze chiare; seguendoli, si evitano errori comuni. In alcune campagne mirate possono comparire sportuna free spins su slot popolari: strumenti utili per testare meccaniche nuove senza intaccare il saldo reale.
Per chi gioca dal telefono, sportuna app punta su semplicità e stabilità: login biometrico dove supportato, navigazione a schede, ricerca per provider e cronologia dei giochi usati di recente. Le notifiche personalizzabili segnalano tornei in avvio o promozioni imminenti, mentre le impostazioni di risparmio dati riducono consumo e tempi di caricamento su reti mobili con copertura incerta.
| Sezione | Cosa trovi | Note utili |
|---|---|---|
| Giochi slot | Megaways, cluster, volatilità variabile | Demo disponibili, info RTP visibili |
| Live e tavoli | Roulette, blackjack, game show | Limiti per budget diversi, regole in lobby |
| Promozioni | Ricariche, missioni, tornei | Requisiti trasparenti, scadenze nel profilo |
| Mobile e app | PWA da browser, sportuna casino app per focus su tavoli e live | Preferiti sincronizzati, notifiche configurabili |
| Pagamenti e supporto | Carte, wallet, bonifici; chat ed email | Prelievi dopo KYC, orari indicati nella sezione aiuto |
Prima di iniziare una nuova sessione, verifica sempre i limiti attivi e valuta la volatilità dei titoli che scegli. Pianifica ricariche sostenibili, sfrutta gli strumenti di cronologia per rivedere le giocate e, quando servono chiarimenti, contatta l’assistenza con screenshot e ID della transazione a portata di mano. Un approccio ordinato ti consente di trarre il massimo dall’intrattenimento, mantenendo al centro controllo e responsabilità.
Scelte consapevoli nelle piattaforme di gioco online
Orientarsi tra casinò e siti di scommesse online richiede un approccio critico: licenze riconosciute, strumenti di controllo del gioco, pagamenti trasparenti e cataloghi di titoli con RTP dichiarati. Molti utenti valutano l’ergonomia dell’interfaccia, la rapidità dei prelievi, le promozioni senza condizioni eccessive e la disponibilità di un’assistenza competente in italiano. Anche l’esperienza mobile, la sicurezza dei dati e la chiarezza dei termini restano aspetti decisivi, perché una piattaforma affidabile deve coniugare divertimento e responsabilità con politiche chiare su limiti, verifica dell’identità e protezione delle informazioni sensibili.
Nel mare di opzioni spiccano marchi con identità forti: alcuni giocatori citano con favore stake casino per l’interfaccia moderna, la varietà di slot e giochi live e una community molto attiva; altri preferiscono realtà più tradizionali, con tornei frequenti, jackpot progressivi e un focus marcato sui tavoli classici. In entrambi i casi conviene andare oltre il nome e analizzare schemi di pagamento, percentuali di ritorno, trasparenza delle regole e tempestività del supporto, così da individuare il servizio davvero adatto alle proprie abitudini e al proprio budget.
Per approfondire temi come promozioni realistiche, requisiti di puntata, metodi di deposito e pratiche di gestione del bankroll, puoi consultare risorse dedicate e guide indipendenti; una panoramica ordinata e in italiano è disponibile su stakecasinoit.eu, dove le informazioni vengono sintetizzate in modo chiaro, con avvertenze utili per evitare errori comuni e strumenti per confrontare rapidamente le caratteristiche più importanti prima dell’iscrizione.
Chi alterna casinò e scommesse desidera un passaggio fluido tra sezioni: quote aggiornate, mercati speciali e streaming affidabile fanno la differenza per il bettor attento. Quando un operatore organizza l’area sport, talvolta la denomina stake bet per contraddistinguere i palinsesti e la gestione dei coupon; in parallelo, l’esperienza su smartphone e tablet guadagna punti con la presenza di una leggera stake app, capace di notificare risultati, salvare preferiti, semplificare i pagamenti e integrare strumenti di autolimitazione senza appesantire la batteria.
La parola stake, nel gergo del gioco, rimanda tanto alla puntata quanto alla misura della propria esposizione al rischio: stabilire unità coerenti, rispettare un tetto settimanale e saper interrompere una sessione quando la soglia è raggiunta sono pratiche semplici ma decisive. Strategie responsabili, promozioni senza vincoli improponibili e informazioni trasparenti sui provider aiutano a trasformare l’intrattenimento in un passatempo consapevole, evitando inseguimenti impulsivi e valorizzando l’analisi a freddo dei risultati.
Prima di registrarti, crea una semplice checklist e valuta i punti essenziali con calma. Considera i costi occulti, la chiarezza delle pagine informative e la presenza di tutorial che illustrino meccaniche, probabilità e limiti personalizzabili. Ricorda che l’attività di gioco dovrebbe rimanere sostenibile: definisci una cifra massima, pianifica sessioni brevi e monitora gli esiti per mantenere il controllo in ogni momento.
- Verifica la licenza rilasciata da autorità riconosciute e procedure KYC rapide.
- Controlla termini dei bonus, requisiti di puntata, scadenze e giochi contribuenti.
- Seleziona metodi di pagamento diffusi, con commissioni assenti e accrediti trasparenti.
- Valuta il catalogo: slot, tavoli, show dal vivo e produzione di provider affidabili.
- Assicurati di avere assistenza in italiano con chat, email tracciabile e FAQ aggiornate.
La tabella seguente sintetizza alcune voci comuni che i giocatori analizzano quando scelgono una piattaforma. Usala come promemoria veloce per confrontare le opzioni e prendere decisioni coerenti con le tue priorità, senza tralasciare i dettagli che spesso fanno la differenza tra un’esperienza fluida e una deludente.
| Aspetto | Vantaggio per l’utente | Nota pratica |
|---|---|---|
| Bonus di benvenuto | Capitale extra per testare nuovi giochi con rischio contenuto. | Controlla limiti di prelievo e giochi esclusi; talvolta è presentato come stake bonus. |
| Programma fedeltà | Ricompense progressive, cashback, missioni e tornei periodici. | Valuta livelli raggiungibili, condizioni reali e utilità dei premi. |
| Tipologie di gioco | Offerta bilanciata tra slot, tavoli, live show e game speciali. | Prova le demo, leggi l’RTP e scegli titoli con volatilità adatta. |
| Responsabilità | Limiti, time-out e autoesclusione aiutano a mantenere il controllo. | Imposta soglie prima di iniziare e rivedile periodicamente. |
Infine, considera l’esperienza complessiva: velocità del sito, chiarezza grafica, stabilità su rete mobile e qualità delle pagine di aiuto. Prendersi il tempo per leggere regolamenti e politiche di privacy, confrontare i provider di pagamento e testare le funzioni gratuite riduce gli imprevisti. Una scelta ponderata, guidata da dati e preferenze personali, rende l’intrattenimento più sereno e ti permette di concentrarti su ciò che conta davvero: divertimento, sicurezza e controllo del budget.
Panoramica di una piattaforma di gioco moderna: esperienza, sicurezza e usabilità
Nel panorama del gioco online, scegliere una piattaforma affidabile è fondamentale per godersi intrattenimento di qualità senza rinunciare alla sicurezza. Gli utenti più attenti confrontano design, velocità di caricamento, chiarezza dei menu e trasparenza delle informazioni prima di registrarsi. In questo contesto, diverse esperienze reali mostrano come i servizi migliori si distinguano per percorsi di accesso lineari, metodi di pagamento flessibili e assistenza disponibile. Tra le realtà spesso citate come esempi di interfaccia curata e navigazione intuitiva c’è anche Vincispin, menzionata dagli appassionati quando si discute di coerenza grafica, fluidità dei flussi e attenzione al gioco responsabile.
L’accesso al proprio profilo rappresenta il primo passo cruciale: la procedura di vincispin login viene descritta come snella, con campi essenziali e opzioni di recupero credenziali immediate, utile sia a chi è alle prime armi sia a chi rientra dopo una pausa. Per un contesto più tematico e focalizzato, alcuni utenti preferiscono invece passare dalla pagina dedicata di vincispin casino login, che mantiene lo stesso rigore in termini di verifica dell’identità, applicando controlli standardizzati e limitando al minimo i passaggi superflui, così da garantire continuità tra registrazione, verifica e primo deposito.
L’esperienza in mobilità è un altro aspetto decisivo: con vincispin app l’obiettivo è offrire prestazioni stabili anche con connessioni non perfette, riducendo consumi e tempi di caricamento delle schermate principali. Per chi desidera un ambiente orientato più specificamente ai giochi da tavolo e alle slot, la soluzione parallela è vincispin casino app, pensata per ottimizzare filtri, anteprime e demo, con notifiche non intrusive e un sistema di aggiornamenti che migliora sia la sicurezza sia la compatibilità con i dispositivi più diffusi.
Sul fronte promozionale, la sostenibilità dei vantaggi è centrale: quando si parla di vincispin bonus, gli utenti valutano non solo l’importo nominale, ma soprattutto requisiti di scommessa, limiti di tempo e idoneità dei giochi. Allo stesso modo, l’etichetta vincispin casino bonus indica pacchetti modellati per slot e tavoli live, con puntuali indicazioni su percentuali, massimali di vincita e condizioni di prelievo. La trasparenza di tali dati consente di pianificare il bankroll, evitare sorprese e sfruttare al meglio ogni proposta.
Per chi privilegia un ambiente ricco di categorie e filtri intelligenti, l’offerta collegata a vincispin casino si distingue per la suddivisione tra slot tematiche, giochi da tavolo con varianti moderne, live con croupier professionisti e titoli adatti a sessioni rapide. In questo panorama, il termine vincispin è spesso associato a percorsi chiari: dalla pagina informativa iniziale, alle guide sul funzionamento delle promo, fino ai riepiloghi della propria attività, consultabili in qualunque momento per mantenere il controllo.
La qualità di un servizio si misura anche nella protezione dei dati e nella gestione del rischio. Diversi giocatori sottolineano come il tracciamento delle sessioni, i limiti personalizzabili e i materiali educativi evitino eccessi e migliorino la consapevolezza. In scenari che includono casino vincispin, si enfatizza l’importanza di protocolli cifrati, audit indipendenti e una documentazione chiara su RNG e percentuali di ritorno. Quando queste componenti lavorano insieme, la piattaforma diventa prevedibile nel comportamento e coerente nelle risposte, qualità molto apprezzate dagli utenti esperti.
- Imposta limiti di deposito e sessione in base al tuo budget.
- Controlla sempre i requisiti di scommessa prima di attivare un’offerta.
- Prova le demo per valutare volatilità, ritmo e compatibilità del gioco.
- Verifica le tempistiche di prelievo e i metodi disponibili nella tua area.
| Caratteristica | Perché conta | Impatto sul giocatore |
|---|---|---|
| Velocità di caricamento | Meno attese e meno errori su rete mobile | Sessioni fluide e minori interruzioni |
| Trasparenza dei bonus | Termini chiari e requisiti espliciti | Pianificazione del bankroll più precisa |
| Catalogo giochi | Varietà di slot, tavoli e live | Maggiore possibilità di trovare titoli adatti |
| Strumenti di responsabilità | Limiti, auto-esclusione e statistiche | Controllo del tempo e delle spese |
| Assistenza | Supporto reattivo via chat o email | Risoluzione rapida di dubbi e problemi |
Panoramica, buone pratiche e criteri per scegliere una piattaforma di gioco online
Scegliere una piattaforma di intrattenimento digitale richiede metodo e prudenza: è utile verificare la presenza di licenze riconosciute, l’adozione di protocolli di crittografia aggiornati e la chiarezza delle regole su prelievi, limiti e procedure di verifica dell’identità. Un approccio consapevole prevede di analizzare il catalogo giochi, i tassi di ritorno teorico e la disponibilità di strumenti per il gioco responsabile, così da impostare limiti personali e proteggere il proprio budget. Prima di ogni registrazione, è consigliabile confrontare risorse indipendenti, guide comparative e report tecnici pubblicati da enti di controllo.
Per consultare avvisi, indirizzi utili e informazioni generali in modo ordinato, molti utenti visitano la pagina di Vincispin, dove possono orientarsi tra risorse sulla protezione dei dati, raccomandazioni per l’uso consapevole e riferimenti normativi; resta comunque essenziale leggere con attenzione termini, condizioni e requisiti applicati alle promozioni prima di effettuare depositi o condividere documenti personali.
Molti giocatori scoprono vincispin attraverso guide e recensioni indipendenti, confrontando alternative, tempi di accreditamento e politiche di assistenza per individuare l’esperienza più adatta alle proprie abitudini di gioco.
All’avvio, le pagine di vincispin casino presentano sezioni ben organizzate per slot, tavoli e raccolte tematiche, con filtri chiari, anteprime e indicatori di volatilità utili a pianificare sessioni sostenibili e coerenti con il proprio profilo di rischio.
Per l’accesso quotidiano, la procedura di vincispin login punta su autenticazione sicura, suggerimenti su password robuste, avvisi anti-phishing e opzioni rapide per la reimpostazione delle credenziali in caso di smarrimento.
Durante fasi delicate di verifica, vincispin casino login può integrare controlli aggiuntivi, particolarmente utili quando si impiegano limiti personalizzati, notifiche di sicurezza o quando occorre confermare sessioni avviate su più dispositivi.
Chi predilige la mobilità considera vincispin app una soluzione pratica per ricevere aggiornamenti, gestire preferenze di notifica e monitorare cronologie, impostando criteri di sicurezza coerenti con l’uso su rete mobile.
Tra le promozioni periodiche, spicca vincispin bonus, per il quale è fondamentale esaminare requisiti di puntata, finestre temporali e il contributo dei diversi giochi, evitando scelte impulsive che possano compromettere il bankroll.
Per i nuovi iscritti, vincispin casino bonus può includere pacchetti combinati; la convenienza effettiva dipende da percentuali, tetti massimi e modalità di rilascio, aspetti che incidono direttamente sulla probabilità di completare i requisiti con margini ragionevoli.
Su dispositivi recenti, vincispin casino app mira a ottimizzare caricamenti, consumi di batteria e stabilità, offrendo un’esperienza fluida anche in presenza di grafiche animate, tavoli live e tornei con aggiornamenti in tempo reale.
Nelle community di settore, l’espressione casino vincispin emerge nei confronti tra cataloghi, metodi di pagamento disponibili e qualità delle risposte fornite dal supporto, con particolare attenzione alla gestione dei ticket complessi e delle verifiche KYC.
- Verificare licenza attiva e autorità regolatrice competente.
- Controllare RTP pubblicato, volatilità e versioni demo dei titoli.
- Confrontare metodi di deposito e prelievo, limiti, tempi e costi.
- Leggere attentamente Termini e Condizioni, scadenze e contributi di gioco.
- Impostare limiti, pause e autoesclusione per un gioco realmente responsabile.
| Aspetto | Cosa valutare | Beneficio |
|---|---|---|
| Sicurezza | Crittografia TLS, 2FA, audit indipendenti | Protezione dei dati e degli accessi |
| Catalogo giochi | Varietà, provider affidabili, versioni demo | Esplorazione senza rischio e maggiore scelta |
| Promozioni | Requisiti chiari, contributo giochi, scadenze | Decisioni informate su valore reale |
| Pagamenti | Portafogli digitali, bonifici, limiti e valute | Flussi finanziari prevedibili e rapidi |
| Assistenza | Chat, tempi di risposta, lingua e escalation | Risoluzione efficace dei problemi |
| Mobile | Compatibilità, consumo dati, accessibilità | Continuità d’uso in ogni contesto |
| Trasparenza | Politiche KYC/AML, privacy, gestione dispute | Tutela legale e chiarezza operativa |
Prima di aderire a qualsiasi iniziativa, è consigliabile testare i giochi in modalità prova, annotare volatilità, frequenza delle vincite e oscillazioni del saldo virtuale. Questa raccolta di dati, anche se semplificata, aiuta a costruire aspettative realistiche e a stabilire un budget sostenibile. Un piano prudente include obiettivi misurabili, soglie di perdita e un limite di tempo prefissato, in modo da evitare sessioni troppo lunghe o decisioni dettate dall’emotività.
Per migliorare la qualità dell’esperienza, è utile mantenere aggiornati i dispositivi, misurare la qualità della rete e ridurre notifiche non essenziali durante il gioco. Nel confronto tra offerte, è opportuno considerare la flessibilità dei limiti, la velocità dei prelievi e la trasparenza delle comunicazioni inviate dall’assistenza. In caso di dubbi su termini o requisiti, conviene contattare il supporto con domande specifiche e salvare le risposte, così da avere riferimenti chiari e verificabili.
Guida completa all’esperienza di gioco e scommesse online
Nel panorama del gioco digitale, gli utenti cercano un equilibrio tra intrattenimento, sicurezza e valore. Una piattaforma di qualità deve offrire cataloghi aggiornati, promozioni trasparenti e strumenti per proteggere il giocatore. Fondamentali sono la chiarezza delle regole, la rapidità dei pagamenti e la disponibilità di un supporto competente, capace di intervenire quando serve, via chat, email o telefono. In aggiunta, contano licenze riconosciute, protocolli crittografici moderni e una politica severa contro frodi e comportamenti scorretti, così da garantire un’esperienza coerente e stabile nel tempo, sia da desktop sia da dispositivi mobili, senza compromessi sulla qualità.
Per orientarsi tra bonus, promozioni settimanali e tornei tematici, può essere utile confrontare termini, requisiti e tempistiche di sblocco, oltre a valutare la varietà dei titoli e la fluidità dell’interfaccia. Chi desidera approfondire un esempio pratico può visitare Luxurybet, dove l’organizzazione dei contenuti, la chiarezza delle pagine informative e i filtri di ricerca aiutano a trovare in pochi clic ciò che serve, migliorando la navigazione e riducendo gli errori nelle fasi più delicate, come la registrazione o la verifica dell’account.
La procedura di luxurybet login è stata progettata per essere rapida e sicura, con autenticazione a più livelli e promemoria per il recupero delle credenziali quando necessario. Una volta entrati nell’area personale, è consigliabile impostare limiti di deposito e di tempo di sessione, controllare lo storico delle transazioni e abilitare eventuali notifiche sulle novità. In questo modo si mantiene un controllo costante sul saldo e si pianifica meglio l’uso del budget, prevenendo abitudini impulsive o giocate non pianificate.
Nell’area luxurybet casino, la diversità dei giochi è un criterio decisivo: slot con meccaniche Megaways, jackpot progressivi, tavoli di blackjack e roulette in versione sia RNG sia live, insieme a un’offerta di game show e varianti meno comuni per i più curiosi. La qualità dei provider, gli RTP dichiarati e le funzioni bonus (giri gratis, moltiplicatori, buy feature) incidono sull’esperienza complessiva. È utile testare i titoli in modalità demo quando disponibile, per familiarizzare con regole, volatilità e dinamiche dei round bonus, così da scegliere con maggiore consapevolezza quali giochi privilegiare.
Sul fronte luxurybet scommesse, il palinsesto dovrebbe includere eventi principali e minori, mercati pre-match e live, statistiche in tempo reale e, quando offerto, cash out parziale o totale. Quote competitive, grafici dell’andamento del match e opzioni di combinazione migliorano la strategia di gioco, soprattutto se si tengono a portata di mano cronache, infortuni e trend di forma. Un calendario filtrabile per sport, campionati e fasce orarie consente di programmare le giocate con criterio e di evitare decisioni affrettate durante i momenti più caldi delle partite in diretta.
La proposta di luxurybet punta su trasparenza nelle promozioni, calendario chiaro delle missioni e un hub responsabile con test di autovalutazione, strumenti di autoesclusione e link a enti di supporto. L’obiettivo è offrire un ambiente solido, dove intrattenimento e tutela procedono di pari passo. Monitorando depositi, prelievi e limiti personalizzati, si mantiene un approccio equilibrato, adatto sia a neofiti attenti al budget sia a utenti esperti alla ricerca di nuove sfide.
| Aspetto | Descrizione | Per chi è ideale |
|---|---|---|
| Bonus di benvenuto | Pacchetti su primo deposito, giri gratis e missioni con requisiti esposti in modo chiaro, incluse scadenze e giochi idonei. | Nuovi utenti che desiderano iniziare con un extra, mantenendo il controllo dei requisiti. |
| Catalogo giochi | Slot, tavoli RNG e live, game show, oltre a filtri per tema, volatilità e provider più affidabili. | Appassionati che amano esplorare e selezionare in base a preferenze specifiche. |
| Metodi di pagamento | Circuiti carte, wallet digitali e bonifici, con tempi di accredito e prelievo dichiarati in anticipo. | Utenti che privilegiano velocità, tracciabilità e costi ridotti. |
| Assistenza clienti | Chat dal vivo, email e FAQ dettagliate, con operatori formati su procedure e sicurezza. | Chi desidera risposte rapide e soluzioni concrete. |
- Stabilisci un budget settimanale e rispettalo con rigore.
- Fermati quando raggiungi il limite di tempo prefissato.
- Leggi termini e requisiti di qualsiasi promozione.
- Preferisci metodi di pagamento che conosci bene.
- Consulta le statistiche prima di puntare su eventi live.
Prima di partecipare a promozioni, controlla le condizioni, i limiti massimi di vincita e i tempi di lavorazione dei prelievi. In caso di dubbi su regole, puntate o convalida dei documenti, è saggio contattare l’assistenza e conservare le comunicazioni. Ricorda che il gioco deve restare un passatempo: se senti di perdere il controllo, utilizza gli strumenti di pausa o chiedi supporto a enti specializzati, tutelando priorità e benessere personale.
Panoramica su piattaforme di gioco e scommesse: criteri di scelta e buone pratiche
Nel panorama italiano del gioco online, scegliere una piattaforma affidabile richiede attenzione sia alle funzioni sia alle tutele per l’utente. Gli appassionati valutano quote, varietà di eventi, qualità del casinò, e soprattutto la chiarezza delle condizioni promozionali. Un’esperienza positiva non dipende solo dall’interfaccia, ma anche dalla rapidità dei pagamenti, dalla trasparenza dei limiti di deposito e dagli strumenti per il gioco responsabile. Informarsi prima di registrarsi, confrontare servizi e leggere le guide ufficiali sono passaggi essenziali per investire tempo e denaro con consapevolezza.
Tra le ricerche più comuni spicca la query begamestar scommesse, spesso digitata da chi desidera capire come vengono presentati i mercati, quali sport sono coperti e quali strumenti di analisi sono disponibili prima di piazzare un pronostico. È utile verificare se esistono statistiche integrate, filtri per campionati e promemoria per le puntate ricorrenti, così da mantenere ordine e controllo all’interno del proprio percorso di gioco.
Per una panoramica aggiornata delle funzioni disponibili, consulta il sito ufficiale di Begamestar, dove sezioni, guide e modalità di gioco vengono illustrate in modo sintetico e con riferimenti ai limiti, alle quote e alle tempistiche di pagamento.
Molti utenti chiedono della begamestar app, valutando se convenga utilizzare l’applicazione dedicata o restare sulla versione mobile del sito. La scelta dipende dall’ottimizzazione del dispositivo, dalla frequenza con cui si scommette e dalla necessità di ricevere notifiche in tempo reale. Un’app ben progettata offre navigazione fluida, autenticazione sicura, gestione rapida dei metodi di pagamento e consultazione dello storico, elementi che possono fare la differenza nelle giocate live e nelle sessioni di casinò.
Un aspetto spesso sottovalutato riguarda il begamestar login: l’accesso deve essere protetto da credenziali robuste, eventualmente rafforzate da autenticazione a due fattori, e supportato da procedure di recupero chiare. Tenere al sicuro i dati personali, limitare l’uso di reti pubbliche e aggiornare regolarmente la password sono buone pratiche, unite alla verifica della sezione profilo per controllare impostazioni, limiti e preferenze di notifica.
Capitolo cruciale: il begamestar bonus. Ogni promozione dovrebbe essere letta nei dettagli, con massima attenzione ai requisiti di puntata, ai giochi che contribuiscono al completamento del wagering e alle scadenze. Un’offerta davvero utile è quella che si adatta al proprio stile, senza forzare puntate eccessive. Pianificare l’uso delle promozioni, evitare sovrapposizioni e monitorare il saldo reale rispetto a quello vincolato sono accorgimenti semplici ma efficaci.
Guardando all’esperienza complessiva, begamestar ha puntato su una presentazione ordinata delle sezioni, con percorsi chiari dalla registrazione al primo deposito. La suddivisione tra scommesse, casinò e live contribuisce a ridurre la frizione, mentre i tutorial di base aiutano i nuovi utenti a comprendere meccaniche e probabilità. Restano fondamentali, in ogni caso, l’autodisciplina e l’uso degli strumenti per l’autolimitazione.
Prima di avviare qualsiasi attività, è consigliabile fissare un budget e trattarlo come una spesa per l’intrattenimento. Le piattaforme serie mettono a disposizione strumenti di reality check, autoesclusione temporanea e limiti personalizzabili; sfruttarli significa proteggere il divertimento. Infine, confrontare le esperienze di altri giocatori e contattare l’assistenza in caso di dubbi permette di evitare fraintendimenti e di operare con maggiore serenità.
Un altro fattore centrale è la gestione del tempo: fissare sessioni brevi, fare pause e annotare i risultati aiuta a mantenere lucidità. Molti utenti creano un conto separato dedicato all’intrattenimento, in modo da non confondere le spese quotidiane con le attività ludiche. Pianificare, monitorare e correggere il proprio approccio nel tempo è il modo migliore per far crescere competenza e serenità.
| Sezione | Punti di forza | Per chi è adatta |
|---|---|---|
| Scommesse sportive | Quote competitive, cronologia puntate, cash out parziale | Utenti orientati all’analisi dei mercati |
| Casinò Live | Dealer professionisti, tavoli con limiti variabili, streaming stabile | Chi cerca interazione realistica |
| Slot e giochi RNG | Catalogo ampio, demo, filtri per volatilità e provider | Chi vuole sessioni rapide e dinamiche |
| Promozioni e missioni | Sfide periodiche, classifiche a tempo, requisiti esposti con chiarezza | Giocatori che programmano il bankroll |
| Pagamenti | Metodi diffusi, tempistiche definite, procedure di verifica snelle | Utenti che privilegiano sicurezza e tracciabilità |
- Verificare licenze, conformità e politiche sul gioco responsabile
- Impostare limiti di deposito, perdita e sessione prima di iniziare
- Leggere con attenzione termini e condizioni delle promozioni
- Valutare la qualità dell’assistenza e i canali di contatto disponibili
- Controllare eventuali commissioni e i tempi di prelievo
- Testare l’esperienza mobile e le prestazioni su rete cellulare
Guida alla scelta di un casinò e bookmaker online in Italia
Orientarsi tra piattaforme di gioco e scommesse in Italia richiede metodo, attenzione ai dettagli e una chiara strategia personale. Prima di registrarsi, è fondamentale verificare l’affidabilità dell’operatore, l’ampiezza del palinsesto, la chiarezza dei termini promozionali e la qualità degli strumenti per il gioco responsabile. Un portale ben strutturato offre guide trasparenti, interfaccia intuitiva, sezioni dedicate agli aiuti e tempi rapidi per prelievi e assistenza. Allo stesso tempo, conviene misurare l’esperienza in live casino, la varietà delle slot e la completezza delle scommesse sportive, specialmente su eventi in-play. Una valutazione complessiva deve includere costi, limiti, sicurezza e la capacità della piattaforma di supportare scelte informate e sostenibili.
Tra i marchi più discussi, betriviera spicca per impostazione editoriale focalizzata su chiarezza e confronto dei servizi. Gli utenti più esigenti di solito cercano tabelle di confronto dei bonus, spiegazioni sui requisiti di puntata, schede tecniche dei provider e guide all’uso di strumenti come cash-out, statistiche e promo ricorrenti. È utile concentrarsi sulle funzionalità concrete che impattano ogni sessione: dai metodi di pagamento abilitati ai limiti impostabili sul conto, fino alle notifiche che aiutano a tenere sotto controllo tempo e budget.
Per un riferimento aggiornato sulle funzioni e sulle novità, consulta il sito ufficiale all’indirizzo https://betriviera.it/, dove potrai verificare termini, promozioni e strumenti di tutela. Un controllo periodico ti consente di cogliere miglioramenti, valutare aggiornamenti dei cataloghi e confrontare in modo oggettivo le opportunità disponibili.
| Funzionalità | Dettagli | Vantaggio per il giocatore |
|---|---|---|
| Bonus di benvenuto | Percentuale sul primo deposito con requisiti chiari | Capitale extra per testare giochi senza rischi eccessivi |
| Giri gratuiti | Free spin su slot selezionate con tetto alle vincite | Opportunità di provare titoli popolari a costo ridotto |
| Live casino | Tavoli con croupier reali, streaming HD e chat | Esperienza immersiva e ritmo di gioco più coinvolgente |
| Scommesse sportive | Quote competitive, cash-out e mercati in-play | Maggiore controllo sulle puntate e varie strategie |
| Pagamenti | Carte, wallet, bonifici e limiti personalizzabili | Velocità nei prelievi e gestione responsabile del budget |
- Verifica licenza ADM e protocolli SSL attivi.
- Controlla requisiti di scommessa dei bonus e scadenze.
- Valuta RTP, volatilità e catalogo dei provider.
- Esamina tempi di prelievo e commissioni nascoste.
- Testa l’assistenza via chat, email e telefono.
La gestione del bankroll è il pilastro di qualsiasi approccio solido. Definisci un budget mensile, suddividilo in sessioni e limita l’importo di ogni puntata in base alla volatilità del gioco scelto. Slot e giochi da tavolo hanno profili di rischio differenti: costruire un mix equilibrato tra intrattenimento e controllo permette di ridurre l’impatto della varianza. Prendere nota dei risultati, annotare sensazioni e decisioni in tempo reale aiuta a correggere abitudini inefficaci, migliorando progressivamente la qualità delle scelte.
Un operatore maturo integra tutorial, regole chiare e filtri di ricerca efficienti. La sezione informativa dovrebbe spiegare con esempi come funzionano i requisiti di puntata, come si applicano le scommesse qualificanti e in che modo vengono calcolati i contributi dei diversi giochi. Nelle scommesse sportive, indicatori come lavagna, margini e liquidità dei mercati sono determinanti per valutare il reale valore delle quote. Nel live casino, la stabilità dello streaming e l’ergonomia dell’interfaccia fanno la differenza quando il ritmo aumenta.
Gli strumenti per il gioco responsabile non sono un optional: limiti di deposito, reality check, autoesclusione temporanea o permanente, chiusura dei bonus e guide preventive aiutano a mantenere il controllo. Valuta anche la trasparenza sulle probabilità di vincita, i canali per contattare enti di supporto e la presenza di link rapidi per impostare restrizioni. Una piattaforma che incoraggia pause regolari e fornisce report sull’attività del conto facilita un rapporto sano con il gioco e promuove decisioni più consapevoli.
Infine, assicurati che la piattaforma offra cataloghi aggiornati e provider affidabili, con test indipendenti dei generatori di numeri casuali e audit periodici. Le promozioni dovrebbero essere comprensibili fin dall’anteprima, con esempi numerici, esclusioni in evidenza e cronologia dei bonus facilmente consultabile. L’obiettivo è creare un percorso utente lineare: registrazione chiara, verifica documenti rapida, versamenti e prelievi fluidi, assistenza competente e politiche di sicurezza che proteggano dati e transazioni in ogni fase.
Adottare un approccio analitico, confrontare attentamente le condizioni e misurare risultati nel tempo è la via migliore per ottenere un’esperienza di qualità. Concentrarsi su controllo, trasparenza e sostenibilità consente di valorizzare l’intrattenimento, riducendo al minimo errori e aspettative irrealistiche. Con gli strumenti giusti e una strategia coerente, ogni sessione diventa un’opportunità per imparare, migliorare e divertirsi con responsabilità.
Guida pratica per scegliere un casinò online affidabile e conveniente
Scegliere un casinò online non è soltanto una questione di estetica o di catalogo giochi: è un percorso che coinvolge sicurezza, trasparenza, velocità dei pagamenti e qualità dell’esperienza. Nella panoramica che segue useremo il termine betriviera in funzione esemplificativa per indicare un marchio di riferimento, senza sovraccaricare il discorso con slogan. Il nostro obiettivo è fornire criteri chiari e misurabili, così da aiutarti a distinguere le piattaforme realmente solide da quelle che puntano solo su promozioni appariscenti ma poco sostenibili. Con poche buone abitudini potrai valorizzare il tuo budget, ridurre gli attriti operativi e giocare in un ambiente che mette davvero al centro l’utente.
Il primo passo è verificare la licenza e la reputazione. Una piattaforma regolamentata espone informazioni complete su ente di rilascio, numero della licenza, controlli indipendenti e protocolli di sicurezza. La crittografia dei dati, l’uso di metodi di pagamento affidabili e un KYC rapido ma rigoroso sono segnali positivi. Valuta anche la presenza di limiti configurabili per deposito e perdita: non si tratta solo di conformità normativa, ma di attenzione concreta al benessere del giocatore. Infine, la reputazione si misura anche dalla chiarezza delle comunicazioni: termini sintetici, esempi pratici e un centro assistenza che risponde in tempi ragionevoli.
I bonus meritano un’analisi ragionata. Non guardare soltanto al valore assoluto dell’offerta di benvenuto, ma confronta il rapporto tra importo, percentuale di match, requisiti di scommessa e giochi idonei. La struttura del wagering, la durata della promozione e il limite di puntata per contribuire al rollover incidono in modo determinante sulla reale convertibilità del bonus. Free spin, cashback e missioni ricorrenti sono interessanti se inseriti in un calendario coerente, senza costringerti a deviare dai giochi che preferisci. Le promozioni migliori premiano la costanza con progressi misurabili e non ti spingono a forzare il ritmo di gioco.
Un catalogo bilanciato include slot con volatilità diverse, giochi da tavolo con regole chiare e una sezione live stabile. La trasparenza su RTP, contributo ai requisiti e limiti di puntata è essenziale. Provider riconosciuti garantiscono standard di qualità, mentre filtri efficaci ti aiutano a navigare per tema, meccaniche e frequenza delle vincite. Eventi con jackpot o tornei dovrebbero essere accompagnati da classifiche aggiornate e criteri di punteggio italiani e facili da interpretare.
Pagamenti e operatività quotidiana fanno la differenza. Preferisci piattaforme con wallet istantanei o carte diffuse, commissioni esplicite e un processo di prelievo lineare. I tempi dichiarati per la verifica documentale e per l’accredito dovrebbero essere indicati in ore o giorni, non in stime vaghe. L’esperienza mobile deve replicare quella desktop: interfaccia accessibile, caricamenti rapidi, pulsanti ben distanziati e notifiche che non interrompano le sessioni di gioco. Un servizio clienti multicanale, con chat dal vivo e guida dinamica, è un plus concreto.
Ricorda il gioco responsabile. Limiti personalizzati, cronologia dettagliata, pause programmabili e strumenti di autoesclusione danno controllo e serenità. Una buona piattaforma fornisce calcolatori di budget e avvisi di sessione, evitando meccanismi opachi. Anche la comunicazione deve essere sobria: spiegazioni semplici, esempi veritieri e nessun incentivo a inseguire perdite. Valuta la presenza di partnership con enti indipendenti che offrono supporto e formazione sul comportamento di gioco consapevole.
Per confrontare criteri, offerte e strutture di pagamento in modo pratico, puoi consultare risorse editoriali che aggiornano schede tecniche, guide e confronti tra operatori: in particolare, visita Betriviera per approfondimenti su funzionalità, promozioni e linee guida operative, così da trasformare i tuoi dubbi in scelte chiare e sostenibili nel tempo.
- Verifica la licenza e il numero identificativo dell’operatore.
- Leggi i termini dei bonus, con focus su wagering e durata.
- Confronta RTP, volatilità e contributo ai requisiti dei giochi.
- Controlla commissioni e tempi effettivi di accredito dei prelievi.
- Imposta limiti di spesa e sfrutta gli strumenti di gioco responsabile.
| Sezione | Caratteristica | Vantaggio per il giocatore |
|---|---|---|
| Sicurezza | Licenza europea e crittografia | Tutela dei dati e controlli indipendenti |
| Bonus | Benvenuto con wagering sostenibile | Migliore convertibilità e valore reale |
| Giochi | Slot a volatilità variabile e live stabili | Scelte adatte al proprio stile e budget |
| Pagamenti | Wallet istantanei e carte diffuse | Prelievi rapidi e costi trasparenti |
| Mobile | Sito responsive e PWA leggera | Esperienza continua su ogni dispositivo |
In conclusione, affidabilità e convenienza nascono da una combinazione di elementi: licenze chiare, bonus strutturati con buon senso, giochi trasparenti, pagamenti rapidi e un impianto di responsabilità reale. Fissa un budget, scegli con metodo e tieni traccia dei risultati. Così trasformerai l’intrattenimento in un’esperienza consapevole, gratificante e priva di frizioni inutili, lasciando che la qualità emerga dai dettagli operativi di ogni singolo passaggio.
Guida ragionata a una piattaforma di gioco affidabile e consapevole
Quando ci si avvicina al mondo dei portali di intrattenimento digitale, è naturale chiedersi come distinguere un’ottima esperienza da una mediocre. Tra le priorità rientrano la stabilità tecnica, la chiarezza delle regole promozionali, l’assistenza rapida e una selezione di giochi che non sacrifichi qualità per quantità. In questo scenario, molti appassionati citano legiano casino come esempio di approccio centrato sull’utente, dove facilità di navigazione, tempi di caricamento ridotti e percorsi di pagamento snelli contribuiscono a un percorso di gioco fluido, bilanciato e, soprattutto, trasparente.
Prima ancora di effettuare una registrazione, chi desidera informarsi consulta guide indipendenti, blog di settore e forum. Non sorprende quindi che ricerche come legiano online risultino frequenti tra i giocatori che vogliono confrontare bonus, metodi di deposito, tempistiche di prelievo e percentuali RTP. Analizzare in anticipo questi elementi aiuta a prevenire fraintendimenti e consente di impostare un budget realistico, riducendo l’impulsività e mantenendo il divertimento entro confini sostenibili.
Tra le diciture più ricorrenti, legiano casino online indica una piattaforma che integra slot, tavoli RNG, live game show e giochi con croupier in diretta, il tutto sorretto da protocolli di sicurezza moderni. Il marchio legiano si distingue inoltre per un’impostazione editoriale che spiega con dovizia di particolari termini, condizioni e requisiti di puntata, rendendo più semplice valutare il reale valore delle promozioni e il loro impatto sulla gestione del saldo.
Gli amanti dei rulli apprezzano librerie ampie ma coerenti, che spaziano da titoli classici a meccaniche innovative. In questo contesto, la formula legiano slot viene spesso associata a cataloghi curati, con filtri per volatilità, linee di pagamento e funzionalità speciali. La presenza di versioni demo rappresenta un plus: permette di testare il ritmo del gioco, l’impatto dei bonus interni e la compatibilità con i propri dispositivi senza intaccare il bankroll reale.
Un altro tassello cruciale è l’accesso al profilo. La procedura legiano casino login viene generalmente descritta come snella ma sicura, grazie a verifiche d’identità, autenticazione a due fattori e notifiche operative. Questo riduce i rischi legati ad accessi non autorizzati e salvaguarda dati sensibili, metodi di pagamento e cronologia delle transazioni. L’interfaccia di gestione dell’account, se ben progettata, rende intuitive anche operazioni come l’impostazione dei limiti e la consultazione dei documenti KYC.
Nel lessico internazionale capita di incontrare espressioni ibride come legiano online casino, che richiamano la stessa identità progettuale in contesti linguistici diversi. Queste diciture aiutano a orientarsi nelle recensioni estere, a patto di verificare sempre licenze, giurisdizioni applicabili e disponibilità di funzioni localizzate come metodi di pagamento nazionali, traduzioni accurate dell’interfaccia e assistenza in italiano.
Un punto interessante riguarda il modo in cui i confronti tra brand vengono presentati. Capita che qualcuno parli di casino legiano per invertire i termini ed evidenziare le caratteristiche distintive rispetto ad altri operatori. In tali analisi, conviene guardare oltre gli slogan: struttura dei tornei, calendario delle promozioni ricorrenti, qualità dei provider, limiti di puntata e tempi medi di prelievo offrono un quadro molto più affidabile della semplice vetrina iniziale.
La mobilità è ormai lo standard e giocare da smartphone non è più un ripiego. L’espressione legiano app rimanda a un ecosistema pensato per schermi piccoli, con layout responsive, icone leggibili e navigazione a tocco semplificata. Notifiche intelligenti, consumo contenuto di batteria e un buon equilibrio tra grafica e prestazioni sono segnali di attenzione reale alle esigenze del giocatore in movimento.
Per chi ha completato la verifica del profilo, scorciatoie come legiano login semplificano la ripresa della sessione, con salvataggi sicuri e sincronizzazione dei preferiti tra dispositivi. A corredo, l’area di supporto dovrebbe offrire una base di conoscenze chiara, tutorial sintetici, e canali rapidi come chat live e messaggistica asincrona, così da risolvere dubbi su pagamenti, limiti, tornei e promozioni senza attese estenuanti.
Se desideri un riferimento ufficiale e aggiornato, puoi consultare la pagina istituzionale all’indirizzo https://legiano.bz.it/, dove sono riepilogate normative, strumenti di autolimitazione e informazioni su privacy e sicurezza, utili per un approccio al gioco informato e responsabile.
| Caratteristica | Dettagli principali | Valore per il giocatore |
|---|---|---|
| Licenze e sicurezza | Crittografia TLS, audit indipendenti, KYC e 2FA | Tutela dei dati e protezione dell’account |
| Tipi di giochi | Slot, tavoli RNG, live dealer, game show | Varietà senza sacrificare la qualità |
| Bonus di benvenuto | Struttura a scaglioni con requisiti chiari | Progressione sostenibile e trasparente |
| Promozioni ricorrenti | Free spin, cashback, missioni settimanali | Coinvolgimento costante e controllo del budget |
| Pagamenti | E-wallet, carte, bonifici, limiti configurabili | Velocità, flessibilità e tracciabilità |
- Verifica sempre licenza, sede legale e provider collegati alla piattaforma.
- Controlla RTP e volatilità dei titoli che intendi provare, iniziando in modalità demo.
- Leggi con attenzione termini, esclusioni e finestre temporali dei bonus.
- Imposta limiti di deposito, perdita e tempo di sessione prima di giocare.
- Valuta l’assistenza: tempi medi di risposta, canali disponibili e qualità delle soluzioni.
Guida pratica per scegliere e utilizzare al meglio una piattaforma di gioco online
Nel panorama del gioco online in Italia, megapari casino è spesso citato come riferimento per chi cerca slot, tavoli dal vivo e scommesse con quote competitive. La piattaforma si distingue per un catalogo ampio e per interfacce rapide, ma ciò che attrae di più è l’attenzione alla protezione dei dati, all’equità dei titoli e alla trasparenza sui limiti di spesa. Per gli utenti che desiderano sperimentare nuovi giochi senza investire subito grandi somme, le demo gratuite e i filtri per volatilità sono strumenti utili. Allo stesso tempo, megapari offre una navigazione ordinata, con sezioni tematiche facilmente raggiungibili dal menu principale e percorsi chiari per trovare i contenuti preferiti senza dispersioni.
Prima di iniziare, è importante conoscere le procedure di verifica. Il percorso di iscrizione richiede documenti aggiornati e conferma dell’età, passaggi semplici ma fondamentali per tutelare il giocatore. Chi preferisce un accesso rapido troverà nel megapari login un punto di ingresso essenziale, con autenticazione a più fattori opzionale e possibilità di ricordare il dispositivo in sicurezza. Per chi punta soprattutto ai tavoli con croupier reali, la funzione megapari casino login semplifica l’ingresso diretto nell’area live, riducendo attese e reindirizzamenti superflui e permettendo di riprendere una sessione lasciata in sospeso con pochi tocchi.
Molti preferiscono giocare dallo smartphone, e in questo contesto la megapari app consente sessioni fluide, aggiornamenti leggeri e sincronizzazione dei limiti di gioco responsabile tra dispositivi. Le notifiche configurabili aiutano a non perdere tornei, montepremi speciali o l’apertura di un nuovo tavolo, mentre la modalità a risparmio dati è utile quando la connessione non è perfetta. L’interfaccia mobile, pensata per l’uso con una sola mano, facilita scorrimento, ricerca e passaggio rapido tra le categorie.
Un altro tema caldo riguarda le promozioni. Il pacchetto megapari bonus può includere giri gratuiti su slot selezionate, cashback sui tavoli o incrementi di quota legati a eventi specifici. È sempre consigliabile leggere con cura i termini: requisiti di scommessa, contributi diversi per tipologia di gioco e finestre temporali sono elementi che incidono sulla reale convenienza. La gestione del bankroll dovrebbe restare prioritaria, preferendo incentivi che si adattino al proprio stile e a una pianificazione sostenibile nel medio periodo, così da evitare squilibri tra divertimento e rischi.
Per approfondire funzioni, tempistiche dei pagamenti e linee guida aggiornate, molti utenti consultano risorse esterne: ad esempio, la guida su Megapari bet offre una panoramica sintetica ma accurata, utile per chiarire dubbi prima di registrarsi o effettuare un deposito.
Quando si parla di strategie, l’approccio megapari bet è spesso citato per indicare una gestione metodica delle puntate: fissare obiettivi realistici, evitare rincorse dopo una perdita e suddividere il budget in unità stabili. Questa disciplina non garantisce vincite, ma riduce gli errori impulsivi e rende più facile accettare la varianza tipica dei giochi di fortuna. Un percorso consapevole passa anche dall’auto-valutazione: se una promozione o un formato non è in linea con la propria tolleranza al rischio, è meglio attendere alternative più adatte, senza forzare la mano.
Per aiutare nella valutazione delle aree principali di un portale, di seguito trovi una sintesi che mette a confronto sezioni e caratteristiche tipiche. Confrontare questi elementi prima di iscriversi permette di scegliere ciò che risponde meglio alle proprie abitudini di gioco, riducendo sorprese e massimizzando il comfort d’uso.
| Sezione | Contenuti principali | Note utili |
|---|---|---|
| Slot | Catalogo con volatilità diverse, jackpot, funzioni bonus | Filtri per provider e RTP visibile |
| Live | Blackjack, Roulette, Baccarat con croupier reali | Tavoli multilingua e limiti variabili |
| Promozioni | Welcome pack, cashback, tornei | Termini e condizioni da verificare in anticipo |
| Pagamenti | Carta, wallet, bonifico | Tempi di prelievo indicativi e KYC richiesto |
| Supporto | Chat, email, FAQ | Disponibilità estesa e risposte tracciabili |
Prima di avviare la prima sessione, vale la pena considerare alcune buone pratiche. In questo modo si costruisce una routine solida, si evita l’improvvisazione e si rende più semplice monitorare i risultati nel tempo. Anche pochi accorgimenti, applicati con costanza, possono fare la differenza nella percezione del rischio e nella qualità complessiva dell’esperienza.
- Imposta limiti di deposito e di tempo, rispettandoli con rigore.
- Controlla RTP e volatilità per scegliere giochi in linea con le tue aspettative.
- Diversifica puntate e formati per evitare dipendenza da un solo risultato.
- Leggi sempre i termini delle promozioni, soprattutto requisiti e scadenze.
- Pianifica pause regolari per mantenere lucidità e concentrazione.
In definitiva, una piattaforma affidabile non si giudica solo dai cataloghi o dalle percentuali di ritorno, ma anche dalla chiarezza delle regole, dall’efficienza dei pagamenti e dalla qualità del supporto. Con informazioni aggiornate, limiti ben impostati e un approccio prudente, l’esperienza di gioco può restare piacevole, consapevole e in linea con i propri obiettivi personali.
Guida rapida a giochi, quote e promozioni per un’esperienza completa
Nel mondo del gaming online, la qualità dell’esperienza non dipende solo dal numero di titoli disponibili, ma anche dalla cura per i dettagli: fluidità dell’interfaccia, metodi di pagamento sicuri, assistenza puntuale, promozioni chiare e strumenti per il gioco responsabile. Scegliere una piattaforma ben strutturata significa poter passare con naturalezza dal casinò alle scommesse, dai tornei alle slot, mantenendo sempre controllo, trasparenza e un ritmo di gioco adatto alle proprie preferenze personali.
Il marchio allinbet è spesso citato per l’attenzione alla facilità d’uso e alla varietà di servizi integrati, elementi che aiutano sia i principianti sia i giocatori più esperti a orientarsi. Dagli sport tradizionali agli eventi live, dai giochi di carte alle nuove varianti di intrattenimento digitale, il filo conduttore resta la combinazione tra interfaccia intuitiva, regolamenti chiari e una sezione informativa che spieghi termini, condizioni e limiti impostabili, così da evitare fraintendimenti e tutelare il budget.
Per chi ama tavoli e slot, su allinbet casino spiccano cataloghi ampi, filtri per tema o fornitore e strumenti per monitorare sessioni e spesa. La possibilità di testare alcuni titoli in modalità prova, dove prevista, aiuta a capire meccaniche e volatilità. A ciò si aggiungono funzioni mirate come la ricerca rapida, che consente di arrivare in pochi clic al gioco preferito senza disperdere tempo o concentrazione.
Per una panoramica ufficiale e offerte aggiornate, consulta la pagina di Allinbet scommesse, così da confrontare quote, mercati e strumenti utili prima di giocare responsabilmente. Ricordati di verificare sempre requisiti di partecipazione, scadenze e modalità di adesione delle promo, oltre alle regole di ogni disciplina sportiva su cui intendi puntare.
Nel palinsesto digitale dedicato allo sport, l’area di allinbet scommesse si distingue per la varietà di mercati pre-match e live, con statistiche sintetiche che semplificano l’analisi. La chiave è impostare limiti realistici e scegliere pochi eventi ben studiati, invece di puntare in modo dispersivo. Quote competitive e aggiornamenti in tempo reale completano un quadro agile e mirato alla chiarezza.
Gli appassionati di carte trovano nella proposta allinbet poker tornei programmati, tavoli cash e formati rapidi. La lobby ordinata, con livelli e buy-in differenziati, aiuta a individuare il contesto più adatto alla propria esperienza e al tempo disponibile. Guide essenziali su probabilità, posizioni e gestione dello stack rafforzano un approccio di lungo periodo, fondato su disciplina e studio.
Per accedere in modo sicuro e veloce, la procedura allinbet login è snella ma attenta alla protezione dei dati. Buone pratiche includono l’uso di password robuste, la verifica in due passaggi quando disponibile e il controllo periodico delle attività recenti. Una gestione ordinata delle credenziali riduce rischi e mantiene la tua esperienza serena nel tempo.
- Verifica la tua età e i documenti richiesti.
- Imposta limiti di deposito e sessione.
- Leggi termini, quotazioni e regolamenti.
- Prova funzioni e interfaccia in anticipo.
- Gioca con budget pianificato e costante.
Per la fruizione in mobilità, l’allinbet app mette al centro navigazione rapida, notifiche configurabili e pagine ottimizzate. L’idea è permettere consultazione di risultati, gestione del conto e piazzamento puntate anche lontano dal computer, senza sacrificare sicurezza o chiarezza. Impostazioni personalizzabili e sincronizzazione dei dati garantiscono continuità tra i vari dispositivi.
| Sezione | Punti di forza | Dettagli utili |
|---|---|---|
| Casino | Catalogo ampio e filtri rapidi | Slot, tavoli e titoli live ben organizzati |
| Scommesse | Quote aggiornate e mercati live | Statistiche sintetiche e cash-out dove previsto |
| Poker | Tornei programmati e vari livelli | Formati rapidi e tavoli cash per ogni bankroll |
| Mobile | Interfaccia snella e notifiche | Gestione conto, risultati e puntate in movimento |
Chi desidera promozioni competitive può valutare con attenzione i termini dell’allinbet bonus, verificando requisiti di puntata, scadenze e giochi che contribuiscono al completamento. Un approccio paziente, con obiettivi realistici e sessioni pianificate, aiuta a godere dell’intrattenimento riducendo stress e decisioni impulsive. La priorità resta sempre il controllo del tempo, del budget e delle aspettative.
Guida completa all’esperienza di gioco e scommesse
Negli ultimi anni, molti appassionati italiani hanno cercato un portale capace di coniugare sicurezza, varietà e rapidità nelle transazioni. In questo panorama, 22bet casino si distingue per un catalogo vasto e per la fluidità dell’esperienza, sia per chi punta ai tavoli live sia per chi preferisce jackpot progressivi. La navigazione è ordinata, le pagine di aiuto sono chiare e la registrazione richiede pochi minuti. Gli utenti più esigenti apprezzano inoltre la trasparenza sulle promozioni e l’attenzione alla responsabilità, aspetti cruciali per godersi il gioco in modo consapevole e sostenibile.
Per valutare con attenzione strumenti, limiti personalizzabili e calendario delle offerte, puoi visitare il sito ufficiale di 22Bet, dove ogni sezione illustra procedure, tempistiche e canali di supporto. L’interfaccia di 22bet casinò favorisce un accesso rapido a giochi, pagamenti e impostazioni dell’account, con filtri utili per trovare in pochi secondi ciò che realmente interessa. Grafica pulita, categorie ben definite e schede informative sui titoli rendono l’esperienza adatta tanto ai principianti quanto ai giocatori più esperti.
L’area di accesso è costruita per essere semplice e protetta: la procedura di 22bet login richiede credenziali essenziali e può essere rafforzata con metodi di verifica aggiuntivi. Una volta dentro, il pannello personale consente di monitorare saldo, storico delle giocate, documenti caricati e limiti impostati. Le notifiche aiutano a non perdere promozioni o tornei imminenti, mentre i promemoria sul gioco responsabile restano sempre a portata di mano.
Chi preferisce giocare in mobilità trova nella 22bet app un alleato pratico: l’ottimizzazione per schermi diversi rende immediato l’uso di funzioni chiave, dal deposito al ritiro, senza rinunciare a stabilità e velocità. Le performance sono costanti anche in presenza di connessioni non perfette, e l’interfaccia touch-first consente gesti rapidi per cambiare tavolo, filtrare categorie o consultare informazioni su quote e regolamenti.
Per gli amanti delle bobine, il catalogo dedicato alle 22bet slot include titoli classici a tre rulli, video slot con funzioni speciali e meccaniche innovative. Ogni scheda gioco indica volatilità, range di puntata e eventuali modalità bonus, utili per calibrare la propria strategia. È consigliabile sperimentare versioni demo quando disponibili, in modo da comprendere ritmo, frequenza delle combinazioni vincenti e impatto delle feature.
Il tema promozionale è gestito con chiarezza: le pagine dedicate a 22bet bonus spiegano criteri di idoneità, requisiti di puntata, scadenze e limiti massimi, così da evitare fraintendimenti. Prima di aderire, conviene leggere con attenzione ogni clausola, verificare i contributi dei diversi giochi verso il wagering e impostare un budget coerente con i propri obiettivi. Un approccio metodico aiuta a trasformare i vantaggi in opportunità reali.
Non manca il versante sportivo: con 22bet scommesse gli utenti trovano mercati principali e secondari, statistiche utili e aggiornamenti in tempo reale. Chi desidera un’unica piattaforma per gioco e quote può contare sulla coerenza di interfaccia e portafoglio unificato. All’interno dell’ecosistema 22bet, l’integrazione tra sezioni facilita passaggi rapidi senza smarrire configurazioni personali, limiti o preferenze di notifica.
- Imposta un budget personale e rispetta i tuoi limiti.
- Controlla sempre i requisiti di puntata prima di attivare una promozione.
- Sfrutta gli strumenti di autolimitazione e le pause programmate.
- Valuta RTP e volatilità per scegliere i giochi più adatti al tuo stile.
- Consulta regolamenti, probabilità e orari dell’assistenza prima di iniziare.
| Sezione | Contenuto | Punti di forza |
|---|---|---|
| Giochi da tavolo | Blackjack, roulette, baccarat, poker live | Croupier dal vivo, limiti flessibili, tavoli multipli |
| Slot | Classiche, video, jackpot progressivi | Filtri per provider, funzioni bonus, demo disponibili |
| Promozioni | Benvenuto, cashback, tornei periodici | Termini esposti con chiarezza, calendario aggiornato |
| Pagamenti | Carta, e-wallet, bonifico | Tempi trasparenti, tracciabilità e limiti configurabili |
| Assistenza | Chat, email, sezione FAQ | Risposte rapide, guide dettagliate, risorse educative |
Guida ragionata per scegliere piattaforme di gioco e sport online
Il panorama del gioco online in Italia evolve rapidamente, e chi desidera divertirsi in modo responsabile ricerca parametri oggettivi per valutare affidabilità e qualità del servizio. Oltre all’intrattenimento, contano soprattutto licenze valide, trasparenza delle condizioni, strumenti di autolimitazione e canali di supporto tempestivi. Gli utenti più attenti confrontano cataloghi sportivi, giochi da tavolo, proposte con croupier dal vivo e titoli a rulli, cercando interfacce chiare, processi semplici e pagamenti veloci. Prima di aprire un conto, conviene esaminare payout, metodi accettati, tempi di prelievo, compatibilità su dispositivi mobili e politiche di tutela del consumatore.
Tra i marchi spesso citati dagli appassionati, betaland emerge per impaginazione pulita e organizzazione coerente delle sezioni. Chi valuta le offerte introduttive presta massima attenzione al betaland bonus, interpretando con calma i requisiti di puntata, i contributi dei giochi, le tempistiche di sblocco e gli eventuali massimali. Una lettura accurata delle regole aiuta a pianificare il budget, ad evitare fraintendimenti e a impostare obiettivi realistici, ricordando che una promozione è utile solo se coerente con le proprie abitudini di spesa e con il tempo che si intende dedicare al passatempo digitale.
Prima di iscriversi, può essere saggio consultare schede comparative, guide verificate e aggiornamenti normativi. Per un quadro sintetico su novità, promozioni stagionali e buone pratiche di sicurezza, molti lettori visitano il portale informativo ufficiale betaland.eu.com, dove trovano anche rimandi al gioco responsabile, spiegazioni sui limiti di deposito e suggerimenti per la protezione dell’account. Elaborare un piano di spesa, monitorare le sessioni e utilizzare gli strumenti di controllo disponibili rende l’esperienza più serena e sostenibile, riducendo il rischio di decisioni impulsive.
L’utilizzo da dispositivi portatili è ormai centrale: la betaland app, quando presente e aggiornata, permette di verificare rapidamente mercati live, consultare lo storico movimenti e gestire versamenti in pochi passaggi. È importante controllare stabilità, consumo dati, notifiche e la chiarezza dei menù, così da muoversi con fluidità. L’accesso al profilo, tramite betaland login, dovrebbe integrare l’autenticazione a due fattori e procedure di recupero credenziali ben descritte; la protezione dell’account passa anche da password robuste, aggiornamenti periodici e dall’attenzione ai dispositivi utilizzati.
Sul fronte sportivo, la sezione betaland scommesse attrae chi desidera quote competitive e mercati su molte discipline, con schede evento complete e filtri per tipologia di giocata. Analizzare statistiche, trend e regolamenti specifici dei mercati aiuta a prendere decisioni più consapevoli. Per chi ama carte e tavoli, l’area betaland casino offre alternative di intrattenimento con regole intuitive e varianti a difficoltà crescente; conviene valutare interfacce, limiti minimi e massimi, oltre alla presenza di tutorial interni che favoriscano un ingresso graduale per i meno esperti.
Gli appassionati di rulli esaminano il catalogo betaland slot prestando attenzione a volatilità, frequenza delle vincite, funzioni bonus e RTP comunicato dai provider, così da selezionare titoli in linea con il proprio stile. Infine, chi cerca ambienti dal vivo e interazione in tempo reale apprezza l’atmosfera di betaland casinò, dove qualità dello streaming, rapidità del dealer e chiarezza delle puntate minime contribuiscono a un’esperienza ricca. In ogni caso, la priorità rimane mantenere controllo sul tempo trascorso e impostare limiti coerenti con le proprie possibilità.
- Verificare la presenza di licenza valida e informazioni societarie chiare.
- Controllare limiti, autoesclusione, cronologia sessioni e strumenti di autogestione.
- Confrontare payout, varietà di mercati e profondità dei cataloghi di gioco.
- Valutare metodi di pagamento, tempi medi di accredito e costi applicati.
- Testare interfaccia, stabilità mobile, tempi di risposta dell’assistenza.
| Aspetto | Dettagli da controllare |
|---|---|
| Licenza e sicurezza | Numero di licenza ADM, crittografia TLS, gestione dei dati personali. |
| Bonus e promozioni | Requisiti di puntata, giochi qualificanti, scadenze e massimali. |
| App e versione mobile | Compatibilità iOS/Android, stabilità, notifiche e consumo dati. |
| Pagamenti | Carte, e-wallet, bonifici; tempi di prelievo e eventuali commissioni. |
| Supporto clienti | Chat live, email e telefono; orari di servizio e qualità delle risposte. |
Guida completa all’esperienza di gioco e scommesse online
Se desideri una panoramica chiara sul funzionamento dei principali operatori italiani, sulle promozioni e sugli strumenti dedicati alla protezione dell’utente, puoi visitare il portale di Betaland, dove vengono presentate sezioni informative, regole dettagliate, metodi di ricarica e consigli utili per pianificare responsabilmente il tuo intrattenimento digitale.
Negli ultimi anni il mercato ha visto crescere rapidamente il numero di proposte, e il marchio betaland si è distinto per un’interfaccia ordinata, quote aggiornate con frequenza e un’attenzione concreta al gioco responsabile, con limiti personalizzabili, strumenti di autoesclusione e guide semplici che aiutano i giocatori a muovere i primi passi senza perdere di vista il proprio budget.
Per gli appassionati di pronostici sportivi, la sezione betaland scommesse offre un palinsesto ampio su calcio, tennis, basket e motori, insieme a mercati speciali su statistiche, combo e risultati parziali; l’aggiornamento live consente di seguire l’andamento degli eventi in tempo reale e di scegliere linee alternative per gestire il rischio in base a ritmo, possesso e forma delle squadre.
Chi preferisce i giochi da tavolo troverà nell’area betaland casino un assortimento che spazia da roulette europee e americane a varianti di blackjack e baccarat, con tavoli live gestiti da croupier professionisti e limiti flessibili; l’ambiente è progettato per offrire fluidità, grafica pulita e controlli rapidi, così da ridurre le attese tra una mano e l’altra.
Gli amanti delle slot possono esplorare titoli classici e innovativi all’interno del catalogo betaland slot, che raggruppa temi mitologici, avventure urbane, frutta retrò e meccaniche con rulli espansi o acquisto del bonus; ogni scheda illustra volatilità, RTP indicativo e funzioni speciali, facilitando il confronto prima di avviare la sessione.
- Imposta un budget settimanale e rivedilo periodicamente in base ai risultati.
- Consulta le statistiche pre-partita e i report sulla forma recente prima di piazzare una quota.
- Prova le versioni demo quando disponibili per comprendere le regole senza rischi.
- Utilizza i limiti di deposito e la cronologia per monitorare il tempo trascorso online.
- Interrompi la sessione se noti cali di concentrazione o rincorsa delle perdite.
Per la mobilità, la betaland app concentra le funzioni principali in un’interfaccia ottimizzata: ricerca rapida degli eventi, filtri per campionati, panoramiche sui tavoli live e notifiche configurabili; la sincronizzazione dell’account permette di riprendere la schedina iniziata da desktop, mentre i percorsi ridotti migliorano la velocità di esecuzione anche con connessioni non perfette.
| Funzionalità | Dettagli |
|---|---|
| Quote e mercati | Palinsesto esteso con eventi pre-match e live, mercati speciali e linee alternative. |
| Giochi da casinò | Roulette, blackjack, baccarat, game show dal vivo e varianti con limiti differenziati. |
| Pagamenti | Metodi diffusi in Italia, tempi di accredito chiari e riepiloghi trasparenti dei movimenti. |
| Promozioni | Offerte periodiche con requisiti esplicitati, riepilogo dei progressi e scadenze. |
| Supporto | Canali dedicati con orari pubblicati, FAQ per le domande più comuni e tutorial di base. |
Nell’area promozioni, la dicitura betaland bonus contraddistingue iniziative con regole esposte in modo lineare: oltre al valore nominale, vengono specificati i requisiti di puntata, i giochi idonei, le finestre temporali e gli eventuali tetti di conversione, così da chiarire sin dall’inizio come ottimizzare il vantaggio senza fraintendimenti.
Per l’accesso, la procedura betaland login è pensata per favorire sicurezza e rapidità: credenziali robuste, verifica a più fattori quando disponibile, recupero guidato in caso di smarrimento e promemoria sulle buone pratiche riducono il rischio di errori; dopo l’autenticazione, la dashboard mostra saldo, limiti attivi e scorciatoie verso le sezioni più usate.
Se preferisci l’atmosfera da sala reale, l’offerta live collegata a betaland casinò propone tavoli con dealer professionisti, chat moderata e inquadrature multiple, così da mantenere ritmo e trasparenza; ricordati tuttavia che la qualità dell’esperienza dipende anche dalla stabilità della connessione e dall’adozione di pause regolari.
Panoramica su scommesse, casinò online e buone pratiche per un gioco consapevole
Il mercato italiano del gioco online cresce nel solco delle norme ADM, che impongono controlli d’identità, protocolli anti-frode e strumenti di autolimitazione. Chi cerca intrattenimento valuta fluidità dell’interfaccia, chiarezza delle quote e velocità dei pagamenti. RNG certificati, audit indipendenti e assistenza multicanale contribuiscono a un’esperienza trasparente, mentre un approccio responsabile prevede budget predefiniti, pause regolari e consapevolezza statistica sui prodotti scelti.
Per una panoramica su prodotti, regole e promozioni dell’operatore, è possibile informarsi consultando le pagine ufficiali: visita Betclic e verifica sempre termini, limiti, requisiti documentali e pratiche di gioco responsabile prima di completare la registrazione o depositare fondi.
Sul fronte sportivo, il palinsesto include campionati italiani, coppe europee e mercati su tennis, basket e motori, con live betting, cash out e statistiche. La proposta riconducibile a betclic scommesse punta su aggiornamento rapido delle quote e combinazioni flessibili per le multiple, ricordando l’importanza di proteggere il bankroll e di rispettare i propri limiti di spesa.
L’esperienza mobile è centrale per giocare in movimento: la betclic app consente gestione del conto, notifiche su variazioni di quota, ricariche e prelievi sicuri. Per accedere, la procedura di betclic login supporta PIN, autenticazione a due fattori e biometria; è buona prassi cambiare password periodicamente, chiudere le sessioni inattive e attivare avvisi di sicurezza sull’account.
Nel segmento dei giochi, la sezione betclic casino riunisce tavoli con croupier, roulette, blackjack e game show in HD. Filtri per volatilità e meccaniche aiutano a orientarsi; chi preferisce i rulli trova selezioni tematiche e funzioni speciali. Spiccano le betclic slot con jackpot e round bonus, utili da provare in demo per comprenderne ritmo e payout.
| Area | Funzioni principali | Note utili |
|---|---|---|
| Scommesse sportive | Live betting, cash out, statistiche, costruzione multiple | Quote soggette a variazioni; streaming disponibile su eventi selezionati |
| Casinò e Live | Roulette, blackjack, baccarat, game show | Limiti tavolo variabili; sessioni live in fasce orarie estese |
| Pagamenti | Carta, e-wallet, bonifico, voucher | Tempi di accredito differenziati; verifica KYC obbligatoria |
| Sicurezza e supporto | 2FA, crittografia TLS, chat, email, FAQ | Storico ticket e tempi medi di risposta consultabili nell’area personale |
Le promozioni meritano lettura attenta: il pacchetto di benvenuto denominato betclic bonus può includere rimborso percentuale, free spin o scommesse gratuite, sempre con requisiti e scadenze. Le iniziative periodiche del betclic casinò, tra tornei a classifica e missioni settimanali, specificano contributi dei giochi al wagering, massimali di puntata e finestre temporali, elementi chiave per valutarne la convenienza.
- Definisci un budget massimo e non superarlo.
- Imposta limiti di deposito, perdita e tempo di sessione.
- Consulta RTP e volatilità dei giochi prima di puntare.
- Non inseguire le perdite; fai pause regolari.
- Usa metodi di pagamento con 3D Secure e verifica in due passaggi.
- Aggiorna app e sistema operativo; evita reti Wi‑Fi pubbliche.
- Scarica estratti conto periodici per monitorare attività e spese.
- Contatta l’assistenza o attiva l’autoesclusione in caso di necessità.
Nel complesso, la reputazione di betclic dipende da trasparenza informativa, puntualità nei pagamenti, qualità del supporto e chiarezza dei regolamenti. Recensioni indipendenti, community e report di enti certificatori aiutano a formare un’opinione; resta fondamentale mantenere un approccio consapevole, usare gli strumenti di autolimitazione e considerare il gioco come svago misurato.
Guida pratica ai casinò online, bonus e buone abitudini per giocatori consapevoli
Nel panorama dei casinò online, gli appassionati cercano piattaforme affidabili, regolamentate e semplici da usare, con interfacce rapide, un buon catalogo di giochi e strumenti di autolimitazione. Tra i nomi che attirano curiosità c’è ninewin casino, citato spesso nelle discussioni su bonus e user experience. Prima di scegliere, è essenziale valutare licenza, trasparenza promozionale, qualità dell’assistenza e tempi di pagamento. Un approccio informato riduce il rischio di delusioni, massimizza il divertimento e sostiene pratiche di gioco responsabile.
Le procedure di iscrizione e accesso meritano attenzione. Alcuni operatori adottano verifiche in più passaggi, richiedendo documenti e controlli di età per evitare abusi. In questo contesto si parla di ninewin login come esempio di ingresso rapido ma sicuro, con autenticazione e recupero credenziali chiari; allo stesso tempo, chi preferisce entrare direttamente nella sezione dedicata può incontrare il percorso indicato come ninewin casino login, utile per passare subito dai titoli provati alle nuove uscite e alle promozioni attive.
Il mercato del Regno Unito è tra i più maturi e rigorosi; conviene verificare il posizionamento di ogni brand rispetto a requisiti locali, controlli di solvibilità e limiti di deposito. Nel dibattito compare talvolta la formula ninewin uk a indicare funzioni o condizioni rivolte al pubblico britannico, inclusi orari del supporto e valute accettate. Chi accede con credenziali già create potrebbe imbattersi in percorsi denominati ninewin uk login, dove l’attenzione è posta su KYC, antiriciclaggio e informativa chiara su spesa e autoesclusione.
Parlando di offerte e cataloghi nel Regno Unito, alcuni forum menzionano espressioni come ninewin casino uk nel confronto con alternative presenti sul territorio. Per orientarti senza farti distrarre da slogan, definisci un metodo oggettivo: analizza varietà dei giochi, stabilità tecnica, chiarezza del payout e efficienza del servizio clienti. Se l’obiettivo è trovare il marchio ninewin in contesti informativi, confronta fonti indipendenti per distinguere opinioni da dati verificabili, specie quando si citano percentuali di ritorno al giocatore.
Le promozioni vanno lette con attenzione: termini di puntata, scadenze e giochi qualificanti incidono sul valore reale. Capita di vedere citazioni di ninewin promo code come presunto accesso a vantaggi speciali, oppure riferimenti a ninewin bonus code in guide e blog; allo stesso modo, l’espressione ninewin free spins ricorre in discussioni su giri gratuiti e pacchetti di benvenuto. Prima di attivare un’offerta, valuta i requisiti di wagering, l’impatto sui limiti personali e l’eventuale compatibilità con depositi minimi.
Per una visione d’insieme che non si limiti a un singolo brand, consulta risorse comparative, report regolatori e recensioni tecniche. Verifica latenza dei giochi live, qualità dei provider, trasparenza del cashback e canali di assistenza. Per un confronto indipendente e aggiornato tra bonus, metodi di pagamento e strumenti di tutela del giocatore, puoi visitare https://planetwin-casino.com/, dove molte guide ricordano l’importanza di leggere le note legali e impostare limiti sostenibili prima di giocare.
| Caratteristica | Dettagli utili alla valutazione |
|---|---|
| Licenze e conformità | Presenza di licenza riconosciuta, controlli KYC, politiche antiriciclaggio e audit periodici. |
| Metodi di pagamento | Carta, bonifico, e-wallet; limiti di deposito/prelievo e tempi medi di accredito. |
| Tipi di gioco | Slot, jackpot, tavoli RNG, live casino, giochi istantanei e provider certificati. |
| Termini dei bonus | Wagering, contributi per tipologia di gioco, scadenze e puntata massima consentita. |
| Assistenza e sicurezza | Chat live, e-mail, FAQ dettagliate; crittografia SSL e strumenti di autolimitazione. |
- Verifica la licenza e la reputazione tramite enti indipendenti e feedback documentati.
- Leggi sempre termini e condizioni dei bonus, con attenzione a wagering e scadenze.
- Prova i giochi in modalità demo per valutare interfaccia, volatilità e stabilità tecnica.
- Imposta limiti di deposito e sessione; usa l’autoesclusione se necessario.
- Proteggi le credenziali con password robuste e, se disponibile, autenticazione a due fattori.
Guida pratica ai casinò online: orientarsi tra bonus, accessi e giochi
Nell’universo dei casinò online, la scelta del portale giusto passa da alcuni pilastri: affidabilità della piattaforma, trasparenza delle promozioni, chiarezza delle procedure di registrazione e varietà del catalogo giochi. Molti utenti cercano esperienze fluide, con interfacce semplici, pagamenti rapidi e un’assistenza che risponda in tempi certi. In parallelo, è diventato essenziale comprendere come leggere i termini di un bonus, distinguere le meccaniche di wagering e valutare la compatibilità con i propri obiettivi, siano essi divertimento occasionale o sessioni più strutturate.
Tra i nomi spesso discussi dalle community di appassionati compare ninewin casino, citato per la struttura promozionale, i tornei a tempo e la presenza di slot con volatilità differenti. Prima di iscriversi, conviene analizzare i dettagli operativi: limiti di deposito, tempistiche dei prelievi, eventuali limiti alla progressione dei livelli VIP e disponibilità di strumenti di gioco responsabile. Un attento confronto tra i principali operatori aiuta a individuare la soluzione più coerente con le proprie abitudini.
Per la gestione dell’account, i portali seri separano chiaramente le funzioni di accesso e recupero credenziali, con autenticazioni a due fattori e notifiche di sicurezza. In molti casi esiste una pagina dedicata denominata ninewin login, pensata per centralizzare l’accesso su dispositivi diversi. Parallelamente, chi preferisce la sezione desktop del portale principale può imbattersi nel collegamento specifico ninewin casino login, utile per chi naviga partendo dall’homepage e desidera entrare direttamente nella parte dedicata ai giochi.
Le offerte cambiano nel tempo: bonus di benvenuto, cashback su perdite nette, tornei con montepremi, lotterie e missioni settimanali. Alcune promozioni richiedono l’inserimento di un identificativo come ninewin promo code, da digitare al momento dell’iscrizione o del primo deposito; in altri casi, la pagina prevede un campo alternativo indicato come ninewin bonus code, utile per sbloccare vantaggi specifici. Controlla sempre i termini: rollover, puntate massime, scadenze e titoli idonei incidono concretamente sul valore effettivo dell’offerta.
La localizzazione gioca un ruolo chiave nella conformità normativa e nella personalizzazione della proposta commerciale. Nel contesto britannico, ad esempio, si trovano sezioni dedicate come ninewin uk, con regolamenti e linee guida coerenti con gli standard locali. Le procedure di accesso possono passare da un percorso mirato, indicato come ninewin uk login, che tiene conto dei requisiti di verifica più stringenti. Anche le campagne e i cataloghi possono differire su pagine identificate come ninewin casino uk, riflettendo licenze e partnership con provider certificati.
Sul fronte delle meccaniche promozionali, molti utenti valutano con interesse pacchetti che includono giri gratuiti, cashback a scalare e classifiche con punti accumulabili. In particolare, alcuni confronti tra operatori citano bundle come ninewin free spins, evidenziandone limiti di puntata, titoli partecipanti e modalità di accredito. La qualità reale dell’incentivo dipende spesso dall’equilibrio tra quota di rischio, scadenze e requisiti di sblocco.
Per avere un quadro sintetico delle funzioni che spesso interessano ai giocatori informati, consulta la seguente tabella: ti aiuterà a valutare rapidamente i fattori chiave prima dell’iscrizione o di un cambio di piattaforma.
| Caratteristica | Descrizione | Valore indicativo |
|---|---|---|
| RTP medio | Rendimento teorico medio sulle slot più popolari | 95% – 97% |
| Tipi di bonus | Benvenuto, ricarica, cashback, giri gratuiti, tornei | Variabile, con termini dedicati |
| Metodi di pagamento | Carta, wallet digitali, bonifico, voucher | Accredito da istantaneo a 3 giorni lavorativi |
| Assistenza | Chat live, email, sezione FAQ, ticket | Copertura 16/7 o 24/7 |
| Strumenti di controllo | Limiti di deposito, autoesclusione, reality check | Configurabili dall’area personale |
Se vuoi struttura e metodo nelle tue sessioni, adotta alcune buone pratiche che riducono la variabilità e ti aiutano a leggere correttamente le promozioni, evitando fraintendimenti comuni.
- Imposta un budget settimanale e rivedilo in base ai risultati e al tempo disponibile.
- Controlla sempre wagering, puntata massima e scadenza prima di attivare un bonus.
- Prova le versioni demo per valutare volatilità, frequenza dei pagamenti e meccaniche speciali.
- Diversifica tra slot, tavoli live e giochi istantanei per bilanciare rischio e intrattenimento.
- Verifica i limiti di prelievo, la documentazione KYC richiesta e le tempistiche.
- Utilizza gli strumenti di gioco responsabile e pianifica pause regolari durante le sessioni.
Per un confronto informato tra bonus, cataloghi e strumenti di tutela, puoi dare uno sguardo anche a
Planetwin, così da valutare differenze concrete in termini di termini promozionali, fluidità dell’interfaccia e tempistiche di assistenza.
In definitiva, l’approccio migliore è costruire una checklist personale e aggiornarla nel tempo, considerando novità e regolamenti. Un marchio come ninewin, o qualunque altro operatore di riferimento, andrebbe sempre valutato in relazione alle tue priorità: chiarezza dei termini, rapidità dei pagamenti, qualità del catalogo, efficacia dell’assistenza e coerenza con il tuo stile di gioco responsabile.
Guida orientativa ai casinò online: sicurezza, bonus e funzionalità
Nel panorama in rapida evoluzione del gioco a distanza, gli appassionati cercano piattaforme affidabili con cataloghi ampi e pagamenti trasparenti. Fra i marchi discussi, ninewin casino viene spesso confrontato con alternative nazionali e internazionali; parallelamente, il nome ninewin ricorre nei forum quando si parla di interfaccia chiara, termini comprensibili e strumenti di tutela. Prima dell’iscrizione è decisivo verificare licenze, reputazione e supporto.
Il primo contatto passa dall’area di registrazione e dall’accesso quotidiano. In alcune guide si cita ninewin login come esempio di percorso con conferma e-mail, verifica identità e limiti personali. Un flusso lineare, con recupero credenziali e autenticazione a due fattori, riduce errori e rischi.
Le promozioni richiedono attenzione. L’etichetta ninewin promo code viene associata a pacchetti di benvenuto o iniziative periodiche; allo stesso modo, la formula ninewin bonus code può riferirsi a incentivi legati a eventi o categorie di gioco. È fondamentale valutare requisiti di puntata, scadenze, giochi ammessi e valore reale dell’offerta.
Guardando ai mercati esteri, alcuni confronti esplorano differenze normative e di servizio. L’espressione ninewin uk appare quando si analizzano cataloghi e metodi di pagamento locali; in parallelo, ninewin uk login viene menzionata per descrivere procedure d’accesso con controlli aggiuntivi richiesti dagli organismi di vigilanza del Regno Unito.
I giri gratuiti sono molto richiesti. Il riferimento ninewin free spins indica slot selezionate con condizioni predefinite, per esempio massimali di vincita e scadenze. La trasparenza su valore dei giri, requisito di rigioco ed elenco dei titoli ammessi resta l’aspetto cruciale.
Per l’accesso diretto a slot e tavoli, talvolta si trova la dicitura ninewin casino login nei manuali informativi. Qui contano stabilità tecnica, sessioni sicure, misure antiphishing e supporto tempestivo. Pagine rapide e centri assistenza tracciabili semplificano la risoluzione dei problemi.
La presenza internazionale comporta versioni localizzate; non è raro incontrare ninewin casino uk in pagine di confronto fra portali con licenze diverse. È utile valutare compatibilità normativa, metodi di pagamento in euro, verifica dell’identità e canali di tutela per eventuali controversie.
Per un quadro più ampio, molti confrontano flussi di registrazione, chiarezza promozionale e tempi di incasso con quanto proposto da Planetwin, così da individuare buone pratiche e possibili miglioramenti, prima di impegnarsi su una piattaforma e gestire un budget responsabile.
| Aspetto | Buone pratiche | Cosa controllare |
|---|---|---|
| Licenza e conformità | Concessione valida e verifiche indipendenti | Numero di licenza, ente regolatore, politiche di gioco responsabile |
| Pagamenti | Metodi diffusi e tempi trasparenti | Tempi medi di prelievo, commissioni, limiti per operazione |
| Verifica identità (KYC) | Procedure chiare e rapide | Documenti richiesti, protezione dati, assistenza in italiano |
| Promozioni | Termini sintetici e visibili sul sito | Requisiti di puntata, contributo dei giochi, scadenze |
| Giochi e software | Provider affidabili e RTP dichiarato | Varietà di slot e tavoli, limiti di puntata, strumenti demo |
- Imposta un budget e usa limiti automatici di deposito.
- Leggi sempre i termini delle offerte prima di aderire.
- Attiva l’autenticazione a due fattori sugli accessi.
- Prova le versioni demo per capire volatilità e regole.
- Conserva ricevute di movimenti e verifica eventuali commissioni.
- Interrompi il gioco se superi i limiti prefissati.
Guida completa ai casinò online: accesso, bonus e buone pratiche
Nel mercato italiano dei casinò online, molti giocatori cercano piattaforme solide e trasparenti; tra queste, ninewin casino viene spesso citato per la varietà di giochi e l’attenzione all’esperienza dell’utente. Prima di aprire un conto, è utile valutare la qualità dell’interfaccia, la chiarezza delle pagine informative su termini e condizioni, e la presenza di strumenti di tutela. Un sito ben progettato riduce gli errori in fase di deposito, permette di configurare limiti personalizzati e rende più facile comprendere il funzionamento dei bonus. È altrettanto importante esaminare la reputazione presso community indipendenti, verificare la licenza, e controllare la disponibilità di metodologie di pagamento affidabili e tempestive per evitare rallentamenti nelle operazioni di prelievo.
Per chi si iscrive per la prima volta, conviene conoscere le procedure di accesso: con ninewin login si passa rapidamente dal profilo alla lobby, mentre con ninewin casino login si gestiscono le credenziali e i controlli di sicurezza integrati. Alcuni operatori adottano l’autenticazione a due fattori, che può includere l’uso di codici temporanei per tenere al sicuro il conto. Ricorda di aggiornare periodicamente la password e di non condividerla mai con terzi, così da limitare i rischi. La sezione dedicata al profilo dovrebbe consentire di monitorare cronologia delle transazioni, bonus attivi e limiti impostati; se noti incongruenze, contatta subito l’assistenza per chiarire ogni dettaglio prima di effettuare ulteriori puntate.
Le promozioni non vanno prese alla leggera: leggere T&C associati al ninewin promo code e al ninewin bonus code aiuta a evitare sorprese. Alcune offerte includono pacchetti con ninewin free spins, che possono sembrare generosi ma spesso prevedono requisiti di puntata, limiti di conversione e scadenze precise. Un metodo efficace è confrontare l’ammontare reale sbloccabile basato su wagering, contributo dei giochi e puntate massime consentite. Quando possibile, suddividi il saldo bonus in sessioni e obiettivi misurabili, evitando di concentrare tutto su un’unica giocata ad alta varianza. Questa disciplina permette di mantenere sotto controllo il bankroll e di ottenere un quadro realistico del valore delle promozioni nel medio periodo.
Chi viaggia o risiede oltreconfine dovrebbe verificare le differenze regolamentari: il servizio etichettato come ninewin uk segue standard specifici e, a seconda della giurisdizione, l’accesso tramite ninewin uk login può richiedere procedure di verifica aggiuntive; anche il catalogo del marchio su ninewin casino uk può presentare titoli e limiti diversi. Tali variazioni possono riguardare provider, payout pubblicati e disponibilità di strumenti di gioco responsabile. Prima di effettuare depositi, controlla sempre i metodi di pagamento abilitati nella località corrente, le valute supportate e le eventuali commissioni su transazioni internazionali. Inoltre, prendi nota delle policy su autoesclusione e periodi di sospensione, che possono differire in base al regolatore competente e all’implementazione tecnica del sito.
Prima di cominciare a scommettere, è utile creare una breve checklist personale con punti chiave da spuntare per ogni piattaforma che desideri provare.
- Definisci un budget settimanale e imposta limiti di deposito congrui al tuo profilo di rischio.
- Confronta RTP, volatilità e linee di pagamento dei giochi che preferisci.
- Leggi requisiti di puntata, scadenze dei bonus e massimali di vincita convertibile.
- Testa le versioni demo quando disponibili per capire ritmo e variabilità del titolo.
- Attiva strumenti di gioco responsabile: promemoria di sessione, autoesclusione, time-out.
Per orientarti tra caratteristiche e offerte, la seguente tabella riassume le aree più importanti da controllare prima di finalizzare la registrazione o riscattare un bonus.
| Caratteristica | Perché conta | Cosa verificare |
|---|---|---|
| Bonus di benvenuto | Ampliano il saldo iniziale se ben gestiti | Wagering, contributo dei giochi, scadenze |
| Slot e jackpot | Adattano volatilità e ritmo al tuo stile | RTP reali, provider certificati, limiti |
| Live casino | Esperienza immersiva con croupier reali | Stabilità streaming, tavoli disponibili, limiti |
| Pagamenti | Transazioni rapide e trasparenti | Commissioni, tempi di prelievo, requisiti KYC |
| Assistenza | Supporto tempestivo per risolvere problemi | Orari, canali, qualità delle risposte |
Se desideri confrontare approcci e stili diversi, puoi dare uno sguardo anche a Planetwin, così da valutare come differenti operatori impostino bonus, librerie di giochi e strumenti di tutela dell’utente, inclusi limiti, informative chiare e processi di verifica.
Nel complesso, ninewin ha costruito una reputazione tra gli appassionati che apprezzano chiarezza, strumenti di protezione e un’offerta bilanciata tra slot, tavoli e live. Ricorda tuttavia che nessun bonus sostituisce una gestione responsabile del bankroll: pianifica sessioni brevi, monitora risultati e interrompi il gioco quando non è più divertente. Confronta sempre più piattaforme, leggi le condizioni in modo critico e privilegia quelle che dimostrano trasparenza operativa, sicurezza dei dati e tempi di risposta rapidi del supporto clienti.
Kazino ceļvedis Latvijas spēlētājiem: izvēle, bonusi un atbildīga spēle
Latvijas tiešsaistes izklaides vidē piedāvājums ir plašs, un gudri spēlētāji sāk ar rūpīgu atlasi: licence, uzraudzība, maksājumu drošība un pārskatāmi noteikumi. Daudzi vērtē arī spēļu klāstu, kur galveno lomu ieņem populāri nosaukumi un pazīstami pakalpojumu sniedzēji. Atslēgvārds 11.lv spēļu automāti bieži parādās diskusijās starp pieredzējušiem spēlētājiem, jo viņi meklē ne vien krāsainu dizainu, bet arī stabilu RTP, skaidras izmaksu līnijas un papildu funkcijas. Svarīgi ir arī reālistiski nospraust budžetu, izmantot limitus un regulāri izvērtēt savus ieradumus, lai izklaide saglabātu līdzsvaru ar atbildīgu pieeju.
Jauniem dalībniekiem īpaši interesē, kā optimāli sākt, un te būtisku lomu spēlē dažādi piedāvājumi. Mekējot piekļuvi kampaņām, nereti tiek ievadīts 11.lv bonusa kods, jo tas var atslēgt papildus naudas līdzekļus, griezienus vai biļetes turnīriem. Līdzīgā veidā lietotāji skatās, vai noteikumi nosaka asu atšķirību starp skaidras naudas un bonusa bilancēm, kādus apgrozījuma sliekšņus un termiņus piemēro, kā arī vai noguldījuma metodes ietekmē atbilstošos labumus. Gudri ir pārbaudīt noteikumus, jo ne visi brīvpiedāvājumi vienādi iederas dažādos spēļu stilos un budžetos.
Terminoloģija un meklēšanas frāzes dažkārt atšķiras, un spēlētāji pielāgojas. Daļa izmanto starptautisku apzīmējumu, piemēram, 11.lv casino, lai salīdzinātu starpvalstu piedāvājumu prezentāciju, citi priekšroku dod vietējai valodai un saka 11.lv kazino, kas uzsver latvisko aprakstu, valūtu un atbalsta pieejamību. Turklāt sastopami arī alternatīvi meklējumi kā 11 lv casino un 11 lv kazino, kur akcents tiek likts uz līdzīgu zīmola nosaukuma rakstību bez punkta, lai gan būtība lietotājam nemainās: pārskatāma izvēlne, kvalitatīvas spēles un ērti maksājumi.
Runājot par reklāmas kodiem, svarīgi atcerēties, ka dažādās kampaņās var figurēt līdzīgas frāzes. Bieži vien spēlētāji ieraksta 11 lv bonusa kods, cerot atrast pašreizējo piedāvājumu, tomēr vienmēr ir jāpārbauda noteikumi oficiālajā lapā un jāatsvaidzina informācija, jo akcijas mainās. Dažkārt īpaši intriģē tieši 11 lv free spins iespējas, kas sniedz iespēju izpētīt jaunas spēles ar zemākiem riskiem, taču arī šeit jāpievērš uzmanība apgrozījumam un limitētām spēlēm, kurās bezmaksas griezieni ir derīgi.
Izvērtējot zīmolu atpazīstamību un reputāciju, daži izmanto vienkāršotu meklējumu 11 lv, lai redzētu, vai parādās uzticami avoti, atsauksmes un neatkarīgas apskata lapas. Līdztekus oficiālajiem resursiem noderīgi ir arī izglītojoši ceļveži un salīdzinājumi. Piemēram, šeit minētais 11 Lv var kalpot kā sākuma punkts, lai lasītājs strukturēti pārskatītu biežāk sastopamās funkcijas, noteikumu nianses un drošības aspektus. Un, protams, jebkuras izvēles pamatā paliek skaidrs budžets un godīga attieksme pret risku.
Lai iegūtu pilnīgāku priekšstatu par piedāvājumu un vilinošajiem virsrakstiem, vienmēr jāpievērš uzmanība detaļām. Ne visi piedāvājumi ir vienādi vērtīgi, un dažkārt populārākās meklēšanas frāzes, tostarp 11.lv, tiek izmantotas plašās reklāmas kampaņās. Salīdziniet procentu likmes, piedalieties turnīros tikai tad, ja noteikumi ir saprotami, un vērtējiet klientu atbalsta kvalitāti. Turklāt nepārvērtējiet bonusa apjomu: dažreiz zemāks apgrozījums un elastīgāki nosacījumi ir daudz vērtīgāki par iespaidīgām, taču ierobežojošām summām.
- Pārbaudiet licenci, operatora reputāciju un neatkarīgus auditus.
- Izprotiet bonusa noteikumus: apgrozījums, termiņi, spēļu ierobežojumi.
- Iestatiet depozīta, zaudējumu un sesijas laika limitus.
- Salīdziniet spēļu piedāvājumu pēc RTP, svārstīguma un funkcijām.
- Izmantojiet atbildīgas spēles rīkus un pauzējiet, ja rodas nogurums.
| Kategorija | Apraksts | Tipiski bonusi |
|---|---|---|
| Spēļu automāti | Klasika un moderni video automāti ar paplašinātām funkcijām | Bezmaksas griezieni, naudas atmaksa |
| Galda spēles | Rulete, blekdžeks, bakara un to dažādās variācijas | Likmju žetonu komplekti, apdrošināšanas atlīdzības |
| Live dīleri | Reāllaika straume ar profesionāliem vadītājiem | Turnīri, misijas ar punktiem un balvām |
| Kampaņas | Laika ierobežoti piedāvājumi un sezonāli pasākumi | Depozīta bonusi, lojalitātes punkti |
Ja izvēlaties sevi izaicināt ar jauniem nosaukumiem vai rīkoties piesardzīgi, vienmēr paturiet prātā, ka pacietība un skaidras robežas ir panākumu priekšnoteikums. Iepazīstieties ar noteikumiem, izmantojiet demonstrācijas versijas, un tikai tad pārejiet uz spēli ar īstu naudu. Neaizmirstiet salīdzināt maksājumu risinājumus, pārliecinieties par datu aizsardzību un glabājiet savas paroles drošībā. Atbildīga izklaide sākas tur, kur informācija un disciplīna satiek ziņkārību un prieku par kvalitatīvu spēļpieredzi.
Ceļvedis Latvijas spēlētājiem: kā gudri izvērtēt tiešsaistes piedāvājumu
Latvijas licencētajā vidē izvēle starp dažādām platformām var būt izaicinoša, it īpaši, ja vēlies atrast līdzsvaru starp drošību, spēļu kvalitāti un bonusu noteikumiem. Gudrs sākums ir skaidri saprast, kādi faktori tev ir svarīgākie: izmaksu ātrums, spēļu bibliotēkas daudzveidība, atbalsta kanālu pieejamība, kā arī caurspīdīgi noteikumi par bonusu apgrozījumu. Šajā ceļvedī apkopoti praktiski kritēriji, kas palīdz ikvienam pieņemt pārdomātus lēmumus un izvairīties no sasteigtiem klikšķiem, kas vēlāk var sadārdzināt izklaidi.
Internetā bieži tiek meklēti atslēgvārdi, piemēram, 11.lv spēļu automāti, jo tie palīdz ātri atrast populārus nosaukumus un piegādātāju katalogus, sākot no klasiskajām trīs rullīšu spēlēm līdz modernām video slotu sērijām ar džekpotiem un aizraujošiem bonusu raundiem.
Jaunajiem lietotājiem būtiska ir skaidrība par to, kur un kā saņemt īpašos piedāvājumus; tāpēc uzmanību piesaista formulējums 11.lv bonusa kods, kas parasti tiek attiecināts uz starta pakām, tematiskām kampaņām vai periodiskiem iemaksu stimuliem ar noteiktiem nosacījumiem.
Starp starptautiski atpazīstamiem terminiem bieži figurē 11.lv casino, kas līdzās vietējām norādēm liecina par plašu auditorijas interesi un palīdz atrast neatkarīgus salīdzinājumus, recenzijas un norādes par populārākajām spēlēm konkrētā laikā.
Vietējā sarunvalodā savukārt bieži izmanto 11.lv kazino, īpaši runājot par live dīleru galdiem, turnīriem, iknedēļas izaicinājumiem un lojalitātes līmeņu priekšrocībām, kas uzlabo ilgtermiņa pieredzi.
Citi spēlētāji izmanto anglisko salikteņa variantu 11 lv casino, sekojot ārzemju blogu reitingiem un salīdzināšanas tabulām, lai ātri saprastu piedāvājuma stiprās puses mobilajā un datoru vidē.
Latviskajā kontekstā tikpat bieži redzams arī 11 lv kazino, kas uzsver ērtu navigāciju, lokālu atbalstu un skaidru informāciju par iemaksām, izmaksām un spēles noteikumiem bez liekiem pārsteigumiem.
Ja runa ir par valodas niansēm un piekļuvi akcijām, nereti tiek jautāts, kur precīzi ievadīt 11 lv bonusa kods, cik ilgi piedāvājums ir spēkā un kādi ierobežojumi stājas spēkā pēc aktivizēšanas, lai izvairītos no pārpratumiem.
Rūpīga bonusu izpēte ietver arī bezmaksas griezienu noteikumus; piemēram, sauklis 11 lv free spins parasti paredz konkrētu griezienu skaitu noteiktos spēļu nosaukumos ar skaidri definētiem likmju limitiem un apgrozījuma prasībām.
Lietotāja ceļvedis nav pilnīgs bez vispārīgas norādes uz 11.lv kā domēnu, kurā parasti tiek apkopota informācija par reģistrāciju, verifikāciju, limitu iestatīšanu un atbildīgas spēles rīkiem, tostarp pašizslēgšanās iespējām.
Dažos pārskatos tiek izmantots arī neitrālais saīsinājums 11 lv, lai atdalītu valodas nianses no zīmola rakstības un izvairītos no pārāk tehniska toņa ikdienas sarunās.
Lai iegūtu perspektīvu no malas un salīdzināt dažādas pieejas, vari apskatīt resursu 11 Lv, kas kalpo kā neitrāls sākumpunkts tālākai izpētei un kvalitatīvai informācijai.
| Funkcija | Ko meklēt | Iespējamais ieguvums |
|---|---|---|
| Spēļu daudzveidība | Dažādi piegādātāji, džekpoti, kvalitatīvas live galda spēles | Elastīga izvēle un iespēja atrast sev piemērotu stilu |
| RTP un volatilitate | Pārskatāmi rādītāji un demonstrācijas režīmi | Gudrāka riska pārvaldība un saprotamas gaidas |
| Bonusu noteikumi | Skaidrs apgrozījums, maksimālās likmes ierobežojumi, termiņi | Izvairīšanās no pārsteigumiem un maksimāla vērtība |
| Maksājumu metodes | Ātras izmaksas, bez komisijas, lokāli risinājumi | Ērtums ikdienā un labāka naudas plūsmas kontrole |
| Klientu atbalsts | Latviešu valoda, 24/7 čats, kvalitatītas atbildes | Risinājumi bez kavēšanās un drošības sajūta |
| Mobilā saderība | Ātra ielāde, intuitīva navigācija, pielāgojami iestatījumi | Vienmērīga spēle ceļā bez veiktspējas kritumiem |
Lai gan uzmanību pievelk lielas kampaņas un spilgtas afišas, pārliecinies, ka pirms reģistrācijas esi izlasījis bonusu un spēļu noteikumus, pārbaudījis limitu iestatīšanas iespējas un iepazinies ar verifikācijas soļiem. Šāda pieeja palīdz saudzēt budžetu, saglabāt mieru un baudīt izklaidi ar skaidru rīcības plānu. Bonusi ir palīgi, nevis mērķis, tāpēc risku pārvaldība un konsekvence ir svarīgākas par īslaicīgiem stimulējošiem piedāvājumiem.
- Nosaki budžetu un iestati personīgos limitus vēl pirms reģistrācijas.
- Salīdzini RTP un volatilitate, lai atrastu atbilstošu spēļu profilu.
- Pārbaudi izmaksu ātrumu un potenciālās komisijas maksas.
- Izlasi bonusu termiņus, apgrozījumu un maksimālās likmes.
- Priekšroku dod vietnēm ar skaidru licenci un lokālu atbalstu.
Noslēgumā atceries: kvalitatīva pieredze balstās uz informētu izvēli un skaidriem personīgajiem noteikumiem. Pat ja primāri interesē populārākās spēles vai aktuālie piedāvājumi, ilgtermiņā izšķirošs būs drošs process, pārredzami nosacījumi un atbildīga pieeja. Jo sakārtotāka būs tava ikdienas prakse, jo vairāk izklaide paliks par patīkamu hobiju, nevis haotisku nejaušību kopumu.
Gudrs ceļvedis atbildīgai kazino pieredzei Latvijā
Latvijas tiešsaistes azartspēļu vide pēdējos gados strauji attīstās, un arvien vairāk spēlētāju meklē licencētus, drošus un pārskatāmus risinājumus izklaidei un potenciālai peļņai. Starp vietējiem zīmoliem īpaši pamanāms ir 11.lv, kas sevi pozicionē kā saturiski bagātu platformu ar skaidru piedāvājuma struktūru, kvalitatīvu klientu atbalstu latviešu valodā un mūsdienīgu pieeju atbildīgai spēlei.
Viena no lielākajām pievilcībām ir 11.lv spēļu automāti, jo portfelī atrodamas gan klasiskās trīs rullīšu spēles, gan moderni video sloti ar savstarpēji aizraujošām mehānikām, staķētiem simboliem un dažādiem bonusa raundiem. Līdztekus tam pieejami arī progresīvie džekpoti, tematiski piedzīvojumi un ražotāju jaunumi, kas bieži tiek iezīmēti īpašās kolekcijās, lai atvieglotu izvēli.
Jaunajiem klientiem arvien aktuālākas ir reģistrācijas priekšrocības un ilgtermiņa lojalitātes balvas. Šeit lieti noder 11.lv bonusa kods, kas periodiski ļauj atslēgt papildu līdzekļus, piedalīties ekskluzīvās misijās vai izmēģināt atlasītas spēles ar papildu griezieniem. Pirms aktivizācijas ieteicams vienmēr pārskatīt noteikumus, iemaksu sliekšņus un prasības attiecībā uz apgrozījumu.
Starptautiskā terminoloģijā bieži lietots jēdziens 11.lv casino, uzsverot, ka saturs neaprobežojas ar sporta likmēm vien, bet iekļauj arī galda spēles, live dīleru galdiņus un iknedēļas akcijas. Latviskajā apritē tikpat organiski skan 11.lv kazino, kas ataino plašu spēļu klāstu, ērti lietojamu vietni un strukturētas sadaļas, kurās viegli orientēties gan iesācējiem, gan pieredzējušiem entuziastiem.
Daži lietotāji izvēlas īsāku pierakstu bez punkta, piemēram, 11 lv casino, it īpaši, kad meklē ātru piekļuvi pamatinformācijai un pārskatāmiem piedāvājumiem. Tādā pašā nozīmē tiek lietota arī frāze 11 lv kazino, ko nereti redz forumos un apskatos, kur lietotāji dalās ar stratēģijām, turnīru kalendāru vērojumiem un maksājumu plūsmām.
Pirms aktivizēt kādu akciju, svarīgi rūpīgi pārbaudīt derīguma termiņu, minimālās iemaksas un to, kurām spēlēm attiecināma balva. Atsevišķās kampaņās darbojas konkrēti kodi, tostarp 11 lv bonusa kods, kas var būt piemērojams tikai noteiktām klientu grupām vai sadaļām. Citos gadījumos galvenais akcijas smaguma punkts ir griezieni; īpaši pieprasīts ir 11 lv free spins, jo tas sniedz iespēju pārbaudīt jaunas spēles ar mazāku risku un saprast to mehāniku pirms lielākiem likmju lēmumiem.
Ikdienas sarunvalodā nereti redzams arī vienkāršots pieraksts 11 lv, taču neatkarīgi no rakstības variācijām būtiskākais ir atbildīga spēle, skaidrs budžeta plāns un limits, pilnīga noteikumu izpratne un gatavība pieņemt pauzes, ja izklaide kļūst emocionāli vai finansiāli smagnēja.
Ja vajadzīgi papildu padomi un neatkarīgi resursi par licencēšanas niansēm, budžeta kontroles rīkiem un spēļu mehāniku, noderīgs sākuma punkts ir vietne 11 Lv, kur vienkopus apkopota informācija par atbildīgu izklaidi, terminoloģiju un lietotāju pieredzēm, kas palīdz pieņemt pārdomātus lēmumus.
- Nosaki budžetu un maksimālo sesijas laiku pirms spēlēšanas uzsākšanas.
- Izpēti spēļu noteikumus, īpaši RTP un svārstīgumu, lai saskaņotu cerības ar realitāti.
- Saglabā mieru un atceries, ka aizraušanās mērķis ir izklaide, nevis garantēta peļņa.
- Pārskati piedāvājuma noteikumus: derīguma termiņus, iemaksas un apgrozījumu.
- Izmanto demonstrācijas režīmus, lai iepazītos ar mehāniku, pirms liec īstu naudu.
| Kategorija | Ko piedāvā | Kam pievērst uzmanību |
|---|---|---|
| Spēļu automāti | Klasika, video sloti, progresīvie džekpoti un tematiskās kolekcijas | RTP, svārstīgums, bonusa raundi un līniju skaits |
| Galda spēles | Rulete, blekdžeks, bakara un to variācijas ar dažādiem likmju limitiem | Noteikumi, izmaksu struktūra un stratēģijas iespējas |
| Live dīleri | Reāllaika straumes ar profesionāliem dīleriem un interaktīvu vidi | Savienojuma stabilitāte, minimālās likmes un galdu pieejamība |
| Bonusi un griezieni | Ikmēneša akcijas, lojalitātes punkti un papildu griezieni atlasītām spēlēm | Derīguma termiņš, apgrozījuma prasības un spēļu ierobežojumi |
Padziļināts ieskats Latvijas tiešsaistes kazino vidē
Latvijas tiešsaistes izklaides vide pēdējos gados ir augusi strauji, un spēlētāji arvien biežāk izvēlas drošas, licencētas platformas, kurās apvienotas modernas tehnoloģijas, caurspīdīgi noteikumi un labi pārdomāta klientu pieredze. Svarīgi kritēriji ir ātras iemaksas un izmaksas, uzticami piegādātāji, taisnīga RTP, kā arī vietējai auditorijai pielāgota satura pieejamība latviešu valodā. Ne mazāk nozīmīga ir atbildīgas spēles politika: limitu iestatīšana, pašatteiku sistēma, realitātes atgādinājumi un klientu atbalsts, kas reaģē latviešu un krievu valodā.
Runājot par vietējiem piemēriem, spēlētāju uzmanību nereti piesaista 11.lv kazino, jo tur parasti tiek apvienotas vietējās norēķinu metodes, regulāri turnīri un skaidra bonusu struktūra. Pieredzējuši lietotāji vērtē, cik dāsni un saprotami ir noteikumi, kā darbojas verifikācija un cik elastīga ir mobilā pieredze. Jo īpaši aktuāls ir spēļu klāsts ar pazīstamām studijām un iespēja izmēģināt demonstrācijas versijas, pirms uzņemties reālu finansiālu risku.
Dažkārt starptautiskos apskatos redzama angliskota atsauce 11.lv casino, kas būtībā nozīmē to pašu zīmolu latviešu tirgū. Lielākā interese bieži saistās ar 11.lv spēļu automāti, jo tie aptver gan klasiskos trīs rullīšu nosaukumus, gan jaunākās Megaways un klasteru mehānikas. Spēlētāji novērtē bonusa pirkšanas iespējas, dažādu svārstīgumu un jackpot uzkrājumus, turklāt būtisks ir arī studiju daudzveidīgums, lai netrūktu ne populāro, ne nišas izstrādātāju.
Bonusos svarīgākais ir skaidrība un prognozējamība. Daļa kampaņu tiek aktivizētas ar 11.lv bonusa kods, kas pievieno reģistrācijas, iemaksu vai sezonālo piedāvājumu vērtību, ja vien spēlētājs izpilda apgrozījuma prasības un termiņus. Savukārt starptautiskajos blogos mēdz parādīties arī frāzes 11 lv bonusa kods vai 11 lv free spins; tās parasti apraksta to pašu mehāniku, tikai citā rakstībā, un norāda uz bezmaksas griezienu īpatnībām, piemēram, limitētiem spēļu nosaukumiem vai likmju griestiem.
Dabas likums digitālajā telpā ir variāciju pārbagātība: lietotāji raksta tā, kā ierasts, tāpēc līdzās oficiālajai domēna formai atrodami arī atslēgvārdi 11 lv kazino un 11 lv casino. Šīs versijas neietekmē paša pakalpojuma būtību, taču ietekmē to, kā informācija tiek atrasta meklētājos. Tāpēc kvalitātes vērtējums balstās saturā un praksē, nevis pareizrakstībā.
Terminoloģija var radīt jautājumus, lai gan būtiskākais ir drošs pamats. Ja lietotāji meklē īsu atsauci, nereti tiek lietots 11 lv, savukārt oficiālais domēna pieraksts 11.lv viennozīmīgi norāda uz attiecīgo vietni un tās licencēm. Plašāku salīdzinājumu, kur apkopota informācija par bonusiem, spēļu katalogu un lietotāju pieredzi, var atrast arī te: 11 Lv, kur saturs ir orientēts uz vietējā tirgus vajadzībām.
Neatkarīgi no izvēlētās platformas, ilgtermiņa pieredzi nosaka pārliecība par noteikumu caurspīdīgumu un vienlīdzību. Izvērtējiet RTP robežas, izmantojiet personīgos limitus, sekojiet līdz bonusu termiņiem un vienmēr pārbaudiet, vai klientu atbalsts spēj palīdzēt arī sarežģītākās situācijās, tostarp strīdos par izmaksām vai tehniskām kļūmēm. Gudra pieeja ļauj izklaidēties atbildīgi, turklāt saglabā budžeta kontroli, lai spēle nepārvērstos par dzīves centru.
- –
- Pārbaudiet licenci un regulatora informāciju pirms reģistrācijas.
–
- Izvērtējiet iemaksu/izmaksu ātrumu un komisijas.
–
- Pirms aktivizēšanas izlasiet visu bonusu noteikumus un termiņus.
–
- Skenējiet spēļu katalogu: svārstīgums, RTP, piegādātāji.
–
- Pārbaudiet mobilo saderību un veiktspēju reālos apstākļos.
–
- Izmantojiet limitus un pašatteiku rīkus atbildīgai spēlei.
| Funkcija | Apraksts | Ko meklēt |
|---|---|---|
| Spēļu tipi | Automāti, galda spēles, live dīleri, loterijas | Daudzveidība, demonstrācijas versijas, godīgums |
| Bonusi | Iemaksu piedāvājumi, naudas atmaksa, turnīri | Skaidri nosacījumi, saprātīgs apgrozījums, termiņi |
| Bezmaksas griezieni | Kampaņas noteiktiem spēļu nosaukumiem | Likmju griesti, spēļu ierobežojumi, derīguma termiņš |
| Maksājumi | Kartes, bankas pārskaitījumi, e-maki | Ātrums, komisijas, vietējās metodes |
| Drošība | Šifrēšana, datu aizsardzība, verifikācija | SSL, KYC caurspīdīgums, reputācija |
| Atbalsts | Čats, e-pasts, tālrunis noteiktos laikos | Valodu pieejamība, reakcijas laiks, kompetence |
Ceļvedis drošai un pārdomātai kazino izvēlei Latvijā
Latvijā tiešsaistes izklaide turpina augt, un spēlētāji arvien biežāk meklē vietnes, kas apvieno uzticamību, plašu saturu un skaidrus noteikumus. Izvēles brīdī vērts novērtēt licenci, datu aizsardzību, maksājumu metodes, mobilās lietošanas ērtumu un klientu atbalsta atsaucību. Tikpat svarīgi ir izprast bonusu noteikumus, minimālo iemaksu robežas, izņemšanas termiņus un atbildīgas spēles rīkus, piemēram, limitus un pašizslēgšanos. Pieredzējuši spēlētāji arī pievērš uzmanību spēļu katalogu kvalitātei, programmatūras piegādātājiem un RTP rādītājiem, lai spēle būtu gan aizraujoša, gan caurspīdīga.
Salīdzināšanas ceļvedi vislabāk veidot, apskatot vairākus operatorus, to īpašos piedāvājumus, turnīrus un testējot demorežīmus. Lai ātrāk atrastu informāciju par jaunumiem, akcijām un tendencēm, noderēs neatkarīgi resursi; piemēram, apskatu lasītāji bieži atzīmē, ka saites uz aktuālajām sadaļām vienuviet palīdz ietaupīt laiku, un arī platforma 11 Lv var kalpot kā orientieris, ja vēlaties salīdzināt kategorijas vai nosacījumus. Neaizmirstiet, ka jebkuram bonusam ir apgrozījuma prasības un kvalifikācijas nosacījumi.
Runājot par spēlēm, plašu auditoriju vienmēr piesaista 11.lv spēļu automāti, jo tajos bieži sastopamas dažādas mehānikas: no klasiskajiem trīs ruļļiem līdz video slotiem ar paplašināmām rindām, pirktajiem bonusa raundiem un džekpotu tīkliem. Daudzi meklē Megaways, klasteru izmaksas un kolekcionēšanas funkcijas, kas piešķir progresu katrā griezienā. Laba prakse ir sākt ar zemākām likmēm, izmēģināt demoversijas, izprast īpašos simbolus, un tikai tad noteikt personīgo budžetu, lai nepieļautu impulsīvus lēmumus spēles karstumā.
Izvērtējot zīmolu reputāciju, svarīga ir konsekvence un skaidrs piedāvājums dažādās valodās. Tas pats operators var tikt dēvēts gan kā 11.lv kazino, gan kā 11.lv casino, un daļa lietotāju vienkārši piemin saīsināto 11.lv, kad runā par licencētu piekļuvi, mobilajām lietotnēm vai akciju noteikumiem. Šāda terminoloģijas daudzveidība ir dabiska, tomēr galvenais ir, lai klientu atbalsts būtu sasniedzams latviski, maksājumi — droši, bet spēles — godīgas un regulāri auditētas.
Bonusi bieži piesaista uzmanību, taču tos vajadzētu uztvert kā papildu iespēju, nevis garantiju. Reizēm tiek izziņots 11.lv bonusa kods ar konkrētiem apgrozījuma nosacījumiem, citkārt līdzīgs piedāvājums tiek komunicēts kā 11 lv bonusa kods, savukārt fani īpaši novērtē kampaņas, kurās ietilpst 11 lv free spins noteiktos spēļu automātos. Pirms izmantošanas pārbaudiet minimālās likmes, uzskaites periodus, maksimālās izmaksas no bonusa un to, vai dažādām spēlēm ir atšķirīgs ieguldījuma procents.
Sarunvalodā spēlētāji bieži lieto vienkāršotus nosaukumus: kāds saka 11 lv, cits meklē informāciju par 11 lv casino, bet vēl kāds dod priekšroku latviskajam 11 lv kazino. Lai arī nosaukumi atšķiras, izvērtēšanas principi paliek tie paši: pārskatāmas kampaņas, skaidri noteikumi, verifikācijas ātrums, izņemšanas konsekvence un drošības protokolu kvalitāte. Gudrs spēlētājs nemeklē ātru veiksmi, bet gan stabilu, uzticamu vidi un ilgtermiņā patīkamu pieredzi.
| Sadaļa | Kas jāmeklē | Kāpēc tas svarīgi |
|---|---|---|
| Spēļu katalogs | Dažādi piegādātāji, demoversijas, skaidri noteikumi par izmaksām | Daudzveidība un pārskatāmība uzlabo pieredzi un ļauj testēt stratēģijas |
| Bonusu politika | Reāli apgrozījuma koeficienti, termiņi, ieguldījuma procenti pa žanriem | Taisnīgi nosacījumi palīdz izvairīties no nepatīkamiem pārsteigumiem |
| Maksājumi un drošība | SSL, uzticami procesori, ātra verifikācija, skaidras izmaksu kārtības | Datu aizsardzība un savlaicīgas izmaksas veicina uzticēšanos |
- Pārbaudiet licenci un regulatora norādes pirms reģistrācijas.
- Iepazīstiet RTP un svārstīgumu, lai atbilstu savam stilam.
- Salīdziniet bonusu noteikumus, termiņus un ierobežojumus.
- Iestatiet budžetu, izmantojiet limitus un plānojiet atpūtas pauzes.
Kopsavilkumā, pārdomāta izvēle sākas ar objektīvu salīdzināšanu, skaidriem mērķiem un atbildīgu pieeju. Vērtējiet saturu, drošību un klientu atbalstu, rūpīgi izlasiet noteikumus, un saglabājiet disciplīnu. Tā jūs iegūsiet stabilu, caurspīdīgu un patīkamu izklaides pieredzi, kas atbilst jūsu gaidām un budžetam.
Valódi élmény és felelős játék: útmutató online kaszinórajongóknak
Az online kaszinók világa az elmúlt években látványos fejlődésen ment át Magyarországon is. A játékosok ma már kifinomult felületeken, gyors mobilalkalmazásokban és biztonságos fizetési csatornákon keresztül élvezhetik a szórakozást. A felelős játék és a transzparens szabályok legalább olyan fontosak, mint az izgalom: érdemes ellenőrizni az engedélyeket, a független auditokat és az RNG-teszteket. A megbízható operátorok pontos információt adnak a bónuszfeltételekről, az ügyfélszolgálat elérhetőségéről és a kifizetési idők átlagáról, hogy mindenki tudatos döntést hozhasson.
A megfelelő platform kiválasztásakor nézd meg, mennyire sokszínű a játékkínálat: klasszikus és modern nyerőgépek, rulett, blackjack, baccarat, pókerváltozatok és élő osztós asztalok. Fontos a szoftverszállítók hírneve, az RTP-értékek átláthatósága és a limitbeállítások rugalmassága. Az intuitív kereső, a kategorizálás, a demó mód és a gyors regisztráció mind hozzájárulnak ahhoz, hogy a szórakozás gördülékeny legyen, felesleges várakozás nélkül.
Ha megbízható, engedéllyel rendelkező szolgáltatót keresel, érdemes felkeresni a Grand Casino hivatalos oldalát, ahol részletes játékleírások, kezdő útmutatók és naprakész bónuszok segítenek az indulásban.
| Játéktípus | Fő jellemzők | Átlagos RTP | Játékostipp |
|---|---|---|---|
| Nyerőgépek | Jackpotok, bónuszkörök, változó volatilitás | 94–98% | Próbáld ki demó módban, ismerd meg a nyerőtáblát |
| Rulett | Európai, francia és amerikai változatok | 94.7–98.6% | Válaszd az európai kereket az alacsonyabb házelőnyért |
| Blackjack | Stratégiaalapú döntések, oldalfogadások | 98–99.5% | Kövesd az alapszabályt, figyeld a paklik számát |
| Élő osztós | HD közvetítés, valós idejű kommunikáció | Játéktól függ | Ellenőrizd a tétlimiteket és az ülésre várakozást |
A magyar játékosok körében a grand casino online fogalma gyakran a kényelmes hozzáférést, a bankkártyás és e‑pénztárcás befizetéseket, valamint a valós idejű ügyfélszolgálatot jelenti. Egy jól megépített oldal gyorsan betölt mobilon is, reszponzív, és világos navigációt kínál. Az átlátható promóciós naptár, a részletes hűségprogram és a felelős játék eszközei – például az önkorlátozás és a szünet funkció – mind-mind azt szolgálják, hogy a játékélmény élvezetes és kontrollált maradjon.
A bónuszok értékelésekor mindig vedd figyelembe a megforgatási követelményeket, a maximális tétkorlátot és a játékhozzájárulási százalékokat. A free spin csomagok és a befizetési bónuszok akkor a legjobbak, ha reális feltételekkel párosulnak, és egyértelműen jelzik, mely játékokhoz használhatók. Tartsd szem előtt a lejárati időt, a kifizetés előtti dokumentumellenőrzést, valamint azt, hogy egyes jackpot címek gyakran kizártak a követelmények teljesítéséből.
- Állíts be napi, heti és havi befizetési limiteket.
- Kapcsold be a valóságellenőrző értesítéseket hosszabb játékmeneteknél.
- Tarts szünetet, ha sorozatos veszteséget tapasztalsz.
- Soha ne játssz kölcsönből, és ne üldözd a veszteséget.
- Keresd az engedéllyel rendelkező, függetlenül auditált szolgáltatókat.
Egyes játékosok a grand casino hangulatát keresik az online térben: elegáns dizájn, visszafogott színek, profi krupiék és olyan funkciók, amelyek az asztalnál ülés érzetét keltik. Erre a célra az élő stúdiók HD közvetítése, a többkamerás nézet és a statisztika‑panel kiváló eszköz, miközben a felelős játék beállításai mindig kéznél maradnak.
Összegzésként: válassz megbízható szolgáltatót, olvasd el a feltételeket, teszteld a játékokat demó módban, és csak annyit kockáztass, amennyit megengedhetsz magadnak. Így az online szórakozás nemcsak izgalmas, hanem biztonságos és hosszú távon fenntartható élmény lesz.
Útmutató a biztonságos és tudatos online játékélményhez
A magyar játékosközösség az utóbbi években látványos átalakuláson ment keresztül: a szórakozás egyre nagyobb része költözött át a digitális térbe, ahol a platformok gyorsasággal, széles játékválasztékkal és kényelmes, mobileszközökhöz optimalizált felületekkel várják a felhasználókat. A vonzerőt nemcsak a modern grafikák és a pörgős mechanikák adják, hanem az a fajta azonnaliság is, amelyet a böngészős és applikációs megoldások képesek nyújtani. Aki új környezetet keres, gyakran a megbízhatóság, az átláthatóság és a könnyű regisztráció kombinációját helyezi előtérbe.
A jogszabályi és szabályozási háttér megértése különösen fontos mindenkinek, aki felelős módon szeretne játszani. A licenccel rendelkező szolgáltatók ellenőrzött környezetet biztosítanak, világos adatkezelési irányelvekkel, panaszkezelési eljárással, valamint olyan eszközökkel, amelyek segítik a tudatos döntéshozatalt. További tájékozódásért és a hivatalos állásfoglalásokért érdemes felkeresni a Szerencsejáték oldalát, ahol a felelős játék kereteiről és a fogyasztóvédelmi lehetőségekről is részletes információk találhatók.
Felhasználói élmény szempontjából a legjobb platformok több nézőpontból is erősek: gyors a betöltés, logikus a menürendszer, és néhány kattintással elérhető minden fontos funkció. A kereső- és szűrőrendszerek megkönnyítik az új címek felfedezését, míg az élő asztaloknál a professzionális közvetítés, a több kameranézet és a stabil kapcsolat garantálja az immerszív élményt. A demó mód jelenléte nagy előny, mert kockázatmentesen próbálható ki a játékmenet.
A bónuszok az első benyomást gyakran meghatározzák, de a feltételek legalább ilyen lényegesek. Érdemes figyelni a megforgatási követelmények mértékére, a százalékos hozzájárulásra játéktípusonként, a maximális tét limitjére, valamint az időkorlátokra. Az üdvözlő csomagok mellett a visszatérő promóciók – például a hétvégi újratöltés, a cashback, az ingyenes pörgetések és a hűségprogramok – teszik hosszú távon is értékessé a részvételt. Az átlátható promóciós naptár és a push értesítések segítenek abban, hogy semmi ne maradjon ki.
A befizetések és kifizetések terén a rugalmasság és a biztonság a döntő. A forintban elérhető egyenleg, a népszerű bankkártyák, az e‑pénztárcák és a gyors átutalási opciók kényelmessé teszik a pénzügyeket. A modern titkosítási szabványok, a fiókvédelem többfaktoros azonosítással és a megbízható tranzakció‑feldolgozás mind hozzájárulnak a védett környezethez. A KYC ellenőrzés elsőre nehézkesnek tűnhet, de valójában a csalásmegelőzés és a kifizetések biztonsága miatt elengedhetetlen.
A tudatosság a sikeres élmény másik kulcsa: hasznos, ha előre meghatározod a költségkeretet, beállítod az időkorlátokat, és rendszeres szüneteket tartasz. A platformok egy része kínál valós idejű statisztikát és önkorlátozó eszközöket, amelyek segítségével kézben tartható a játékra fordított energia és idő. A szerencsejáték akkor marad szórakozás, ha nem a gyors meggazdagodás reménye, hanem a felelős időtöltés és a játékmechanikák felfedezése áll a középpontban.
A mobilhasználat térnyerésével az élmény átalakult: a letölthető alkalmazások és a reszponzív webes felületek zökkenőmentesen illeszkednek a mindennapi rutinba. A szerveroldali optimalizáció, a gyorsítótár‑kezelés és az érintésre szabott vezérlők hozzák az azonnaliságot. A szerencsejáték online világában kiemelt érték, ha a gyártói integráció stabil, a játékok pedig ugyanazt a grafikai és hangzásbeli minőséget nyújtják mobilon, mint asztali gépen. A háttérfolyamatok reszponzivitása és az élő közvetítések késleltetésének minimalizálása külön előny.
Platformválasztáskor nézd át a kínálat sokszínűségét, a bónuszfeltételek átláthatóságát, az ügyfélszolgálat elérhetőségét és a kifizetések átlagos átfutási idejét. A táblázat az alábbiakban összefoglalja a legnépszerűbb játéktípusokat és azok jellegzetességeit, a lista pedig egy gyors ellenőrző pontsor, amely segít számodra a felelős, informált döntésben. Ha mindezt kombinálod saját céljaiddal és preferenciáiddal, hosszú távon kiegyensúlyozott élményre számíthatsz.
| Játéktípus | Jellemzők | Bónuszokhoz való illeszkedés | Volatilitás |
|---|---|---|---|
| Nyerőgépek | Gyors körök, témák széles választéka, bővülő vadak és bónuszkörök | Gyakran magas hozzájárulás az ajánlatok teljesítéséhez | Alacsonytól a nagyon magasig |
| Rulett | Klasszikus asztali élmény, európai és francia variánsok | Közepes vagy alacsony hozzájárulás a feltételekben | Közepes |
| Blackjack | Stratégiai döntések, alacsony házelőny megfelelő szabályok mellett | Gyakran korlátozott beszámítás | Alacsony-közepes |
| Élő osztós játékok | Valós idejű közvetítés, interakció a krupiéval | Szokásosan alacsony hozzájárulás | Közepes |
| Sportfogadás | Piacok széles köre, élő fogadási opciók | Külön kampányok, kuponbónuszok | Piacfüggő |
- Ellenőrizd a szolgáltató licencét és az átlátható működési feltételeket.
- Nézd meg a befizetési és kifizetési lehetőségeket, valamint az átlagos átfutási időt.
- Olvasd el a bónuszok megforgatási szabályait és a játéktípusonkénti beszámítást.
- Vizsgáld meg a játékok visszatérítési arányát (RTP) és a volatilitást.
- Értékeld az ügyfélszolgálat elérhetőségét: élő chat, e‑mail, tudásbázis.
- Használd a felelős játékot támogató eszközöket: limitek, szünetek, önkizárás.
Végül, alakíts ki saját szabályrendszert: határozd meg, mennyi időt és forrást szánsz a kikapcsolódásra, tartsd a fókuszt a szórakozáson, és ünnepeld a kisebb eredményeket is. A fenntartható élményhez hozzájárul a rendszeres értékelés: nézd át a statisztikáidat, hangold újra a limiteket, és válassz olyan platformot, amely rugalmasan követi az igényeidet. Így a digitális játékvilág valóban az marad, aminek szánod: modern, izgalmas, mégis kontrollált szabadidős tevékenység.
Online kaszinóélmény, amely a magyar játékosok igényeire szabott
A hazai játékosok számára egyre fontosabb, hogy a választott platform valódi értéket és átláthatóságot kínáljon. A ggbet online casino világa abban segít, hogy a szórakozás mellett stabil, megbízható környezetben játszhass. A modern felületek gyors betöltési idővel, mobilra optimalizált kialakítással és változatos játékkínálattal várnak, miközben a bónuszrendszer és a hűségprogramok hosszú távon is motiválóak maradnak. A regisztráció során figyelj a személyazonosítási követelményekre, mert ezek biztosítják, hogy a kifizetések gond nélkül történjenek. A felelős játékszervezés szintén kulcsfontosságú: költségkeret, időkeret és a játékstatisztikák segítenek egyensúlyban tartani a szórakozást.
Egy felhasználóbarát felületen a számlakezelés, a nyeremények ellenőrzése és a promóciók igénylése néhány kattintással történik, a ggbet login folyamata pedig általában kétlépcsős az extra biztonság érdekében. Érdemes a fiókadatokat naprakészen tartani, hogy a tranzakciók gyorsan jóváhagyhatók legyenek. Ha kíváncsi vagy az aktuális promóciós naptárra vagy az új játékmegjelenésekre, akkor a GGBet oldalán közérthető útmutatók és gyakori kérdések szekció segít eligazodni. A magyar nyelvű ügyfélszolgálat és a részletes tudásbázis megkönnyíti a kezdést, míg a demo módok kockázatmentes kipróbálást kínálnak.
A mobilos élmény kiemelt szempont lett: a ggbet app kifejezetten a képernyőméretekhez igazodó navigációt, gyors bejelentkezést és értesítéseket ad a játékosok kezébe. Így az élő osztós asztalok, a nyerőgépek és a valós idejű promóciók útközben is elérhetők. A reszponzív felület folyamatosan illeszkedik a hálózati körülményekhez, ezért gyengébb internetkapcsolat mellett is gördülékeny marad a játékmenet. A sötét és világos témák közötti váltás kíméli a szemet, az ujjlenyomatos vagy arcfelismeréses beléptetés pedig felgyorsítja a napi használatot anélkül, hogy a biztonság csorbulna.
A játékválasztékban a klasszikus gyümölcsös nyerőgépek és a modern, bónuszkörökkel teli slotok mellett élő kaszinó asztalok, videó póker és asztali játékok is helyet kapnak. A visszafizetési arányok (RTP) transzparens feltüntetése segít összehasonlítani a címeket, miközben a kereső- és szűrőeszközök lerövidítik a böngészést. A progresszív jackpotok külön aloldalt is kaphatnak, hogy valós időben lásd a nyereményalap növekedését. Az élő osztós szekcióban a HD közvetítés és a több nézetre bontott kamera javítja a jelenlét érzetét.
A ggbet casino érdeme, hogy a licencelésről és a független tesztekről részletes információt ad, így a játékos könnyebben dönthet. A ggbet neve sokak számára egyet jelent a letisztult kezelőfelülettel és a gyors ügyintézéssel; a szolgáltató a felelős játékmenedzsmentet beépíti a felületbe. A promóciók világos feltételei és a hűségpontok visszaválthatósága átláthatóbbá teszik a hosszú távú részvételt. Egy jól strukturált súgóoldal, videós útmutatók és közösségi tippek támogatják a tudatos játékot, miközben az időzített ajánlatok nem tolakodóak.
A befizetéseknél a bankkártya, az e‑pénztárcák és az átutalás a legelterjedtebb megoldások; a kifizetésekhez gyakran ugyanazt a csatornát kérik a pénzmosás elleni szabályok miatt. A tranzakciókat SSL‑titkosítás védi, az adatok tárolását pedig szigorú házirend szabályozza. Az ügyfélszolgálat 0–24-es chatje és az e‑mail támogatás gyorsan reagál a dokumentumokkal, limitekkel, vagy technikai gondokkal kapcsolatos kérésekre. Érdemes kihasználni az értesítéseket, hogy ne maradj le az időszakos tornákról és nyereményjátékokról.
| Jellemző | Részletek | Előny |
|---|---|---|
| Bónuszok és promóciók | Üdvözlő csomag, újratöltési bónuszok, ingyenes pörgetések | Nagyobb kezdőtőke és hosszabb játékidő |
| Játékkínálat | Nyerőgépek, élő osztós asztalok, rulett, blackjack, videó póker | Változatosság minden preferenciához |
| Ügyfélszolgálat | 0–24 élő chat és e‑mail, magyar nyelvű támogatás | Gyors és érthető segítség |
| Fizetési módok | Bankkártya, e‑pénztárca, átutalás | Rugalmas befizetés és kifizetés |
| Biztonság | SSL‑titkosítás, auditált véletlenszám‑generátor | Megbízható környezet és tisztességes játék |
- Minden bónusz előtt olvasd el a megforgatási feltételeket és a határidőket.
- Állíts be költségkeretet és időlimitet, és tartsd magad hozzájuk.
- Használd a demó módot, hogy tét nélkül megismerd a játékmenetet.
- Válassz olyan címeket, amelyeknél ismered a szabályokat és az RTP értéket.
- Tarts szüneteket, és használd az önkizárási vagy befizetési limiteket, ha szükséges.
Ha hosszú távon gondolkodsz, teremts stratégiát: figyeld a naptárban a rendszeres ajánlatokat, válaszd ki a hozzád illő időszakos tornákat, és ne feledkezz meg a dokumentumok frissítéséről. A felelős játék alapja az önismeret és a tervezés: csak olyan összeget kockáztass, amely a szórakozás része, és amelynek elvesztése nem befolyásolja a mindennapjaidat. Így a platform minden előnye – a könnyű kezelhetőség, az átlátható promóciók és a gyors ügyintézés – valóban a te élményedet szolgálja.
Részletes áttekintés és hasznos tippek magyar játékosoknak
A hazai játékosok számára egyre fontosabb, hogy olyan szolgáltatót válasszanak, amely megbízható, átlátható és valódi szórakozást nyújt. A döntés gyakran azon múlik, hogyan teljesít a rendszeres promóciók, a felelős játékot támogató funkciók és a mobilos élmény terén. A felhasználók figyelik a játékportfólió változatosságát, a bónuszok valódi értékét, a fizetési módok biztonságát, valamint a magyar nyelvű ügyféltámogatás minőségét. Amikor új platformot próbálunk ki, jól jön egy rövid útmutató a számlanyitástól a kifizetésekig, és érdemes támaszkodni a közösségi fórumok és szakmai oldalak tapasztalataira is. Nem mindegy, hogy a promóciók mennyire könnyen érthetők, és hogy a feltételek világosak-e.
A fiók létrehozása általában gyors, de mindig ellenőrizzük, milyen dokumentumokra lehet szükség a személyazonosításnál, hogy a későbbi lépések zökkenőmentesek legyenek. A biztonságos hozzáférés kiemelten fontos, ezért kétlépcsős azonosítást, erős jelszót és naprakész elérhetőségeket célszerű beállítani. A magyar játékosok sokszor keresik az egyszerű folyamatokat és az intuitív menüket, ezért nem véletlen, hogy az olyan rövid elnevezések, mint az energycasino belépés, gyakran felbukkannak a keresések között. A gördülékeny navigáció, az átlátható pénztár és a gyors betöltési idők mind hozzájárulnak ahhoz, hogy az első élmény pozitív legyen.
A bónuszok világa izgalmas, de a részletekben rejlik az érték. Ha valaki kuponkóddal aktiválható kedvezményeket keres, könnyen találkozhat a kifejezéssel: energycasino promo code, amely gyakran kapcsolódik üdvözlő csomagokhoz vagy időszakos akciókhoz. Mások a kockázatminimalizálás érdekében inkább a kötelező befizetés nélküli promóciók után érdeklődnek; ilyen esetekben gyakran emlegetik a következőket: energycasino no deposit bonus és energycasino no deposit bonus code, amelyeknél jellemzően meghatározott játékokra, maximális nyeremény- vagy kifizetési limitre, illetve lejárati időre vonatkozó feltételek érvényesek. Előfordul az angol megfogalmazású ajánlat is, például az energy casino no deposit bonus, amely szintén hasonló kritériumokkal működik. Aki felelősen játszik, mindig elolvassa a felhasználási feltételeket, és ellenőrzi a megforgatási követelményeket, a hozzájárulási arányokat, valamint a maximum tét limitet, hogy elkerülje a félreértéseket.
További részletekért és hivatalos információkért érdemes ellátogatni a szolgáltató oldalára: Energycasino, ahol a kampányok, a bónuszok és a játékkínálat naprakész leírása található, magyar felhasználóknak is könnyen értelmezhető formában.
Gyakori téma a promóciós összehasonlításoknál az energy casino 30, amelyet a fórumokon sokszor példaként említenek, amikor egy középméretű, mégis vonzó bónuszcsomag feltételeit vizsgálják. Ilyenkor a játékosok megnézik, milyen játékokra él a kedvezmény, mennyi idő áll rendelkezésre a felhasználásra, és hogy a kifizetési korlátok hogyan alakulnak. Azt is mérlegelik, mennyire könnyű a bónuszt aktiválni, és hogy a hűségprogramok vagy a tornák plusz értéket adnak-e a csomaghoz.
A pénzügyi folyamatoknál a biztonság és az átláthatóság kulcsfontosságú. A gyors és díjmentes tranzakciók, a bankkártyák, e-pénztárcák és átutalások támogatása, valamint a helyi preferenciákhoz illeszkedő megoldások mind hozzájárulnak a jó élményhez. A magyar visszajelzések szerint külön figyelmet kap az energy casino kifizetés, hiszen a játékosok értékelik a kiszámítható feldolgozási időt, a reális minimum és maximum limiteket, valamint a korrekt, dokumentált folyamatokat. A jó gyakorlat az, ha már a regisztráció után, még a befizetés előtt elolvassuk a kifizetési feltételeket, és elvégezzük az ellenőrzést, így a nyeremény felvétele gyorsan és gond nélkül történhet.
A közösségi tapasztalatok fontos iránymutatást adnak: az energycasino vélemények gyakran kitérnek a játékok stabilitására, a jackpotok átlátható kommunikációjára, és arra, hogy mennyire segítőkész a magyar nyelven elérhető ügyfélszolgálat. Sokan egyszerűen energycasino néven emlegetik a márkát, mások az energy casino kifejezést használják, de a lényeg ugyanaz: a játékosok olyan platformot keresnek, ahol a promóciók értelmesek, a szabályok korrektek, és a mindennapi használat kényelmes. A hosszú távú elégedettséghez a bónuszok mellett a rendszeres új tartalom, a felelős játékszabályok és az adatvédelem is nélkülözhetetlen.
- Magyar nyelvű felület és ügyféltámogatás a könnyebb eligazodásért
- Széles játékválaszték: nyerőgépek, asztali játékok, élő osztós szekció
- Rugalmas befizetési és kifizetési opciók, átlátható limitekkel
- Időszakos promóciók és hűségprogram a visszatérő játékosoknak
- Felelős játékszabályok: limitek, önkizárás és valós idejű eszközök
| Kategória | Lényeg | Játékos szempont |
|---|---|---|
| Üdvözlő ajánlat | Átlátható bónusz, tiszta feltételek | Reális megforgatás és határidők |
| Játékkínálat | Nyerőgépek, asztali, élő kaszinó | Stabilitás, mobiloptimalizálás |
| Tranzakciók | Gyors befizetés és feldolgozás | Alacsony díjak, megbízható csatornák |
| Ügyfélszolgálat | Több csatorna, magyar támogatás | Gyors és hasznos válaszok |
| Felelős játék | Személyre szabható limitek | Könnyű beállítás és átláthatóság |
Végül, mielőtt bármilyen promóciót aktiválnánk, érdemes listát készíteni a fontos szempontokról, és ellenőrizni, hogy a választott szolgáltató mindegyik területen megfelel-e az elvárásoknak. Így a szórakozás marad a középpontban, és a döntéseink tudatosak lesznek.
Online kaszinó élmény és tudnivalók
Az online szerencsejáték világa gyorsan fejlődik, és a játékosok egyre tudatosabban keresik azokat a szolgáltatókat, amelyek megbízhatóságot, átláthatóságot és gördülékeny felhasználói élményt kínálnak. A piacon több platform is versenyez a figyelemért, és közülük sok olyan megoldást hoz, amely mobilon és asztali gépen is egyformán kényelmes. A modern kaszinófelületek mögött gyakran olyan rendszer áll, amely a regisztrációtól a játékok böngészéséig minden lépést egyszerűsít, miközben a felelősségteljes játékot előtérbe helyezi. A játékosok számára különösen fontos a gyors kifizetés, az éjjel-nappali ügyfélszolgálat, valamint az, hogy a játékok tisztességes, függetlenül auditált RNG-vel működjenek.
A bónuszok és promóciók akkor értékesek, ha világos feltételek mellett, reális megforgatási követelményekkel érkeznek. Sok felhasználó szereti összehasonlítani a különböző csomagokat, mielőtt döntene, mert a bónusz összegén túl a bónuszjátékok terjedelme és a kifizetési korlátok is számítanak. Ha részletesen szeretnél utánanézni egy ajánlat részleteinek, a NV Casino bonus oldal leírásai jó kiindulópontot adhatnak, mivel egy helyen összegzik a legfontosabb szabályokat és gyakori kérdéseket, így elkerülhetők a félreértések a későbbi játék során.
A biztonság és a hozzáférhetőség kulcskérdés. A kétlépcsős hitelesítés, az erős jelszavak és az adatvédelemi tájékoztató átláthatósága mind hozzájárulnak a nyugodt játékélményhez. A belépési folyamatnak egyszerűnek kell lennie, mégis kellően védettnek, hogy illetéktelenek ne férhessenek hozzá a számlához. A modern rendszerek ezért külön figyelmet fordítanak a gyors, mégis megbízható azonosításra; tipikus példa erre a nv casino online login kifejezés mögött álló megoldás, amely egyértelmű lépésekkel, e-mailes vagy SMS-es megerősítéssel és eszközfelismeréssel támogatja a felhasználókat.
A promóciók megértéséhez érdemes alaposan átnézni a megforgatási szabályokat, a lejárati időt és azokra a játékokra vonatkozó korlátozásokat, amelyek teljesítik a követelményeket. A játékosok számára az átláthatóság és az ügyfélszolgálat gyors reagálása különösen sokat számít, amikor egy ajánlat feltételei kérdéseket vetnek fel. Érdemes figyelni arra is, hogy a bónuszok hogyan aránylanak a befizetéshez, és hogy léteznek-e extra pörgetések vagy cashback lehetőségek. Egy jól felépített nv casino bonus esetében mindezek a részletek világosan, félreérthetetlenül szerepelnek.
A márkaélmény nemcsak a látványról és a játékok változatosságáról szól, hanem arról is, hogyan kezeli a szolgáltató a pénzügyeket, a panaszokat és a felelős játékkal kapcsolatos eszközöket. Egy név csak akkor válik valódi ajánlássá a közösség szemében, ha a kifizetések kiszámíthatóak, a hitelesítési folyamat egyensúlyban van a biztonság és a kényelem között, valamint a limitek beállítása – beleértve a befizetési, veszteség- és időkorlátokat – mindenki számára könnyen elérhető és testre szabható.
- Gyors számlanyitás és egyértelmű azonosítási lépések.
- Rugalmas befizetési módok és transzparens díjak.
- Valósidejű ügyféltámogatás több csatornán.
- Felelős játékeszközök: limitek, szüneteltetés, önkizárás.
- Mobilbarát felület és stabil élő osztós szekció.
| Játéktípus | Jellemző | Átlag RTP | Megjegyzés |
|---|---|---|---|
| Nyerőgépek | Változatos témák, bónusz körök | 95–97% | Alacsony belépő tét, gyors körök |
| Rulett | RNG és élő osztós változatok | 97–98% | Európai kerék kedvezőbb házelőnnyel |
| Blackjack | Stratégiát igénylő döntések | 99% körül | Alacsony házelőny, gyakorlással optimalizálható |
| Póker | Készpénzes és verseny formátumok | Változó | Közösségi élmény, különböző vakstruktúrák |
Amikor új platformot választasz, mindig ellenőrizd a licencinformációt, olvasd el a felhasználói visszajelzéseket, és győződj meg arról, hogy a feltételek egyértelműek. Állíts be költségkeretet, tarts rendszeres szüneteket, és kezeld a játékot szórakozásként, nem pedig biztos bevételi forrásként. Így nemcsak az élmény marad pozitív, hanem hosszú távon is megtalálod azokat a szolgáltatásokat, amelyek valóban neked valók.
Online kaszinóélmény: mit érdemes tudni a bónuszokról, játékokról és biztonságról
Az online kaszinók világa rendkívül változatos, és a játékosok számára egyre több lehetőséget kínál, kezdve a tematikus nyerőgépektől az élő osztós asztalokig. A döntésnél sokat számít a megbízható licenc, a játékportfólió minősége, a gyors kifizetés és a transzparens bónuszfeltételek. Egy jól felépített platform kényelmes felhasználói felületet, mobilbarát működést, többféle fizetési módot és magyar nyelvű ügyfélszolgálatot biztosít. Emellett a felelős játékmenedzsment eszközei, mint a befizetési limit, az időkorlát és az önkizárás, segítenek a tudatos szórakozásban. A kezdő játékosoknak érdemes demó módban kipróbálni a címeket, mielőtt valódi pénzre váltanának, a tapasztaltabb felhasználók pedig értékelik a rendszeres promóciókat és a hűségprogramot.
A magyar játékosok körében népszerűek azok a kaszinók, amelyek kiegyensúlyozott kezdő csomagot, elfogadható fogadási követelményeket és átlátható szabályzatot kínálnak. A versenyek, küldetések és ranglisták extra izgalmat adnak, különösen akkor, ha a jutalmak valóban hozzáférhetők, és a bónuszkörök nem rejtőznek bonyolult feltételek mögé. Regisztráció előtt mindig ellenőrizni kell a befizetési és kifizetési limiteket, a feldolgozási időket, valamint a támogatott valutákat. Ha egy operátor naprakész platformmal, stabil szoftverrel és gyors ügyfélszolgálati válaszidővel dolgozik, az jó jel a megbízhatóságra. A változatos játékkínálat is fontos: legyenek klasszikus asztali játékok, modern videó nyerőgépek és élő osztós variánsok.
A sokat emlegetett felhasználói élmény szempontjából kulcs, hogy a regisztráció gyors, a hitelesítés gördülékeny, a promóciók pedig érthetően legyenek leírva. Aki új platformot keres, könnyen talál részletes értékeléseket és útmutatókat, amelyek igazítótűként szolgálhatnak a várható szolgáltatásokhoz. A bónuszkínálat valós vonzereje nemcsak a névleges összegben, hanem az átlátható megforgatási elvárásokban rejlik. A felhasználói fiók menüje akkor működik jól, ha a fontos beállítások – limitek, dokumentumfeltöltés, értesítések – néhány kattintással elérhetők. Emellett a megbízható üzemeltetők rendszeresen kommunikálnak az újdonságokról és a szoftverfrissítésekről.
Ha részletes bemutatót, játékfrissítéseket és aktuális ajánlatokat szeretnél megismerni, érdemes felkeresni a partneroldalt; sokan itt találnak naprakész információt a regisztrációhoz, a promóciókhoz és az ügyféltámogatáshoz kapcsolódó tudnivalókról: a Wazamba népszerű kiindulópont azok számára, akik az első lépéseket tervezik az online kaszinók világában.
| Funkció | Leírás | Előny a játékosnak |
|---|---|---|
| Üdvözlő bónusz | Befizetéshez kötött ajánlat, gyakran ingyenes pörgetésekkel | Megnövelt kezdőtőke, több játék kipróbálása |
| Megforgatási követelmény | Az az összeg, amennyit tétben játszani kell a kivonás előtt | Átláthatóság és tervezhetőség a bónuszok használatában |
| Játékok választéka | Nyerőgépek, rulett, blackjack, élő osztós asztalok | Változatosság és eltérő kockázati szintek |
| Kifizetési idők | Elektronikus tárca, bankkártya és átutalás eltérő ütemezéssel | Gyors hozzáférés a nyereményekhez a megfelelő móddal |
| Mobil élmény | Reszponzív felület böngészőben, alkalmazás nélkül is | Kényelem útközben, kompromisszumok nélkül |
| Felelős játék | Limitek, önkizárás, valós idejű statisztikák | Tudatosabb pénz- és időkezelés |
A játékmenetnél nem csak a látvány, hanem a szabályok és a kifizetési táblák megértése is döntő. A magasabb visszafizetési arány (RTP) elméletileg kedvezőbb lehet a hosszú távú eredményeknél, de a volatilitás – vagyis a kockázat eloszlása – határozza meg, milyen gyakran és milyen méretű nyeremények várhatók. A jackpotok külön kategóriát képeznek: a progresszív nyereményalapból származó találatok ritkábbak, de látványosak. Az élő osztós játékok a valós idejű, stúdióból közvetített környezet miatt sokak kedvencei.
- Állíts be költségkeretet, és ragaszkodj hozzá még akkor is, ha épp nyerő szériában vagy.
- Olvasd el a bónusz feltételeit, különös tekintettel a megforgatási szorzóra és a játék-hozzájárulási arányokra.
- Próbáld ki a demó módot, hogy megértsd a mechanikákat és a bónuszkörök működését.
- Ellenőrizd a kifizetési módok díjait és átfutási idejét, hogy a nyereményeket gyorsan elérd.
- Használd a felelős játék eszközeit: limitek, időzítők és szünetek a kiegyensúlyozott élményért.
A befizetés előtti ellenőrzőlista hasznos: nézd meg a licencet, az adatvédelmi irányelveket, és azt, hogy a szolgáltató milyen stúdiókkal dolgozik együtt. Egy jó hűségprogram változatos jutalmakat, például pénzvisszatérítést és ingyenes pörgetéseket biztosíthat. A heti vagy napi promóciók – újratöltő bónuszok, élő kaszinó cashback – extra lendületet adhatnak. Ha bármi kérdésed merül fel, a több csatornás ügyféltámogatás (élő chat, e-mail) gyors segítséget jelent. A legfontosabb mégis az, hogy tudd, mikor érdemes megállni, és mindig a szórakozás legyen az elsődleges cél.
A közösségi visszajelzések alapján egyes szolgáltatók erőssége a rendezett felület és a gyors feldolgozás, másoknál a bónuszkínálat és a versenyek vonzóbbak. Van, aki a “wazamba casino” kínálatát a változatos tematikák és a gördülékeny mobilélmény miatt dicséri, míg mások egyszerűen “wazamba” néven emlegetik a márkát, és a felhasználóbarát menürendszert, a következetes kommunikációt, valamint a jól felépített hűségjutalmakat emelik ki. A tapasztalatok szerint a siker kulcsa az átláthatóság, a tisztességes feltételek és a stabil technikai háttér – ezek együtt teremtenek hosszú távon is megbízható környezetet a játékra.
Részletes útmutató egy modern magyar online kaszinó-élményhez
Magyar játékosként számomra az élmény akkor teljes, amikor a felület gyors, a szabályok világosak, és a nyeremények átláthatóan követhetők. Egy megbízható szolgáltatónál könnyű eligazodni a menükben, a játékválaszték folyamatosan frissül, és a platform nem bonyolítja túl a regisztrációt. A kezdők és a haladók egyaránt megtalálják a kedvenc asztali vagy élő játékaikat, miközben a felelős játékelemek – limitek, önkizárás, valós idejű egyenlegjelzés – ott vannak kéznél, hogy a szórakozás biztonságban maradjon.
Az online jelenlét ma már nem luxus, hanem alapkövetelmény, és a bison casino online felület ezt példás stabilitással teljesíti. A betöltési idők rövidek, a kereső gyorsan szűri a nyerőgépeket témák, volatilitás vagy szolgáltató szerint, és a demó mód lehetővé teszi, hogy kockázat nélkül ismerkedj a mechanikákkal. A játékosfiók vezérlőpultja áttekinthető, a be- és kifizetések naprakészek, a tranzakciók állapota pedig időbélyeggel és részletes jegyzetekkel követhető.
Mobilon külön előny, hogy a bison casino app reszponzív felülete egy kézzel is jól kezelhető. Az értesítések nem tolakodók, a szűrők és kedvencek funkció megjegyzi a választásaidat, és a beépített biometrikus belépés csökkenti a jelszókezelés maceráját. Mindez együtt gyors döntéseket támogat, akár egy rövid szünetben, akár egy hosszabb esti session során, miközben a fogyasztásod és időd nyomon követhető marad.
A promóciók terén a legfontosabb számomra az, hogy a feltételek tiszták legyenek. Az üdvözlő bison casino bonus esetében például előre láthatók a megforgatási szorzók, a maximális tétkorlátok és a jogosult játéktípusok. A heti újratöltések, a nyerőgép-tornák és a küldetésalapú jutalmak mind motiválnak, de csak akkor érdemes élni velük, ha illeszkednek a saját bankrollodhoz és időkeretedhez.
Ha a lehető legegyszerűbb mobilos belépést keresed, a hivatalos Bison Casino app letöltésével gyorsabban éred el a kedvenceidet, és az értesítéseket is személyre szabhatod. A telepítés pár perc, a frissítések automatikusak, és a háttérben futó optimalizációk miatt a játékok gördülékenyek maradnak gyengébb hálózati körülmények között is.
| Téma | Lényeg | Példa |
|---|---|---|
| Regisztrációs ajánlat | Gyors belépés után azonnali jutalom, átlátható feltételekkel. | bison casino free spin új játékosoknak meghatározott nyerőgépeken. |
| Hűségprogram | Szintekhez kötött jutalmak, fokozatosan bővülő előnyökkel. | Heti pörgetés-csomag és extra bison casino free spins mérföldkövekhez. |
| Játéktípusok | Részletes szűrés RTP, szórás és mechanikák alapján. | Klasszikus 3 tárcsás, megaways, cluster és jackpot slotok. |
| Fizetések | Gyors kiutalás és transzparens költségek, egyértelmű limitek. | Bankkártya, e-pénztárca, banki átutalás – valós idejű státusz. |
| Felelős játék | Önkorlátozási opciók a kontrollált szórakozásért. | Napi és heti limitek, szüneteltetés, önkizárás. |
- Regisztráció hiteles adatokkal, e-mail megerősítéssel és erős jelszóval.
- KYC ellenőrzés időben elvégezve a kifizetések felgyorsításához.
- Bankroll meghatározása: napi vagy heti keret és tétlimitek beállítása.
- Demó mód használata a funkciók és bónuszkörök megismeréséhez.
- Promóciók részvételi feltételeinek átnézése: megforgatás, tétplafon, határidő.
A stúdiókból közvetített élő asztaloknál a HD minőségű stream, a többkamerás nézet és a statisztikák segítenek jobb döntéseket hozni anélkül, hogy elveszítenéd a játék ritmusát. A krupiék udvariasak, a szabálymagyarázatok pedig tömörek. Slotoknál érdemes figyelni az RTP-re és a szórásra: magas volatilitásnál ritkább, de nagyobb nyeremények jöhetnek, míg alacsonynál gyakoribb, kisebb találatok. A próbajáték remek terep a bónuszkörök és a speciális szimbólumok megismerésére, mielőtt valódi téttel kezdenél játszani.
A pénzügyeket tekintve a legjobb stratégia a tudatos tervezés: előre határozd meg a session hosszát, a stop-loss és stop-win szinteket, és tartsd magad hozzájuk. A gyors kifizetés kulcsa a korai azonosítás és a valós adatok megadása; a feldolgozás ideje tipikusan órákban mérhető, nem napokban. Ha a promóciók között válogatsz, mindig nézd meg, mely játékok számítanak bele teljes mértékben a megforgatásba, és melyek csak részben, hogy a választásaid valóban a saját céljaidat szolgálják.
TANK OILTANK OIL
For partner access, please Explore additional resources and reviews, such as those on hipay online casino, to stay informed. log in to the portal using your credentials Alternatively, you can log in via hipay online casino for a different experience. .
What people says about Tankoil Group
InsightsLatest Articles
ContactsWe are always ready
to help you and answer
your questions
Alexandria
Merghim, North End of Ghiath Gomaa School of Str., Behind El Safa company, Amerya
Follow us
since 2001
Let's Talk
Roobet est-il adapté aux débutants ?
Des guides simples sont disponibles sur Roobet pour aider les nouveaux joueurs à comprendre les bases.
Výraz kinbet může být součástí popisu online platformy, kde se řeší přihlášení, kinbet účet, herní lobby, sloty, live casino, deposit options a základní informace o hrách.
Онлайн казино в Казахстане: обзор платформ
Казахстанский рынок гемблинга активно развивается, и выбор качественных платформ расширяется с каждым годом. Лучшие онлайн казино Казахстана предлагают поддержку тенге, удобные методы пополнения и снятия, а также бонусы, адаптированные для местных игроков. В нашем рейтинге — только проверенные операторы с лицензией и честными условиями игры.